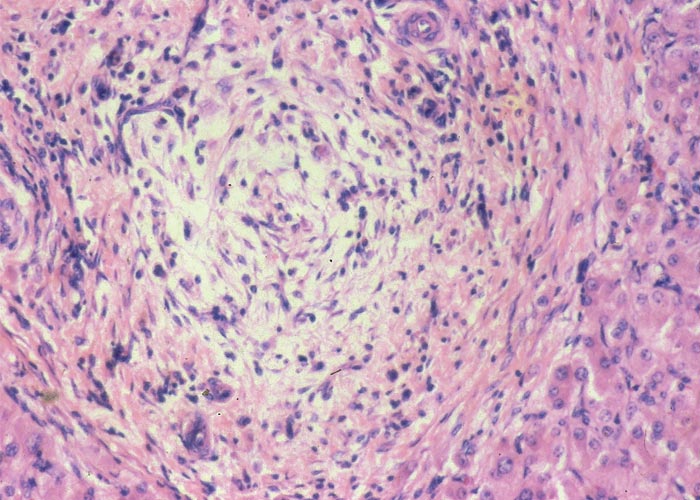
Liver
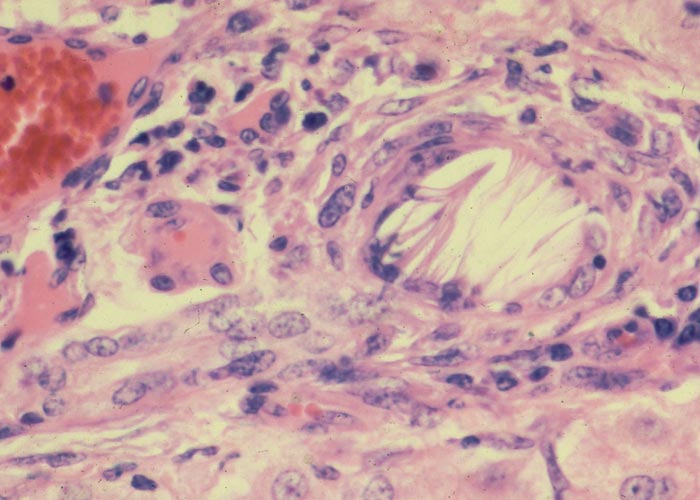
Liver

| Without Photosensitivity | Aspergillus flavus | Senecio spp. | Crotalaria spp. | Cestrum spp. | Xanthium spp. | Hertia pallens | Pteronia pallens | Galenia africana |
| With Photosensitivity | Lantana camara | Lasiospermum bipinnatum | Athanasia minuta | Athanasia trifurcata | Nidorella foetida | Cyanobacteria | Phomopsis leptostromiformis | Pithomyces chartarum | Tribulus terrestris | Panicum spp. |
This content is distributed under the following licence: Attribution-NonCommercial CC BY-NC  View Creative Commons Licence details here
View Creative Commons Licence details here

Introduction
Some of the most important diseases of livestock on the subcontinent are caused by hepatotoxic plants; for instance, geeldikkop and seneciosis are respectively rated the second and third most damaging plant poisonings in South Africa.133 Apart from photosensitivity, which distinguishes some hepatotoxic conditions, the clinical signs of most liver diseases are very similar. Owing to this similarity, some corroborative evidence – such as the presence of the incriminated plant in the paddock and the appropriate microscopical lesions in the liver – is usually necessary for a specific diagnosis to be made.
Photosensitivity in animals may be primary or secondary (hepatogenous) in origin. In the former, the photodynamic agent is absorbed from the gastrointestinal tract and reaches the peripheral circulation via the unimpaired liver. Such agents include fagopyrin in Fagopyrum esculentum and hypericin in Hypericum perforatum. In contrast to primary photosensitivity, which is rare in South Africa (see The skin and adnexa), hepatogenous photosensitivity is common and of major importance.
Hepatogenous photosensitivity of ruminants in South Africa may be induced by several hepatotoxic plants, two fungi and possibly three cyanobacteria.127, 274 Generally speaking, these syndromes can be divided into two groups, depending on whether the parenchyma or biliary system is primarily affected.In both instances the liver damage is of a type which results in the retention of phylloerythrin (Figure 1), a photodynamic porphyrin derived from the degradation of chlorophyll by micro-organisms in the gut.230, 232 Where phylloerythrin comes into contact with sunlight, for instance in the exposed unpigmented parts of the body such as the face of a Merino sheep, it reacts with rays of a certain wavelength to cause oxidative changes in the cells of the skin and adjacent tissues.47, 48, 260 The altered unsaturated lipid components of membranes, in particular those of lysosomes, result in rupture of the latter and the release of hydrolytic enzymes and/or chemical mediators of inflammation.
Photosensitivity is clinically characterized by a tendency of the animal to avoid sunlight, coupled with pruritis, erythema and swelling of the affected parts (Figure 2(a)). Eventually the skin becomes leathery or parchment-like, often immobilizing the lips or eyelids (Figure 2(b)). Since phylloerythrin, like bilirubin, is excreted in the bile, hepatogenous photosensitivity is almost invariably accompanied by some degree of icterus (Figure 2(c)). In all but the most acute cases coronitis is present (Figure 2(d)).265, 288, 315
For the pathologist, centrilobular necrosis in the livers of livestock is a common change having various causes. Such a change has been associated with the acute poisonings of many hepatotoxic plants, including Senecio spp., Crotalaria spp., Cestrum spp. and Pteronia pallens; anaemic conditions, e.g. haemonchosis, anaplasmosis, babesiosis; anoxia of the centrilobular hepatocytes as a result of heart failure, shock, disseminated intravascular coagulation; and with Rift Valley fever viral disease, particularly in cattle. Centrilobular fibrosis, on the other hand, is rare in stock, where it usually is associated with congenital or acquired chronic right heart failure. Although many indigenous plants are cardiotoxic, only sheep and goats poisoned by Galenia africana (and exceptionally in gousiekte) seem to develop hepatic lesions compatible with chronic right heart failure.
Hepatotoxic diseases in livestock can conveniently be divided into two groups: those regularly associated with photosensitivity and those in which photosensitization is rarely if ever reported. However, distinguishing the two groups of hepatotoxicoses may not be easy as, apart from photosensitization, many of the clinical signs, chemical pathological and pathological changes overlap.
Hepatotoxicoses without Photosensitivity
Aspergillus flavus Link (Fungi: Hyphomycetes)
Aflatoxicosis is an acute, subacute or chronic liver disease of humans and animals caused by aflatoxins, which are metabolites of Aspergillus flavus and A. parasiticus. This well-known mycotoxicosis has recently been ably reviewed and summarised, from a veterinary point of view, by Cheeke (1998)55 and Osweiler (1996).205
These fungi are ubiquitous, saprophytic moulds, growing on a variety of grains, feed and foodstuffs, such as groundnuts, maize, cottonseed, sorghum, sunflower seeds, rice and edible nuts.46, 76, 135, 142, 163 High humidity and high temperature during pre-harvesting, harvesting, drying, transportation and storage, as well as damage to field crops by insects, droughts and mechanical injury during harvesting, favour the growth of A. flavus and its toxin production.11, 46, 76, 102, 134, 163, 221 In addition to these predisposing factors, certain genotypes of peanuts and maize are reportedly more susceptible to infection.76
Aflatoxins are derivatives of difuranocoumarin. The four major fungal metabolites are aflatoxin B1 and B2 (AFB1 and AFB2), so designated because of their strong blue fluorescence under ultraviolet light (Figure 3), and aflatoxin G1 (Figure 4) and G2 (AFG1 and AFG2) which fluoresce a greenish-yellow.281, 329 Of these, AFB1 occurs most commonly and is also the most toxic and carcinogenic to animals and humans.76, 245 Aflatoxins are stable compounds in normal food and feed products, and are relatively resistant to heat and cooking but are degraded to a certain extent by sunlight.76, 157
According to reviewers of the hepatic metabolism and bioactivation of aflatoxins, these compounds are metabolized by the mixed function oxidase system located in the endoplasmic reticulum. AFB1 is bioactivated in the liver to a highly reactive electrophilic intermediate AFB1-epoxide, which reacts with various nucleophiles in the cell and binds covalently with DNA, RNA and protein.6, 46, 76, 239, 245, 281 A major consequence of this binding with guanine in DNA is inhibition of the signal for the formation of RNA. As a result of this and adducts formed with guanine nucleotides especially of messenger RNA, protein synthesis is interrupted leading among others (a) to deficiencies of structural proteins and (b) enzymes necessary for mobilization of fat and energy metabolism.55, 75, 167, 205 The rate of formation of the reactive intermediate, its binding to certain macromolecules, the rate of detoxification, etc. would seem to determine the toxicity, mutagenicity and carcinogenicity of aflatoxin in an animal.46, 76, 239, 281 Aflatoxin M1 (Figure 5) and M2 (metabolites formed through hydroxylation of AFB1 and AFB2, respectively), were so named because of their presence in milk.9, 76, 278 AFM1, however, is less toxic and carcinogenic than the parent compound.281 Metabolism and toxicity of aflatoxin have been shown to be influenced by many nutritional and environmental factors, especially in laboratory rodents,201, 281 while in pigs aflatoxicosis is exacerbated by a low dietary protein.74 As a result of the strong binding of AFB1 in the cell, it is often difficult or impossible to isolate.281
In the first outbreak of aflatoxicosis in animals reported in the United Kingdom, an estimated 100 000 turkey poults died (Turkey X disease) after feeding on rations containing toxic peanut meal.245 Since then a number of outbreaks, mainly in pigs, but also in cattle, horses and dogs, have occurred worldwide. In South Africa, aflatoxicosis has been diagnosed mostly in pigs126, 184 and dogs (T.W. Naudé, P. Bland van den Berg, F. Reyers and R.C. Tustin, Faculty of Veterinary Science, University of Pretoria, unpublished data, 1985; D. Miller and F. Reyers, Faculty of Veterinary Science, University of Pretoria, unpublished data, 1999). A number of domestic and laboratory animal species are, nevertheless, also susceptible to aflatoxicosis. In general, young animals are more susceptible to poisoning than older ones, and males are more susceptible than females.46, 76, 245 According to Schoental,245 there are three categories of susceptibility in animals:
- those with an LD50 of 1 mg/kg or less, which include ducklings, rainbow trout, guinea-pigs, rabbits, dogs, cats, young rats and young turkeys;
- those requiring a tenfold increase in aflatoxin dosage, such as pigs, monkeys, rats, calves, pheasants, chicks, ferrets, hamsters, cows, mink, quail;
- resistant animals such as sheep and mice.
In addition to acute and chronic liver disease in animals, aflatoxin has also been associated with decreased feed efficiency and weight loss, as well as impaired immunological response coupled with reduced resistance to infections.49, 76, 182, 183, 203, 221 Aflatoxin is among the most carcinogenic of known agents, and liver tumours, such as hepatomas (or adenomas), hepatocellular carcinomas and cholangiocarcinomas, have been reported in trout, ducklings, rats, swine, sheep and primates after prolonged exposure to low concentrations especially of AFB1.15, 16, 46, 76, 102, 163, 245, 329, 330 Apart from the danger aflatoxicosis poses to the poultry and livestock industries, these toxins are also serious public health hazards, responsible for acute and chronic liver failure46, 140, 163, 314 and Reye syndrome in humans.200, 256. Aflatoxin may occur naturally in commodities often used as human food, such as peanuts and maize and their products, as well as in different edible nuts.102, 142, 163
Residues of the toxin can occur in meat, milk and eggs of animals that consume contaminated feeds.76, 163, 238, 278 According to Rodricks and Stoloff,238 residue levels are influenced by the species or breed of animal, dosage and duration of exposure, time of feed withdrawal prior to slaughter, and age at which the animals are exposed.
Aflatoxicosis in livestock can follow either an acute or chronic course, depending on the dosage level and exposure time to the toxin.329 In pigs, the acute disease is characterized by unthriftiness, reduced appetite, weight loss (Figure 6) sometimes accompanied by a variable icterus, bloody rectal discharge, ataxia and convulsions just before the animals die.
Mortality is usually high.16, 76, 134, 221, 328 The liver is discoloured tan to yellow, and the gall bladder wall is oedematous.76 Chronic intoxication can take a clinical or subclinical course. Clinical disease is manifested by general unthriftiness, inappetence, impaired feed conversion, poor growth and icterus. As a result of the immunosuppressive effects of aflatoxin,203, 221 pigs may be especially susceptible to secondary infections.221 In South Africa, apart from one large outbreak near Upington in 1974, when more than 200 pigs died after eating flood-damaged maize containing 10 mg/kg aflatoxin, the outbreaks in pigs are usually small and sporadic. Most confirmed diagnoses involved pigs fed on mouldy groundnuts on the Springbok Flats of the Limpopo Province.
Documented outbreaks of aflatoxicosis in cattle are rare. The disease is generally not as fulminant as in pigs, but follows a subacute to chronic course after exposure to aflatoxin for several weeks or months. Clinical signs include unthriftiness, harsh coat, depression, anorexia, gradual loss of appetite and weight, low milk yield and reduced resistance to infections. Terminal signs, such as grinding of the teeth, evidence of abdominal pain, tenesmus, rectal prolapse and diarrhoea, which may be bloodstained and mucoid, have been noticed.58, 134, 152, 204, 215, 216, 221, 310 Only rarely will cattle develop photosensitization after exposure to aflatoxin.58, 152 Van Halderen and his coworkers reported the first field outbreak of bovine aflatoxicosis in South Africa in 1989.310 Seven out of 25 Friesland calves aged c.1,5–9,0 months died in the Western Cape after eating Aspergillus flavus-infested locally grown maize containing aflatoxin B1, B2, G1 and G2. Levels of up to 11 790 ng/g aflatoxin were recorded in the incriminated maize310. Unlike in the summer rainfall areas, maize in the Western Cape is harvested at a high moisture content during the winter rainy season when conditions favour growth of A. flavus and production of aflatoxin.310 The low aflatoxin content of products from the inland summer rainfall areas of southern Africa can probably be ascribed to the cool, dry winters which are not conducive to fungal growth.131
Field outbreaks of aflatoxicosis in sheep and goats are even rarer than in cattle. In one such outbreak on the Springbok Flats four pigs and supposedly two goats died of aflatoxicosis after eating groundnuts containing 65 mg/kg aflatoxin.184 The disease has been produced experimentally in both species, and the symptomatology and pathology reportedly correspond to those in cattle.15, 17, 49, 183
Following a suspected outbreak of aflatoxicosis in dogs (Figures 7 and 8) on food containing between 100 and 300 μg aflatoxin/kg, the condition was experimentally produced in dogs on food contaminated with AFB1 at levels of 500 and 250 μg/kg. At the higher level, dogs died after two months and at the lower level only at approximately six months (T.W. Naudé et al., Faculty of Veterinary Science, University of Pretoria, unpublished data, 1985).
Proliferation of bile ductules at the periphery of the lobules is regarded as the most constant finding of aflatoxin poisoning in animals.124 Microscopical and ultrastructural changes in the livers of pigs with acute aflatoxicosis were studied at different intervals after a single oral dose of 1,2 mg/kg aflatoxin.182 According to these and other workers, the acute hepatic lesions in dogs, cattle and pigs are characterized by necrosis and/or fatty changes mainly in the centrilobular area.124, 125 Similar changes have been reported periportally in ducklings, cats, turkeys, chickens and rhesus monkeys and midzonally in rabbits 124 (Figures 9 and 10). The difference in distribution of the lesions in these species has been linked to the rate at which aflatoxin is metabolized in the liver. In the rat, which metabolizes aflatoxin slowly, aflatoxin presumably acts directly on the periportal hepatocytes, whereas in animals where metabolism is rapid, the metabolite is thought to be the primary toxic agent and here the lesions are centrilobular.124
The microscopical changes in chronic aflatoxicosis in pigs and cattle are compatible with hepatic fibrosis and cirrhosis and are very similar to those reported for pyrrolizidine alkaloid poisoning (see seneciosis). In the late stage of poisoning, the lobular architecture is often distorted by intralobular fibrosis, which may be particularly prominent centrizonally, especially in cattle, giving rise to the so-called veno-occlusive lesions. Other changes include moderate to severe bile ductular proliferation, fatty metamorphosis (which is often severe in pigs and mild in cattle), karyomegaly and evidence of nodular hyperplasia.16, 58, 124, 125, 135, 182, 183, 204 Apart from the liver lesions, the epithelium of the proximal convoluted tubules in the kidneys may show mild degenerative changes, such as cloudy swelling and hydropic degeneration. Hepatic encephalopathy has been associated with aflatoxicosis in animals.49
The diagnosis of aflatoxin poisoning in livestock is often complex, and the final diagnosis will depend on the assessment of epidemiological factors that prevailed in an outbreak, the clinical signs and pathology of the affected animals, mycological analysis of the feed, chemical determinations on the feed and/or tissues by means of thin layer chromatography and fluorodensitometry,117 and the bioassay for the toxin using ducklings, chicken and trout embryos, tissue cultures, etc.163 The most effective control measure is to remove the contaminated feed. Recovery will depend on the amount of aflatoxin ingested and the duration of exposure to the toxin. Animals can be treated symptomatically.
In 1966, a meeting of the Food and Agricultural Organization of the United Nations proposed that aflatoxin at a level of 30 ng/g (ppb) be allowed in foodstuffs for human consumption.76 To reduce the danger aflatoxin poses to human health, food with significantly higher levels should be subjected to detoxification methods to bring the aflatoxin levels down to less than 30 ng/g. Once a commodity is contaminated, the most effective and economical method of reducing the aflatoxin levels is by destruction or chemical alteration of the toxin by the use of ammonia and other alkaline reagents.76, 135, 158, 302 Currently, the Food and Drug Administration of the USA allows aflatoxin at a level of 20 ng/g in maize, peanuts, and other nuts for human consumption; 20 ppb aflatoxin in animal feed; and they also recommend that contaminated maize, containing 20–100 ppb aflatoxin, could safely be used as feed for mature, non-lactating cows.76 Maize that has been treated with grain preservatives, such as benzoic or propionic acid, can only be used for animal feed.76, 264, 302
In South Africa, the legal limits for food intended for human consumption is set by the Foodstuffs, Cosmetics and Disinfectants Act (No 54 of 1972) in terms of which no person may sell food containing more than 10 μg/kg (ppb) aflatoxin, a maximum of 5 ppb of which may be AFB1. For animals, the limits are laid down by the Fertilizers, Farm Feeds, Agricultural Remedies and Stock Remedies Act (No 36 of 1947) and the maximum allowed in any feed is 50 ppb. For cows in milk, calves, pigs, lambs and poultry, the limit is 20 ppb, whereas for unweaned piglets, poultry under laying age and lambs under four months it is 10 ppb. For trout the limit is zero.
Control of aflatoxicosis involves the introduction of measures to prevent the growth of aflatoxin-producing Aspergillus spp. on pre-harvested, harvested and storage crops, as well as to curtail the growth of these fungi on prepared commodities during storage. It is thus important to eliminate or minimize conditions that are conducive to fungal growth, such as insect and mechanical damage of crops, high environmental humidity and temperature, and high moisture content of the commodities.11 Aflatoxin levels in feed and food can be reduced substantially by physical separation of the immature, broken, damaged or mouldy kernels of nuts from good-quality ones.76 Harvesting machines should be properly adjusted to prevent cracking of kernels and to remove fragments of stalks and weeds that may promote fungal growth.76 Recently emphasis has been placed on the development of aflatoxin-resistant strains of especially high-risk crops such as peanuts and maize.76
Senecio spp. (Asteraceae)
S. latifolius DC.
S. retrorsus DC.
Ragwort, staggers bush, dunsiektebossie
Seneciosis is a hepatotoxicosis of stock caused by the ingestion of Senecio spp. that contain pyrrolizidine alkaloids. It is one of the most important plant poisonings of livestock in southern Africa. In South Africa alone, about 10% of all deaths of cattle from plant poisonings/mycotoxicoses and 5% of those of small stock are attributed to this condition.133
Apart from acute intoxication in domestic ruminants and equids, it is more often responsible for chronic disease, locally known as Molteno straining disease in cattle and dunsiekte in horses. In the past, when horses were extensively used in southern Africa, seneciosis was a serious problem in this species but nowadays cattle and sheep are the animals most affected.
The toxic Senecio spp. belong to the Paucifolii group and are perennial herbs with annual stems c.600 mm tall.303
The rootstocks form shoots in early spring and in September; the erect and unbranched stems give rise to much-branched inflorescences (Figures 11, 12 and 13). The aerial parts usually die off in winter. The stems and leaves are almost hairless with characteristic small pads of woolly hair at the bases of the stems. Light-blue to greyish-green leaves without leaf-stalks are arranged alternately, with the leaf-bases folding around the stem. Short prickly teeth occur on the leaf-margins at about 3 mm intervals (Figure 14). Small flowerheads with two to five yellow ray florets (typical daisy with outer petals) are formed on the terminal branches of the inflorescences (Figure 12). Each seed has a hairy crown (pappus).303
Approximately 250 Senecio spp. have been identified in South Africa, the majority of which are not known to be toxic to livestock.303 Of the poisonous species, S. retrorsus (mainly in the Eastern Cape Province) and S. latifolius (mainly in Mpumalanga and KwaZulu-Natal and in the eastern regions of Zimbabwe) regularly cause problems (Figures 15 and 16). Other less important toxic species include S. isatideus, S. burchellii303 and S. harveianus (T.S. Kellerman, VRI, Onderstepoort, unpublished data, 1986). Senecio spp. are known to hybridize in the field, are morphologically very variable, and are often difficult to classify at species level. In general, all Senecio spp. must be regarded as a potential cause of pyrrolizidine alkaloid intoxication if eaten, but in recent decades only the Paucifolii group has been of practical significance in southern Africa.
Generally, the toxic Senecio spp. are mostly found in the central and eastern parts of South Africa. They often inhabit open veld on mountain slopes and marshy areas and, with their deep strong root system, are invasive and become particularly numerous where the veld has been denuded of grass as a result of bad farming practices and/or droughts. Under such conditions, livestock is forced to eat these somewhat unpalatable herbs. Outbreaks of acute poisoning often occur after veld fires have destroyed the vegetation and the animals are exposed to the more palatable young shoots of the plants. Some annual Senecio spp. can be weeds on cultivated lands. Plants in the pre-flowering stage are very toxic and desiccation and silage fermentation have little effect on their toxicity.136, 269
Pyrrolizidine alkaloids are the toxic principles of several species of plants throughout the world, including the genera Senecio, Heliotropium, Amsinckia, Echium, Crotalaria, Symphytum, Trichodesma and others.6, 36, 111, 136, 170 Apart from the toxic hazards these alkaloids pose to livestock, human exposure as a result of contamination of wheat (locally known as bread poisoning), 60, 153, 194 , 268, 325 milk, 71, 111 honey,72 herbal teas118 and other foodstuffs186, 283 has also been reported. Besides the acute and chronic toxic effects these alkaloids may have on animals and humans, some have been shown to be carcinogenic to rats.70, 101, 111, 153, 171, 246 The chronic effects and especially the pathology caused by retrorsine have been thoroughly studied in vervet monkeys.309 McLean153 reviewed the literature on pyrrolizidine alkaloids and found experimental evidence to show that, particularly in rats but also in cattle, the alkaloids or their proximate toxins can cross the placenta or be excreted in the milk to affect the foetus and the new-born.
The alkaloids retrorsine (Figure 17), sceleratine and isatidine have been isolated from the three Senecio spp. most commonly associated with poisoning of livestock in South Africa.159, 318, 319
Pyrrolizidine alkaloids are chemically stable compounds, bioactivated in the liver by the cytochrome P-450 dependent mixed function oxidase (MFO) system to reactive pyrrolic alcohols and esters (dihydropyrrolizidines), which are more toxic than the parent compounds.36, 60, 70, 111, 153, 171, 172, 281
It has been shown that all the toxic and carcinogenic pyrrolizidine alkaloids are ester derivatives of 1-hydroxymethyl-1,2-dihydropyrrolizidines with esterification being possible at positions C-1 and C-7. Highly toxic alkaloids are somewhat lipophilic, di- rather than mono-esters, containing a double bond between C-1 and C-2 in the pyrrolizidine ring system, and carrying esterified hydroxyl groups with at least one containing a branched carbon chain.172, 281
The branching impedes hydrolysis of the ester group, thereby promoting pyrrole production. Cyclic diesters reputedly are more toxic than noncyclic diesters for the same reason.55 The pyrroles (Figure 18) (especially the pyrrolic esters) that are formed in the liver are highly electrophilic or alkylating intermediates that can react with nucleophiles and macromolecules, such as nucleic acid or protein in the cell, to become covalently bound, causing necrosis, chemical lesions, inhibiting mitosis and thereby causing megalocytosis.70, 111, 153, 170, 172, 281 High levels of pyrroles have been demonstrated in the livers of susceptible species, such as rats, while only low levels were found in species that are more resistant to pyrrolizidine alkaloid poisoning.70, 111, 281 The toxicity of the different pyrrolizidine alkaloids to stock is thought to be affected by the proportion of the alkaloid which is converted to pyrroles, the rate of conversions to pyrroles, the chemical reactivity of the pyrroles170, 171 and the ability of the body to detoxify the pyrroles.55 Species differences in the bioactivation and detoxification of pyrrolizidine alkaloids are discussed by Cheeke and Huan.54 Pyrrolizidine alkaloids may be excreted, for example, directly or conjugated with glutathione in the urine; as their acid or amino alcohol products (after hydrolysis of the ester groups by esterases); and as highly water-soluble N-oxides (after exposure to flavin-containing monooxygenases).55 Sheep are believed to be relatively resistant to pyrrolizidine alkaloid poisoning because of the low rates of pyrrolic production in that species, high activity of detoxifying enzymes and efficient glutathione conjugation.55 Some workers believe that resistance to pyrrolizidine alkaloid poisoning is primarily hepatic53, 55 rather than ruminal in origin, while others hold the alternative view.22 The structure and chemical properties of the active metabolites have a bearing on the location and type of damage caused in the body.172
The pyrrolizidine alkaloid content of Senecio plants has been shown to vary from one season to another, according to growth stage and location of the plant, and may also be influenced by meteorological conditions.123 The flowers of most of the toxic Senecio spp. contain more alkaloids than the leaves and the stem.123 Poisoning of livestock can either be acute or chronic, depending on the toxicity and amount of Senecio plants ingested and the duration of exposure to the plants. Acute poisoning is manifested if animals ingest large quantities over a short period and they may die within a few days. Chronic disease, on the other hand, will develop in animals exposed to a large single dose or multiple smaller doses of the plant over a prolonged period.
Horses seem to be most vulnerable to Senecio poisoning, followed by cattle, sheep and goats, in that order.111, 136, 269 Robertson237 was the first to show that S. latifolius is poisonous to horses in South Africa, while Chase44 and Robertson237 found that S. burchellii and S. latifolius caused Molteno straining disease in cattle. Although acute poisoning is not uncommon, most field cases of Senecio poisoning in animals are of the subacute to chronic type.
Chronic seneciosis (dunsiekte or stomach staggers) has been well documented in horses (Figure 19).63, 99, 105, 111, 237, 249, 286, 287 According to the various authors, one of the first signs of poisoning in the horse is yawning, coupled with unthriftiness, roughened coat and weight loss. Affected animals tend to stand by themselves with their heads hanging low, and they appear sleepy. A stabled horse will often support its head against the wall in the corner of the box or on the manger. When it moves, the animal seems to follow close to the walls in an effort to support itself. Later in the course of the disease, the horse walks aimlessly and with an uncertain gait, brushing and bumping against obstacles, causing abrasions and wounds of the skin particularly over the bony prominences such as the shoulder, hips, hocks, shins, etc. As the disease progresses, the gait of the animal becomes more and more affected and the animal sometimes loses its equilibrium. When the animal walks, it does not lift its hind legs properly and drags its hooves slightly over the ground. The horse flounders about, frequently becoming entangled in fences, landing in dongas, etc. During the late stage of the disease, the animal staggers about like a drunken man, placing its legs abnormally and persisting in that position for long periods. It becomes docile and appears to be semi-comatose, a condition often referred to as sleepy staggers. In this state, the horse may stand, sometimes with food hanging from its mouth. Some horses show a depraved appetite and will eat their bedding in preference to the food in the manger. There may also be signs of abdominal pain, and some horses show a diarrhoea.
Colic may be so pronounced that the animal dies during an attack of pain. Loss of condition is progressive. Icterus and sometimes also small haemorrhages may be evident on the conjunctiva, and occasionally the supra-orbital fossae are swollen, as occurs in horse sickness. The urine is often dark brown as a result of the presence of bilirubin. A peculiar, sweetish, unpleasant odour has occasionally been reported to emanate from the skin.136 The animal may die in this state or may become frenzied, a condition referred to as violent staggers, injuring itself, until it drops into a coma and dies. Generally speaking, the disease has a slow course, but occasionally animals may behave atypically and die acutely without any premonitory signs of chronic liver involvement, apart from loss in condition.
During his investigations of dunsiekte, Theiler286 found that horses may die of chronic seneciosis 20–96 days after feeding with the plant has been discontinued. He also showed that severe liver fibrosis or cirrhosis developed in some cases even when the animal had been exposed only once or for a very short period to low levels of toxic Senecio plants. Verney317 reported mortality in a horse as a result of dunsiekte two years after the animal had been removed from Senecio veld. Kingsbury136 reported a latent period of six months in horses and cattle during which the animals may even gain weight before the appearance of signs. It is evident, therefore, that animals may pick up the intoxication in one locality and develop fatal signs in another non-infested locality some time afterwards. The mechanisms by which chronic poisoning can take place are discussed by Seawright.255
In acute Senecio poisoning, cattle may die suddenly within the first few days after exposure to relatively large quantities of the plant. Acute poisoning infrequently occurs in adult cattle and is more often seen in weaners or young animals that have been newly introduced into infested camps (C.P. Harte, Private Veterinarian, Queenstown, personal communication, 1985). Clinical signs include loss of appetite, signs of abdominal pain and sometimes diarrhoea. In chronic seneciosis, the signs commence earlier and the course of the disease is usually shorter than in horses.105 Molteno straining disease or chronic seneciosis is characterized by a staring coat, sometimes accompanied by diarrhoea, severe tenesmus and eversion of the rectum.85, 105, 153, 249, 269 The tenesmus increases in frequency and becomes more intense as the disease progresses. The faeces are frequently mixed with blood, are black in colour and have an offensive smell. Scouring persists for several days. Progressive emaciation, unthriftiness and dehydration are outstanding signs in some animals, while in others frenzy, aggression, ataxia, apparent blindness, muscle tremors, bellowing, grinding of the teeth and drowsiness are more prominent before the animals die.105, 153, 249, 269
In chronic seneciosis, the nervous signs develop in response to hepatic encephalopathy, while tenesmus is thought to be either the result of oedema of the large intestines and rectum, or neurogenic in origin. Recently, spongy degeneration (status spongiosus) similar to the condition reported in chronic seneciosis85, 109, 110 was induced in calves after they had been infused with ammonium acetate.45 A couple of days after the infusion, the calves developed tenesmus, an indication that straining might well also be the result of a central lesion.
Acute and chronic poisoning of sheep occurs regularly in South Africa and is of major economic importance in areas where the plant grows abundantly, e.g. in the Queenstown district of the Eastern Cape Province. In the same way as cattle, sheep (particularly season lambs) may be affected acutely and die without specific clinical signs one to four days after consuming large amounts of the plant, especially in the two-leaf stage when it is palatable to sheep and also most toxic. Considerable numbers of lambs can die within 24 hours after being introduced into a toxic camp (C.P. Harte, Private Veterinarian, Queenstown, personal communication, 1985). Outbreaks usually occur in heavily infested camps which have been denuded of grass as a result of droughts, overgrazing or fires. Chronically affected sheep show emaciation, weakness, listlessness and sometimes also evidence of ascites. Although microscopical brain lesions compatible with hepatic encephalopathy are frequently found in sheep with severe fibrosis of the liver or cirrhosis, clinical signs of central nervous system involvement are almost never apparent. According to some overseas reports,70, 125, 136 sheep are highly resistant to pyrrolizidine alkaloids and can be successfully pastured even in camps heavily infested with S. jacobaea (tansy ragwort).
Lesions induced by pyrrolizidine alkaloids are very similar in the different animal species and humans. The alkaloids in Senecio spp. in southern Africa affect primarily the liver, whereas some Senecio spp. and other pyrrolizidine alkaloid-containing plants worldwide may also have an effect on the lungs and kidneys in certain species.105, 111, 153, 170, 172, 269, 309 The brain and gastrointestinal tract are often indirectly affected following hepatic damage. According to Mattocks,172 the sites of action of the primary toxic metabolites depend on their stability, e.g. pyrrolic esters formed in the liver may be acutely toxic to the liver, but too unstable to reach other organs, whereas a more stable ester may damage the tissues, such as the lungs.
Macroscopical lesions of acute Senecio poisoning in ruminants include mild to moderate icterus, subcutaneous, serosal and visceral petechial and ecchymotic haemorrhages, slight to moderate effusion of the body cavities and oedema of lungs and abomasal folds. Enterorrhagia may also be evident in some cases. The most notable and most significant changes are found in the liver, which is as a rule moderately to markedly enlarged, and the parenchyma has a turgid to somewhat brittle consistency. The lobulation is accentuated, giving the organ a mosaic appearance, and the colour of the liver ranges from dark red to almost bluish-red in some animals, to an orange-brown in others (Figures 20 and 21). The organ is often severely engorged and copious amounts of blood ooze from the parenchyma on cut surface. In most cases, the wall of the gall bladder is oedematous and may also contain haemorrhages (Figures 20). Occasionally, the bile is blood-tinged. The hepatic lymph node may be swollen, and oedema may be evident about the hilus of the liver.
Hepatic fibrosis or cirrhosis are features of chronic seneciosis. The liver is usually smaller than normal, greyish-brown in colour, has an increased consistency, and an irregular surface. A few to numerous hyperplastic nodules, which are greyish-brown in colour and vary in size between 1–5 mm in diameter, are scattered throughout the parenchyma (Figure 22). In ruminants, the gall bladder wall, hepatic lymph node and loose connective tissue about the hilus are oedematous. The majority of the pathological changes in sheep and cattle are compatible with chronic liver failure and include icterus, ascites (up to 8 L), hydrothorax, hydropericardium, oedema of the abomasal folds and mesentery, as well as the small and large intestines. In cattle, perirectal oedema may be particularly severe. Splenomegaly has been reported in some animals and the urine often has a coffee colour. In horses the stomach is dilated and filled with food, and the caecum and colon are oedematous.
Microscopical lesions are present in the livers of all species which succumbed to acute Senecio poisoning. The parenchymal changes are characterized by centrilobular coagulative to lytic necrosis, accompanied by haemorrhage or blood pooling in these areas (Figure 23). The necrosis sometimes extends into the midzonal parts and bridges contiguous lobules. In some livers, increased numbers of neutrophils, Kupffer cells and fibroblasts occur among the necrotic hepatocytes. Even in the acute stage of the hepatic lesions, a sparse meshwork of fibroblasts may be evident in the centrilobular blood lakes in some lobules. The hepatocytes not affected by necrosis reveal cloudy swelling, hydropic degeneration and mild fatty metamorphosis. Apart from the parenchymal changes, the portal triads are mildly oedematous. The epithelial cells in the proximal convoluted tubules in the kidneys also show cloudy swelling and hydropic degeneration.

Figure 20 Acute ovine seneciosis: note congested liver with distinct lobulation and haemorrhagic gall bladder wall
In chronic seneciosis, hepatic fibrosis or cirrhosis occur in all species, and the degree of architectural disturbance in the liver is largely dependent on the chronicity of the disease. Although the effects of pyrrolizidine alkaloids in Senecio poisoning primarily have hepatocytes as their target, the portal triads are always affected by moderate to severe bile ductular proliferation and fibroplasia (Figure 24). Many of these cholangioles are visible among the periportal hepatocytes and may even extend deeper into the lobule. The connective tissue that radiates from the triads or that is formed in the lobules, intersects hepatic cords and sinusoids to form small nests or islands of affected liver cells. Fibrosis may be prominent around some sublobular and central veins (Figure 25). These vascular changes are referred to as veno-occlusive lesions, and their incidence would seem to be determined by specific alkaloids, dosage level and time of exposure to the toxin.153 The perivascular fibrotic changes are often associated with duplication of the central veins. The pathogenesis of the occluding lesions is not clear, but it is thought that the endothelial cells of these vessels may undergo metaplasia with the formation of cells possessing fibroblastic properties.111, 153, 309 Characteristic features of pyrrolizidine alkaloid poisoning are megalocytosis and karyomegaly of hepatocytes (Figure 26), which have been attributed to the residual progressive effect of the antimitotic action of alkaloids and the stimulus for regeneration.111, 153 There is evidence that megalocytes can enter mitosis, but are unable to complete it, with the result that many abnormal mitoses may be present.153 Megalocytes have 10–30 times the volume of normal cells and can purportedly survive for many months.111, 125, 153 The very much enlarged vesicular reni-shaped to lobed nuclei are often hyperchromatic. Part of the cytoplasm is sometimes invaginated by the bizarre-shaped nuclei, giving rise to eosinophilic, apparently intranuclear inclusions (pseudoinclusions) of varying size. The Kupffer cells are often activated and show nuclear alterations similar to those of the hepatocytes. The cytoplasm of both the hepatocytes and Kupffer cells may contain a yellowish-brown, lipofuscinous pigment. During the late stage of poisoning, isolated hyperplastic nodules (Figure 27) occupy part of some lobules or can be a few millimetres in size and can be so numerous that they either obliterate or compress the pre-existing, affected parenchyma into surrounding pseudocapsules. The nodules are characterized by hepatic cords two to four cell layers thick; the hepatocytes are usually smaller than normal size, and are affected by mild to severe fatty metamorphosis and occasionally, also by necrosis and haemorrhage; the liver cells do not show changes compatible with pyrrolizidine alkaloid poisoning and there is, as a rule, no or at least minimal fibrosis in these nodules. In livers that are markedly indurated, the Glisson’s capsule is often thickened by fibrosis and oedema, and the lymphatics are dilated and filled with an oedematous fluid.
Chronic seneciosis has been associated with hepatic encephalopathy in animals85, 109–111, 125 (J.A.W. Coetzer, VRI, Onderstepoort, unpublished data, 1984). Spongy degeneration of the white matter, often referred to as a status spongiosus, occurs frequently in the brain and spinal cord of livestock with hepatic fibrosis or cirrhosis. A meshwork of big, empty spaces is found in the white matter, particularly in the midbrain, brain stem, cerebellar peduncles and at the junction of the white and grey matter in the cerebrum. Ultrastructural studies on the brains of calves which developed similar lesions after infusion of ammonium acetate showed that there was extensive vacuolation and separation of the myelin spiral at the intraperiod lamellae.45 The spongy changes would therefore seem not to form in response to the direct effect of the pyrrolizidine alkaloids, but to develop indirectly as a result of hyperammonaemia arising from chronic liver failure. As in urea poisoning, the ammonia is believed to react with α-ketoglutaric acid to form glutamine. Being an intermediate in the citric acid cycle, depletion of α-ketoglutaric acid (by glutamine-formation) will inhibit that cycle, leading to an insufficiency of ATP.55 Furthermore, it is interesting to note that although the spongy changes in the brains of sheep are often exceptionally severe, they are almost never associated with overt signs of central nervous system dysfunction (J.A.W. Coetzer, VRI, personal observation, 1987).
Chronic seneciosis is an insidious disease, making early diagnosis and control difficult. When the toxicosis is recognized clinically, the disease has reached an irreversible state and death is inevitable. Australian workers have investigated the enhanced destruction of alkaloids in the rumen, reducing the metabolic activation of the alkaloids and immunization to protect sheep against heliotrope poisoning without much success.60 Although pyrrolizidine alkaloid metabolism can be altered by dietary and nutritional factors in laboratory rodents,281 mineral/vitamin supplements have been shown to have no real effect on S. jacobaea poisoning in cattle in the USA.122 Poisoning is thus best controlled by proper veld management and sound farming practices. In South Africa, naive cattle are believed to be more prone to seneciosis than those reared on infested veld. This indicates that stock develop conditioned aversion to the plant (L.D. Snyman, T.S. Kellerman and R.A. Schultz, Onderstepoort Veterinary Institute, personal communication, 1993).
In the USA the herbicide 2,4-D and biological control by the larvae of the cinnabar moth (Tyria jacobaeae) and the flea beetle (Longitarsus jacobaea) have been used to control tansy ragwort (S. jacobaea).
In Australia, chronic copper poisoning in sheep has been associated with the consumption of pyrrolizidine alkaloid-containing plants, such as Heliotropium and Echium spp. It is suggested that the alkaloids form complexes with copper and upset the storage mechanism which in turn leads to a build-up of copper in the liver.6, 111 Several Heliotropium and Echium spp. occur in South Africa, but have not been implicated in stock losses.
The microscopical hepatic lesions of acute seneciosis are identical to those regularly reported in the acute poisonings with plants, such as Crotalaria spp., Cestrum spp. and Pteronia pallens. Centrilobular hepatic necrosis can also occur in Athanasia minuta (= Asaemia axillaris), A. trifurcata, Hertia pallens and Microcystis aeruginosa poisonings, as well as in acute aflatoxicosis. The liver lesions and the widespread haemorrhages which are often seen in acute Senecio poisoning have been confused with similar changes reported in Rift Valley fever in the past, particularly in cattle.50 Finally, it should be pointed out that the hepatic alterations of chronic seneciosis closely resemble the hepatic changes seen in chronic aflatoxicosis.125
Crotalaria spp. (Fabaceae)
C. spartioides DC.
Dune bush, duinebos, besembos
C. dura Wood and Evans
Wild lucerne, wilde lusern, jaagsiektebossie
C. globifera E. Mey.
Wild lucerne, wilde lusern, jaagsiektebossie
C. juncea L.
Sunn-hemp, sunn-hennep
C. burkeana Benth.
Rattle bush, stywesiektebossie
Information on most of the syndromes in livestock caused by Crotalaria spp. in southern Africa is scant and what there is dates back nearly to the turn of the century. Depending on the animal and plant species involved, the liver, lungs (see Respiratory system) and/or the hooves (see The skin and adnexa) may be the parts primarily affected. Pyrrolizidine alkaloids have been isolated from this genus and it seems likely that they are the cause of at least the liver and lung damage encountered.
Of all the locally known Crotalaria spp., the dune bush or C. spartioides appears to be most hepatotoxic and occasionally in the past has been associated with liver failure in cattle, especially in the Kuruman district of the Northern Cape Province. Crotalaria spartioides is a dense, much-branched and almost leafless shrub growing c.1,5 m high (Figure 28). The simple, very narrow, deciduous leaves have leaf-stalks less than 1 mm long. The solitary, bright yellow, typical pea flowers (Figure 29), which are marked with fine dark lines, are borne from October to the end of May. They are followed by short, stout, swollen pods (Figure 29) which are c.10 mm long and 5 mm broad, containing five to six flat kidney-shaped seeds. The plant can be confused easily with other similar species such as C. virgultalis and C. orientalis, the toxicity of which is not known.303 Crotalaria spartioides is found in deep sand on dunes in the Kalahari (Figure 30), as well as occasionally on old lands and over-grazed areas. As the mature plant is rather unpalatable, poisoning in cattle usually occurs when the grazing is sparse.
Very little is known about the toxicity of C. spartioides. In horses, it is well known that certain of our local Crotalaria spp. are responsible for lung pathology (see Respiratory system), but similar changes have not been reported previously in cattle.105, 269 During 1969, a drought forced a farmer in the Kuruman district to supplement the diet of c.40 cows with the dune bush. Nineteen of the cows died as a result of fibrosis or cirrhosis of the liver. Plants collected in the same area were dosed to a one-year-old ox at the Onderstepoort Veterinary Institute.
The animal received 39 kg of plant material over a two-month period and died seven months after the initial dosage, showing typical lesions of Crotalaria poisoning (T.F. Adelaar and J.D. Smit, VRI, Onderstepoort, unpublished data, 1974). Later, a five-month-old heifer was dosed with C. spartioides at 5 g/kg body weight over several months (T.W. Naudé and J.D. Smit, OVI, unpublished data, 1986). The animal was examined daily, but no clinical abnormalities were detected during the course of the experiment. Eventually, c.11 months after the last administration of the plant material, the animal was slaughtered. The liver was cirrhotic and showed evidence of nodular hyperplasia. Formalin-fixed lung tissue from this animal, as well as a sample from a bovine that died of C. spartioides in the Kuruman district were re-examined (J.A.W. Coetzer, OVI, unpublished data, 1986). In both cases, the lungs and liver were affected. The liver showed changes typical of chronic pyrrolizidine alkaloid poisoning. The microscopical lesions in the lungs composed of a mild to moderate interstitial pneumonia and emphysema, characterized by thickening of the alveolar septae by what appears to be fibroblasts, macrophages, lymphocytes and connective tissue; hyperplasia of especially the smaller bronchioles; hypertrophy of the walls of smaller arteries and arterioles and karyomegaly of some of the alveolar epithelial cells. It is assumed that the toxic principle of C. spartioides is a pyrrolizidine alkaloid based on the corresponding changes in the livers of animals that have succumbed to this poisoning.
Crotalaria dura, C. globifera and C. juncea have primarily been associated with a lung condition in horses known locally as jaagsiekte.105, 160, 267, 269, 270, 277, 289, 303 However, these plant species have been shown in some instances to be responsible for liver damage in horses, cattle and sheep.105, 269, 275, 289 A bull and an ox that received a daily dose of c.1 kg of C. dura over a period of 64 days (total amount of c.58 kg of plants) and 96 days (total amount of c.89 kg of plants), respectively, developed cirrhosis, but no lung lesions.289 The hepatic changes that sometimes accompanied the lung lesions in cases of jaagsiekte, and are also reported with C. dura poisoning in cattle, are compatible with pyrrolizidine alkaloid poisoning (see seneciosis). Steyn and De Kock275 dosed dried C. dura plants in the late seeding stage daily to sheep at a level of 100 to 400 g for 10 to 135 days.
They found that, apart from respiratory distress and lung lesions very similar to those described in jaagsiekte in horses,289 some of the sheep also showed evidence of hepatic involvement, such as icterus, oedema of the gall bladder wall, hepatocellular fatty changes and what the authors described as a slight cirrhosis in a few cases. Staggers, accompanied by hepatic involvement, and icterus have also been reported by Theiler in a horse that received a total amount of 15 kg of dried C. burkeana105 over a period of 17 days. The laminitic syndrome caused by this plant in cattle is known as stywesiekte or stiff-sickness and is discussed in The skin and adnexa.
Crotalaria sphaerocarpa, growing on lands, commonly contaminates grain but does not pose a threat for stock.
Cestrum spp. (Solanaceae)
C. aurantiacum Lindl.
C. laevigatum Schlechtd.
Ink-berry, inkbessie
C. parqui L’Herit.
Cestrum spp. are sporadically responsible for hepatotoxicoses principally of cattle in southern Africa269, 291, 303 (J.A.W. Coetzer and T.S. Kellerman, OVI, unpublished data, 1985).
Of the Cestrum spp., C. laevigatum (Figure 31) seems to occur most widely in the subcontinent. It is a much-branched shrub or tree, growing 6–15 m high in coastal regions, but inland, in areas like the Free State and the Mpumalanga (Figure 32) provinces of South Africa, it usually attains a height of 1–2 m.291, 303 The dark to light-green elliptical leaves aggregate chiefly towards the ends of branches and are easily bruised, emitting an unpleasant pungent odour. The small, sessile, greenish-yellow, tubular, sweet-scented flowers, 5–25 mm long, are borne in clusters mostly at the tips of branches (Figure 31). Later, greenish berries (10 mm long and 5 mm in diameter) develop turning deep purple-black as they ripen. The plant usually bears its flowers and berries during June and July, the winter months.291 The botanical characteristics of C. parqui144 are very similar to those of C. laevigatum,291, 303 but the former has green flowers.
The Cestrum spp. are native to South America and were introduced into southern Africa as evergreen ornamental shrubs, hedges and sometimes as windbreaks. In South Africa, cultivated Cestrum spp. in gardens sometimes spread and hybridize with C. laevigatum.303 The ink-berry has escaped from gardens and grows wild, particularly in the coastal region of KwaZulu-Natal and the Eastern Cape Province. It is especially abundant on slopes and in gulleys in the Chase Valley near Pietermaritzburg, where outbreaks of poisoning in cattle occur every now and then.291 Cestrum laevigatum can also be found along the Vaal River near Parys and has spread very rapidly in South Africa.303 All three species mentioned are proclaimed weeds. According to Shone and Drummond257 Cestrum aurantiacum has become naturalized in the Umtari and Penhalonga areas of Zimbabwe. This species has orange flowers and white berries.
In recent years, C. laevigatum, C. parqui and C. aurantiacum have been incriminated as the cause of poisoning in cattle in South Africa, Zimbabwe, Kenya and the island of St Helena193, 257 (J.A.W. Coetzer and T.S. Kellerman, VRI, Onderstepoort, unpublished data, 1985).
Steyn269 referred to statements by Chase (1903), Hutcheon (1903) and Walsh (1909) that C. nocturnum is poisonous to cattle in South Africa. However, according to Steyn,269 the plant was wrongly identified and these poisonings should have been attributed to C. laevigatum. Thorburn291 was the first to establish that C. laevigatum poisoning was the cause of Chase Valley disease which occurred for many years in the Chase Valley near Pietermaritzburg. He reproduced typical clinical signs and lesions in 12 cattle that had received a mixture of green berries and leaves, supplemented with hay. One of Thorburn’s experimental animals, a 15-month-old calf, was fed c.0,5 kg of this mixture every alternate day, a total of c.5 kg plant material, and died 13 days after the commencement of the experiment. The same plant material was dosed to different species and found to be highly toxic to sheep and a goat, but harmless to a horse, a pig, a rabbit, guinea-pigs and fowls.291 This is surprising, as poisoning with C. parqui – which supposedly have similar toxins – has been reported in horses, pigs and fowls in Australia.144 More recently, Van der Lugt and co-workers dosed dried, milled C. laevigatum to cattle and sheep at, respectively, 0,5–10 g/kg/day for 1–38 days304 and 2,5–10 g/kg/day for 1–47 days.305 A single dose of 10 g/kg was lethal for both species.
Mugera and Nderito investigated the toxicity of C. aurantiacum to livestock in Kenya.193 The leaves and tips of young shoots of the plant were collected, dried and milled to a fine powder and drenched daily at different dosage levels to 15 bull calves with masses ranging from 159 kg to 181 kg, and to 10 goats. A group of five calves, each drenched daily with 100 g of Cestrum leaf powder, died within three days after receiving 200 g of the powder. The five calves, given a daily dose of 50 g of Cestrum leaf powder, died on the fifth day of the experiment, while two of the five calves drenched with 30 g/day of the material survived for ten days. A group of ten goats and another group of five goats drenched daily with 20 g and 15 g of the powder, respectively, all died between the seventh and twenty-first days of the experiment.
The leaves of young shoots and the green berries of C. laevigatum have been shown to be most toxic, hence the occurrence of poisoning in June to July.291 Clipped hedges are most likely to cause problems because they produce vigorous young shoots. These shoots are equally toxic whether in the green stage or cut and dried.193, 291 On the other hand, material collected from C. laevigatum that had already formed ripe black berries proved harmless when fed to cattle.291 Depending on the growth stage of the plant, the toxicity of Cestrum spp. to livestock may vary greatly.73, 257, 269, 291
The search for the toxic principles of C. laevigatum dates from about the early thirties. According to Steyn,269 Wehmer extracted a saponin and a substance he called cestrumid. Canham and Warren41 reported the extraction in alcohol of saponins from C. laevigatum and isolated two substances, gitogenin and digitogenin. They claimed to have produced the typical disease by administrating these isolated substances, but no details were given. The same workers also claimed to have isolated gitogenin and digitogenin from C. parqui.42
The toxic principles of Cestrum parqui have now been identified as the kaurene glycosides, parquin and carboxyparquin202 (Figure 33), structurally closely related to atractyloside and carboxyatractyloside. However, the parquins differ from carboxyatractyloside (the major toxin in Xanthium strumarium56) and atractyloside in having a different pyranose ring and an additional γ-lactone.202
In southern Africa, field outbreaks of Cestrum poisoning have been reported only in cattle, while in Kenya mortalities in goats and cattle have been associated with C. aurantiacum. Cattle graze less selectively than other species and will eat the plant readily, especially during droughts, notwithstanding the offensive smell of the crushed leaves.
With the exception of C. diurnum, which contains the toxic principle dihydroxy-Vitamin D3 glycoside and is the cause of calcinosis in cattle in North America,116 the other toxic members of the genus Cestrum produce similar clinical signs and lesions.73, 144, 193, 257, 269, 291, 304, 305 The principal clinical signs include salivation, lacrimation, sunken and staring eyes, arched back, signs of abdominal pain (restlessness, grinding of the teeth, groaning, kicking at abdomen, etc.), weakness, muscle tremors, staggering gait, incoordination, aggression, constipation, frequent urination and icterus. The course is often rapid, and some animals are found dead.
The most significant macroscopical lesions are found in the liver, which is as a rule enlarged and friable, orange-brown in colour (Figure 34), with congested patches scattered throughout the parenchyma. The gall bladder wall is often oedematous and may contain haemorrhages. Apart from the hepatic lesions, other less specific changes include cyanosis, oedema of the lungs, effusion of the body cavities, enterorrhagia, congestion and oedema of the abomasum folds, petechiae and ecchymoses on serosal surfaces, as well as subcutaneously, intermuscularly and in the epi- and endocardium. In many cases, the rectum contains dry faecal balls covered with a bloody mucus. Congestion of the meninges and brain, spongy changes in the cerebral white matter, and icterus have also been reported. Microscopically, the lesions in the liver are characterized by centrilobular necrosis and haemorrhage (Figure 35), sometimes accompanied by infiltration of neutrophils in the necrotic areas and mild bile ductular proliferation. Ultrastructural hepatic changes304, 305 of experimentally intoxicated cattle and sheep include degeneration and necrosis of hepatocytes and occasionally endothelial cells, and disruption of sinusoidal walls.
Poisoning can best be prevented by keeping stock away from areas where the plant grows, especially during the months of June and July when it is most toxic.
Xanthium spp. (Asteraceae)
X. strumarium L. (= X. pungens Wallr.)
Cocklebur, kankerroos
X. spinosum L.
Spiny cocklebur, boetebossie
Xanthium poisoning of livestock is a relatively rare occurrence throughout the world, pigs being more often affected than other susceptible species, such as cattle and sheep.124 The injury to the liver and to a lesser extent to the myocardium and kidneys has been described in poisoned animals.124 It should be noted that, like Cestrum parqui, the toxic principles of Xanthium strumarium are kaurene glycosides.
Xanthium spp. are cosmopolitan, annual weeds that have become noxious in Australia, certain parts of the USA, and southern Africa.56, 104 Cocklebur prefers to grow on disturbed soil, such as next to roads and reaped lands, and also along streams.104 Xanthium strumarium grows up to 1,2 m high, has large, broadly ovate-cordate leaves and bears numerous brownish burs c.20 mm long which are covered with spines (Figure 36).104
Initially, the poisonous effect of the plant was attributed to the mechanical action of the burs, and then to hydroquinone present in the kernels and burs.56 More recently, Cole et al.56 were unable to detect hydroquinone in X. strumarium, but identified the toxin by spectroscopy to be carboxyatractyloside.
The toxic principle, carboxyatractyloside (Figure 37), is primarily located in the cotyledons of the plant and diminishes rapidly after germination of the seeds and the disappearance of the cotyledons. Very young seedlings in the cotyledon or two-leaf stage have been reported to be particularly dangerous to swine.56 Steyn269 drenched a rabbit with 120 g of fresh X. strumarium collected in the preflowering stage, with negative results. Apart from the toxic effects of Xanthium spp., the burs may cause partial or complete obstruction and inflammation of the orifice of the prepuce in cattle grazing on reaped lands overgrown with this weed269 (see The skin and adnexa).
Clinical signs of Xanthium poisoning appear several hours after ingestion of the plants. Animals show gastrointestinal pain, muscle weakness and sometimes opisthotonus and convulsions.124 Mendez and coworkers (1998) described clinical signs similar to those of Cestrum laevigatum poisoning in cattle intoxicated by X. cavanillesii (regarded by some as a subspecies of X. strumarium) in Brazil.173 The liver shows the most prominent lesions and these range from diffuse necrosis of the centrilobular and midzonal hepatocytes to fatty changes. Fatty degeneration has also been reported in the myocardium and kidneys. Other lesions include epicardial and serosal haemorrhages,124 status spongiosus and neuronal degeneration in the brain173, and a moderate degree of gastritis and enteritis.124
Hertia pallens DC. Kuntze (Asteraceae)
Springbok bush, springbokbossie, malkopharpuis
Hertia pallens is a poisonous plant affecting primarily the liver and lungs (see Respiratory system) of sheep. Poisoning is commonest during droughts when animals are forced to graze non-selectively.
It is a bushy shrub (Figure 38), growing c.1 m high, with pale papery stems and flat, linear-oblong, alternating leaves which are 25 mm long and 4 mm broad. From August to November, many golden-yellow to orange, solitary flowerheads are borne (Figure 39). The plant is a weed found as a pioneer on denuded soils in the North West Province, western Free State, Northern Cape Province, upper and eastern Karoo and Namibia (Figure 40). It grows on calcareous soil, sand, loam, shale and white quartzite and can become abundant on degraded grassveld, hillsides, rocky ridges, dry river beds, on flats, in low-lying areas and along roadsides. Proper veld management will reduce the numbers of H. pallens.223
There are few reports on H. pallens poisoning in sheep.223, 269, 274 Steyn269 described severe dyspnoea and cyanosis in a sheep before it died 16 hours after being dosed with 600 g of dried plant material. He also reported emphysema of the lungs and subcutaneous tissues of sheep suffering from springbokbossie toxicity.274 More recently, Prozesky et al.223 reported a field outbreak of H. pallens poisoning in the Douglas district as a result of which 92 sheep in a f lock of 258 animals died. Fresh and dried plant material collected during that outbreak were dosed per stomach tube, at different dosage levels and intervals, to nine Merino sheep. One animal died on Day 2 of the experiment after it had been dosed on consecutive days with green plant material at a level of 5 g/kg body mass. Another sheep, which had received three single daily doses of milled dried plants at the same dosage level, died on Day 3.
Clinical signs of poisoning include apathy, anorexia, ruminal atony and tympany, icterus, dyspnoea and cyanosis.223, 269, 274 Affected animals may die suddenly or can survive for up to five days. In some cases, death appears to result from asphyxia. A suspected outbreak of poisoning by a Hertia spp. occurred in sheep in the Pofadder district of the Northern Cape Province. The animals showed icterus, widespread subcutaneous and serosal haemorrhages, greyish-yellow livers and centrilobular hepatic necrosis and haemorrhage (P.J. Jordaan, State Veterinarian. Upington, unpublished data, 1986).
Apart from the liver, which is usually enlarged and yellowish-brown (Figure 41), there may also be icterus, widespread, subcutaneous, serosal and visceral petechial and ecchymotic haemorrhages, severe lung oedema and a mild nephrosis. A range of microscopical lesions occurred in the livers of field and experimental sheep poisoned by H. pallens.223 The majority of these animals showed diffuse hepatocellular degeneration (cloudy swelling, hydropic degeneration and mild to severe fatty metamorphosis) interspersed with individual necrotic hepatocytes. In a few animals, centrilobular, coagulative necrosis was seen (Figure 42). Apart from the hepatic lesions, lung oedema, diffuse mononuclear interstitial pneumonia coupled with hyperplasia of the lining epithelium of the smaller bronchi and bronchioli, as well as a mild nephrosis were evident in some animals (see Respiratory system).
Pteronia pallens L.f. (Asteraceae)
Scholtz bush, Scholtzbossie, witbas, witbossie, witgatbossie
Field outbreaks of Pteronia pallens poisoning occasionally occur in certain areas of the Karoo and are marked by acute liver damage in sheep.222, 266, 269
This is a much-branched, perennial, woody shrub up to 0,6 m high (Figure 43). Distinctive characteristics of P. pallens are the greyish-white stems, the thread-like, narrow, oppositely arranged leaves, which are c.10–30 mm long, and the yellow discoid flowerheads (Figures 43 and 44). The flowerheads contain about 12 florets (flowers) and there are no ray florets or daisy-like outer petals (Figure 44). Each seed bears a brush-like pappus. Flowering time is from September to February, but mostly in October. The plant is found on rocky ridges, hills and slopes (particularly the western slopes), but also on flats. It often grows in dry and bare areas on sandy or stony soil, but seems to prefer calciferous soil.222, 303 The plant is common in the south-western part of the Great Karoo and can also be found in the Little Karoo, its distribution stretching from Calvinia to the Mossel Bay district (Figure 45).222
Little is known about the toxicity of P. pallens. Losses are usually experienced during droughts, when animals are forced to eat Scholtz bush or when sheep are newly introduced into areas where P. pallens occurs. Henning105 (cited by Steyn, 1929) dosed a sheep with 300 g of P. pallens. The animal died 30 hours later without showing any clinical signs, but at necropsy there was evidence of cyanosis, congestion of the lungs and hepatomegaly.
Green P. pallens, collected in the Calvinia district, was stored at -10 °C for 120–365 days and then dosed to sheep at different dosage levels and intervals.222 One animal dosed with 2,5 g/kg body mass of plant material on three consecutive days died c.72 hours after the commencement of the experiment. Another two sheep, which received P. pallens at a level of 5 g/kg body mass per day, died on Day 2 and Day 8 of the experiment, respectively.
The course of P. pallens poisoning is often rapid and animals are found dead. Some of the sheep may show apathy, anorexia, ruminal stasis and a mild icterus.222
At necropsy, the liver is usually enlarged, light brown to dark red in colour with accentuated lobulation, giving the organ a mosaic appearance (Figure 46). There may also be a mild icterus and oedema of the gall bladder wall. Other changes include ascites, hydrothorax, lung oedema, nephrosis and perirenal oedema. The most constant microscopical lesions are centrilobular coagulative to lytic necrosis and haemorrhage in the liver (Figure 47).222 Many of the necrotic hepatocytes may show evidence of mineralization. In one of the experimental animals, Prozesky et al.222 reported diffuse cloudy swelling, hydropic degeneration and fatty metamorphosis of hepatocytes, interspersed with individual necrotic liver cells.
Some farmers try to avoid P. pallens poisoning of their stock by tactical grazing practices. Firstly, newly translocated sheep are fed before they are introduced onto infested pastures; secondly, naive flocks are allowed to graze potentially toxic paddocks for only short periods daily for the first five days or so. The underlying idea is to allow naive sheep to develop conditioned aversion for the plants without being poisoned in the process.
Galenia africana L. (Aizoaceae)
Yellow bush, kraalbos, geelbos
Galenia africana is associated with liver damage and severe ascites (referred to as waterpens or water belly) in sheep and goats in the drier parts of the Western Cape Province of South Africa.303
The yellow bush or kraalbos is an aromatic, woody, perennial sub-shrub, growing c.1 m high, and has small, flat and linear, oppositely arranged green leaves which turn yellow with age (Figure 48). Inflorescences, borne at the ends of twigs, are 30–100 mm long, with many small yellow flowers (Figure 49). The plant is an active invader, often found in disturbed areas such as around kraals, next to roads, on old lands as well as in trampled veld. In recent years G. africana has become more widespread in the western and southern Karoo (Figure 50).303
The marked liver lesions in sheep and occasionally in goats associated with kraalbos have led farmers and researchers to believe that the plant is primarily hepatotoxic to stock. The first reference on the toxicity of G. africana is by Vahrmeijer,303 who states that the plant contains an unidentified toxin, responsible for severe hepatic damage and ascites. Early in the eighties, P.J. Jordaan, State Veterinarian, Middelburg (ECP), submitted tissues from a goat that had died of G. africana poisoning for examination by light microscope. The hepatic lesions in this animal, as well as those found in a retrospective study on preserved field cases in the files at the Veterinary Research Institute, Onderstepoort, were compatible with cyanotic induration of the liver, possibly resulting from congestive right heart failure (J.A.W. Coetzer and J.J. van der Lugt, VRI, Onderstepoort, unpublished data, 1985). In most of the cases where myocardium was available for examination, multifocal lesions, which ranged from acute to chronic, were in evidence.
However, in subsequent dosing trials Van der Lugt and co-workers306 (the first recorded experimental reproduction of G. africana poisoning) could not find evidence to support this theory. They accordingly concluded that G. africana was primarily hepatotoxic with myocardial involvement occurring only in the terminal stages of the intoxication.
In their experiments, seven sheep were dosed for 21–80 days with dry milled G. africana collected in the Calvinia and Willowmore districts. Inappetence, ruminal stasis and apathy, as well as tachycardia were noticed in some of the sheep towards the end of the dosing period. The only animal to succumb naturally received plant material at levels of 5 g/kg body weight from Days 0–6 of the experiment, 10 g/kg from Days 7–13, and 15 g/kg from Days 14–51, at which point the animal developed stasis of the rumen. Terminally (Day 58), the cardiopulmonary flow index was calculated by means of the isotope 99mTc, and a value higher than ten was determined (normal for sheep is 6–7), indicating cardiac dysfunction. Two days later the sheep died of heart failure.
The most prominent clinical pathological change was an increase in the γ-glutamyltransferase activity which in some animals occurred within days of commencement of dosing. This indicated liver involvement in the early stages of intoxication when no heart abnormalities could be demonstrated clinically, clinical pathologically or with cardiac function tests. A decrease in cardiac function was recorded in two sheep towards the end of the dosing period.306
Clinical cases of waterpens seem to develop more commonly in ewes, and especially in those that are in a poor condition during times of drought, when they are forced to browse the plant. During an outbreak only a small percentage of the flock is usually affected, and some farmers are of the opinion that drainage of the ascitic fluid, coupled with deprivation of water for extended periods and an improved diet can lead to recovery of affected animals. The most notable clinical sign of G. africana poisoning is severe abdominal distension (Figure 51). Apart from weight loss, the habitus and appetite of sheep suffering from waterpens remain fair up to the terminal stages of the disease, when animals become apathetic and recumbent, and die.
At necropsy the liver is always affected. Depending on the stage of the disease, the organ can either be smaller than normal or enlarged, the colour may range from a greyish-blue to a yellowish-brown and the morphology of the liver can be unaltered or distorted by nodular hyperplasia, atrophy and/or hypertrophy of certain parts (Figures 52 and 53). Other hepatic changes include distinct lobulation, increased consistency of the parenchyma, and irregular appearance of the surface of the liver (Figures 52 and 53). The liver lesions are usually accompanied by severe ascites. Microscopically, the hepatic changes are characterized by conspicuous centrilobular fibrosis bridging contiguous lobules (giving rise to the so-called lobulation) and duplication of the central veins (Figure 54). Adjacent to the fibrosis, in advanced experimental cases, Van der Lugt et al.306 observed areas of coagulative necrosis, lysis and ballooning degeneration of hepatocytes. According to Coetzer and Van der Lugt, there may also be a portal reaction comprising mild fibroplasia and bile ductular proliferation. Although no gross myocardial lesions have been noted in the few cases studied so far, multifocal microscopical changes, including vacuolar degeneration and hyaline degeneration and necrosis of myocytes, mononuclear cell infiltrations and fibrosis, were discernible in most of the hearts (Figure 55) (J.A.W. Coetzer & J.J. van der Lugt, VRI, unpublished data, 1985). Van der Lugt and his co-workers in their study306 reported hypertrophy of myocytes with consequent degeneration and necrosis and fibrosis. Longer-standing cases displayed diffuse atrophy with scattered groups of residual hypertrophic fibres.
Hepatotoxicoses with Photosensitivity
Photosensitivity resulting from damage primarily to the liver parenchyma
The majority of photosensitivity diseases belong to this group, the principal diseases in the group being Lantana poisoning.
Lantana camara L. (Verbenaceae)
Lantana
Lantana camara poisoning is probably the second most important hepatotoxicosis of cattle in South Africa. This photosensitization is held responsible for c.3% of the national stock deaths from all plant poisonings and mycotoxicoses.133
Lantana camara is an exotic ornamental shrub that has become a noxious weed, particularly in the moist eastern parts of the country (Figure 56). The small, trumpet-shaped, yellow to orange, red and mauve to white flowers are borne in dense terminal clusters, usually with flowers of two different colours occurring in one cluster (Figure 57). The fruits are small black berries, much relished by the birds that spread the seeds.303 It is a declared weed in terms of the Conservation of Agricultural Resources Act (No 43 of 1983).320
Recently, an indigenous species, Lantana rugosa, was implicated in an outbreak of bovine Lantana poisoning near Hoopstad in the North-West Province (T.S. Kellerman & G.L. Erasmus, OVI, personal observation, 1997). L. rugosa is a small spreading shrub with inconspicuous light purple flowers320 and mauve berries (Figures 58 and 59). The crushed leaves emit a typical ‘lantana’ scent.
Lantana camara and two related members of the Verbenaceae, Lippia rehmannii and L. pretoriensis, have been shown to cause photosensitivity when dosed to cattle and sheep.89, 227, 276 The active principle of L. camara, lantadene A, was isolated by Louw,145–147 and those from L. rehmannii, icterogenins A, B and C, by Rimington and co-workers.233, 235 In addition, Barton and De Mayo20 extracted rehmannic acid from the roots of L. rehmannii. All the afore-mentioned compounds are pentacyclic triterpene acids. The structures of the icterogenic agents, i.e. icterogenin (Figure 61), rehmannic acid and 22-ß-angeloyloxy oleanolic acid, were determined by Barton and De Mayo20 and Anderson et al.10
A 22-ß-angeloyloxy side chain in ring E and a hydroxyl group, preferably in a 3-ß position on the A-ring, were shown to be essential for icterogenic activity.34, 35 The toxicity of Lippia plants can be influenced by factors such as pruning and weather, supposedly by affecting the synthesis and/or translocation of toxin between the leaves and roots.240
Under natural conditions, Lantana and Lippia poisoning occurs almost exclusively in cattle, though one outbreak has been reported in goats.119 The goats in question had been newly translocated from the Kalahari where lantana does not occur. Apart from Lantana camara, L. rugosa is the only known potentially toxic species in South Africa. Lippia rehmannii and L. pretoriensis, despite containing pentacyclic triterpenes, seldom cause poisoning.
The clinical signs include anorexia, severe depression, ruminal stasis, diarrhoea, icterus and photosensitivity. Clinical pathological changes consistent with hepatosis and nephrosis have been recorded.89
The macroscopical lesions are typical of hepatogenous photosensitivity, namely, icterus, photodermatitis, yellow to orange-brown discolouration and swelling of the liver (Figure 62), impaction of the caecum and colon, and nephrosis.
The gall bladder may be oedematous and distended with straw-coloured to dark-green bile.253 Paralysis of the smooth muscle of the gall bladder and intestine has been reported,208 but this is now not believed to play an important part in the pathogenesis of the disease212 (vide infra).
The histopathological changes94, 250–254 involving the hepatocytes include swelling, distinct delineation of cell membranes, diffuse cloudy swelling and hydropic degeneration, and sometimes also mild to moderate fatty changes. Intracytoplasmic eosinophilic globules often accompany the above changes (Figure 63). Individual hepatocytes can be necrotic, while, in more advanced cases, foci of coagulative necrosis may be distributed through the parenchyma. The nuclei of some hepatocytes may be enlarged and show mitosis, other cells may be multinucleate, and nuclei sometimes contain pseudoinclusions or have prominent nucleoli. A mild portal reaction consisting of bile ductular proliferation, fibrosis and mononuclear cell infiltration, as well as bile stasis, is not uncommon with this poisoning.
Kidney lesions that include vacuolation and degeneration of the epithelium of convoluted tubules, dilatation of tubules and the presence of various casts have been described. In more chronic cases, multifocal interstitial mononuclear cell infiltration and fibrosis may be seen.
Lantana poisoning has recently been reviewed by Pass (1991)213 and Pass and his co-workers (1985, 1986).210, 212 Being poorly assimilated, the triterpenes must continuously pass through the gut for relatively long periods to induce and maintain intoxication. Pentacyclic triterpenes are absorbed from all areas of the gastrointestinal tract, especially the small intestine, and transported via the portal vein to the liver.209 Here they are metabolized to more polar compounds, which are excreted in the bile, injuring the canaliculi. This damage, which includes loss of microvilli and collapse of the canaliculi, is held responsible for the cholestasis.154, 210, 212, 209
One of the first signs of intoxication is ruminal stasis attributed to (a) reflex inhibition of motility, initiated by the liver as a result of cholestasis, and (b) anorexia.54 A pool of toxins trapped in the static rumen is believed to maintain the intoxication. Treatment, therefore, is aimed at breaking this hepato-ruminal reflex by preventing the trapped triterpenes from being absorbed. This can be done by rumenotomy or the administration per stomach tube of 2,5 kg of activated charcoal in 20 litre of a multiple electrolyte solution. The rationale for the electrolyte solution is to rehydrate the poisoned animal and to stimulate ruminal motility, thereby mixing the charcoal with the ingesta. A second dose of electrolyte solution on the day after administration of charcoal enhances recovery. If marked improvement is not seen within 4–5 days, treatment should be repeated.211, 212
Bentonite has been successfully used to replace the more expensive activated charcoal in dosing trials with calves.211
The treatment with adsorptive agents is effective because (a) intoxication is maintained by constant insult and (b) the lesions in the liver are reversible.210, 212, 213 The prognosis, nevertheless, is guarded as kidney failure is a common sequal.
Lantana can be controlled by manual/mechanical or chemical means. Biological control by insects, though of limited value when applied alone, may increase the effectiveness of other measures by suppressing the growth and reproduction of the plant.12 The extreme variability of L. camara, with its multiplicity of forms320 is said to complicate both the chemical or biological control of the plant. Longterm biological control of L. camara is hampered by a predilection for certain forms by host-specific insects, and chemical control by variable response to herbicides.80 Currently an integrated approach, involving several methods, depending on local conditions, is advocated. Since lantana will regrow after being cut, it is essential to uproot the plant. In dense stands this may lead to erosion and – because uprooting disturbs the soil – promotion of regrowth. Herbicides may be applied to the soil, stumps or foliage. The disadvantage of soil application is that desirable plants, such as trees, may also be killed. Applying herbicides to stumps has the advantage of obviating uprootment. Spraying herbicide on the foliage of dense thickets of lantana may be impossible; in such instances, the plants may have to be cut and allowed to regrow before herbicide is applied. Slashing and uprooting, being most labour intensive, is the most costly, while slashing and application of herbicide to the stumps is usually the most economical. Whatever method of control is applied, follow-up is essential. Unless the seedlings are pulled or spot-spraying of herbicides is applied, seeds in the ground may re-establish the infestation.12
Lasiospermum bipinnatum (Thunb.) Druce (Asteraceae)
Ganskweek
Lasiospermum bipinnatum is a soft-leafed, decumbent to erect herbaceous plant, standing about 400 mm high (Figure 64). The capitulae of diameter c.30 mm are borne terminally on long (up to 300 mm) seldom branched peduncles. The ray florets are white to purplish-pink and the disc florets are yellow (Figure 65).7, 127
Although the plant is widely distributed (Figure 66), L. bipinnatum has not been recorded in KwaZulu-Natal.133 It seems to prefer vleis, but can grow almost anywhere.7 Adelaar et al.7 demonstrated that the plant was hepatotoxic to sheep and Kellerman et al.127 experimentally confirmed field observations that it can cause hepatogenous photosensitivity. The reported lethal doses of milled dried L. bipinnatum for sheep are c.7,0–9,7 g/kg7, 6,7 g/kg per day for five days127 and 6–12 g/kg for 6–12 days.322
Three outbreaks of L. bipinnatum poisoning, all involving cattle, have been reported in the literature, namely, near Bethlehem81 (Free State), Graaff-Reinet292 and Molteno220 (Eastern Cape Province) in South Africa. Thornton292 concluded that poisoning with this plant was one of the most important intoxications of sheep and cattle in the Graaff-Reinet district, especially in winter. The plant, which is apparently more resistant to frost than grasses, may be abundant in late winter or spring when grazing is sparse.7 Outbreaks have also been reported on infested lucerne pastures.
The most important clinical signs, apart from icterus and inconstant photosensitivity, are anorexia, depression, ruminal stasis and constipation. Colic (kicking at abdomen, etc.), tenesmus, and a high temperature (41 °C), although rare, have been reported also to occur.7, 81, 127, 292, 322 Intoxication can be manifested within three days of animals being introduced into a toxic camp.292
Macroscopically and histopathologically, the liver lesions are very similar to those of Athanasia minuta and A. trifurcata poisoning (Figure 67). The principal histopathological lesions in the liver lobules of the single sheep poisoned by Kellerman et al.127 consisted of a peripheral zone of fatty degeneration, a midzonal area of coagulative necrosis and a centrilobular area that was mildly affected. Adelaar et al.7 observed that in less acute cases there was a tendency for the lesions to be peripherally arranged (Figure 68), while Fair et al.81 regarded peripheral necrosis as a characteristic lesion of acute L. bipinnatum poisoning. According to Williams (1990), however, depending on the dose rate, the necrosis may be centrilobularly, midzonally or peripherally distributed.322 In subacute poisoning, instead of zonal necrosis, a range of diffuse changes have been seen, including parenchymal degeneration, single-cell necrosis, anisonucleosis, intranuclear pseudoinclusions, marked bile ductular proliferation and portal fibroplasia.7, 81, 127, 292, 322 Williams (1990)322 noted pale orange-pink areas in the cytoplasm of hepatocytes, especially around the portal tracts, of lambs that received lower doses. Ultra-microscopical examination revealed the pale areas in the cytoplasm to be composed of proliferating smooth endoplasmic reticulum (SER) that displaced other organelles. The hypertrophy of the SER was thought to reflect increased production of mixed function oxidases involved in detoxification.322 He also described pulmonary lesions in lambs dosed with a specific consignment of the plant (see Respiratory system).323
Hepatic and pulmonary lesions similar to those of sheep have been described in cattle poisoned by ganskweek in the field.220
The active principles of L. bipinnatum have been identified as furanosesquiterpenoids similar to those isolated from Myoporum deserti in Australia114 (Figure 69) (L.A.P. Anderson, VRI, Onderstepoort, personal communication, 1986).
Athanasia minuta (L.f.) Källersjö subsp. minuta (Asteraceae)
(= Asaemia axillaris) Vuursiektebossie
Vuursiektebossie is a many-branched, woody shrublet, growing up to 0,5 m in height (Figure 70). Small narrow leaves are arranged opposite each other on pale yellowish branches that end in spikes. The small yellowish to white flowerheads are sessile (Figure 70(a)).127, 303
Acocks4 described it as a species typical of the Upper or Typical form of the Western Mountain Karoo extending into the Central Arid Karoo (Figure 71). Although an inhabitant of arid regions, it always grows near water, e.g. in the vicinity of dams, pans, vleis and rivers (Figure 70(b)).
It has been long known from field observations that A. minuta causes peracute deaths or may be responsible for photosensitivity in sheep.274 Van der Walt and Steyn308 described a case of experimental A. minuta poisoning where a sheep developed liver damage and icterus. Later it was confirmed that photosensitivity was part of the syndrome.127
Macroscopically, the liver is usually moderately swollen, friable and yellowish-brown, with accentuation of the lobulation. Scattered areas of congestion throughout the parenchyma, as well as dark-red zones in most lobules, that gave the organ a mosaic appearance, were seen in severely affected animals (Figure 72). These changes may be accompanied by icterus, oedema of the gall bladder and nephrosis.
Centrilobular necrosis involving at least two-thirds of the lobules was observed in the liver of a sheep peracutely poisoned with 10 g/kg of the dried plant. Two sheep dosed at lower levels (2,5 g/kg and 5,0 g/kg) died acutely after becoming mildly photosensitive.127
The principal lesions observed were prominent periportal fatty degeneration, midzonal coagulative necrosis and milder centrilobular changes.127
In a subsequent experiment, Coetzer and Bergh51 studied the hepatic lesions of three sheep forced to graze in a camp heavily infested with A. minuta. They became sick three to seven days after being introduced into the camp, and showed signs such as apathy, intensely yellow urine and mildly swollen lips. Marked peripheral coagulative necrosis and haemorrhage were evident in the liver lobules of one sheep (Figure 73). Examination of another sheep revealed marked bile ductular proliferation, cloudy swelling, hydropic degeneration, fatty metamorphosis and scattered single cell necrosis of hepatocytes. Hepatocellular unrest (anisocytosis, anisonucleosis, increased mitosis and binucleation), and bile stasis completed the histopathological picture (Figure 74).
The results obtained by Kellerman et al.,127 and Coetzer and Bergh51 showed that the liver lesions in A. minuta poisoning ranged from distinct zonal necrosis (peripheral, midzonal and centrizonal) to diffuse degeneration and hepatocellular unrest.
These changes were often accompanied by bile ductular proliferation and cholestasis.
Since the only documented, histopathologically confirmed outbreak of A. minuta poisoning occurred in October, when the veld was bare,51 it would appear that the plant is eaten only when sheep are driven by necessity to do so.
A. minuta is believed to contain furanosesquiterpenoids as the clinical signs and lesions induced by it resemble those of Lasiospermum bipinnatum poisoning.133
Athanasia trifurcata (L.) L. (Asteraceae)
Klaaslouwbos
Athanasia trifurcata is a perennial, relatively unpalatable, erect, aromatic shrub, growing about 1,3 m high, with dark- or bright-green to grey-green leaves borne alternately. The leaves, up to 40 mm long, vary in size and are three- to five-lobed in the upper part. The flowerheads are bright yellow (Figure 75).128
The plant is common in the Western Cape Province (Figure 76) where it grows, preferably on sandy soils, near the coast. Acocks5 lists A. trifurcata as one of the important species in the Coastal Renosterveld. It can be a troublesome weed on lands and overgrazed veld.128
A sheep died after being given 10 g/kg dried milled plant from a toxic pasture (vide infra) on two successive days. Another became photosensitive after receiving seven doses of 2,5 g/kg in ten days.128
The only published account of an outbreak of A. trifurcata poisoning was of one investigated near Grabouw. A number of ewes died and a few became photosensitive on a paddock heavily infested with the plant. Clinical signs appeared within two days after the introduction of a large f lock into the camp to graze down the weeds non-selectively.128
The most notable clinical signs were apathy, anorexia, ruminal stasis, icterus and photosensitivity. Macroscopically, the liver was usually swollen, friable and yellowish-brown in colour, with distinct lobulation (Figure 77).128 Oedema of the gall bladder was sometimes seen.
Depending on the levels and intervals of dosing, different patterns of zonal necrosis (peripheral, midzonal, centrizonal) were seen in the various animals (Figure 78). In the sheep that received the lowest dose of toxic material the necrosis was not zonally distributed, but consisted mostly of multifocal areas of necrosis, accompanied by cloudy swelling or hydropic degeneration and unrest of hepatocytes. This sheep was the only one to become photosensitive.128
The toxic principles of A. trifurcata are also believed to be furanosesquiterpenoids (L.A.P. Anderson, OVI, personal communication, 1989).
Nidorella foetida (L.) DC. (Asteraceae)
This is a branched, erect, hairy, slightly woody perennial, about 1 m tall, with yellowish flower heads. The bright-green, often tufted, linear-spathulate leaves are covered with short glands mingled with coarse hairs.244
It is a minor poisonous plant, limited to the Coastal Renosterveld and West Coast Strandveld of the Western Cape Province, where it grows in swampy places. Only one incident of ovine hepatogenous photosensitization by N. foetida, which is unpalatable, has been recorded.244
The lesions in the liver are characterized by peripheral coagulative necrosis and midzonal degeneration. In more chronic cases mild bile duct proliferation and hepatic regeneration may be evident.244
A closely related species, N. anomala, sometimes chokes natural pastures on the Highveld and in the bushveld of the Limpopo Province. Although cattle and sheep are frequently exposed to heavy infestations, no incidents of poisoning by the plant have been recorded (T.W. Naudé and T.S. Kellerman, ARC-OVI, personal observation, 1999).
Cyanobacteria (= blue-green algae)
Fresh-water cyanobacteria (= blue-green algae) are phototropic organisms which differ from other groups of algae in that they possess no nuclear membrane. They are sometimes encountered also in slightly saline (brackish) waters.
Cyanobacteria, among others, produce neurotoxins and hepatotoxins. Of these, the hepatotoxins are by far the most important. The hepatotoxins are cyclic polypeptides consisting of both D and L amino acids and include the large group of closely-related heptapeptides, the microcystins, (Figure 79) produced by the genera Microcystis, Anabaena and Oscillatoria and a pentapeptide, nodularin, produced by the genus Nodularia.43 Only the hepatotoxic syndrome has been described in livestock in southern Africa. The nervous signs reported abroad are attributed to secondary amines, emanating from Anabaena, Aphanizomenon and Oscillatoria spp.43
Most cases of poisoning in animals and humans, worldwide, have been caused by the genera Microcystis, Anabaena, Aphanizomenon, Nodularia, Nostoc and Oscillatoria.43 Although these genera occur in South Africa,248 poisoning of animals only by Microcystis aeruginosa263, 273 and possibly Nodularia spumigena100, 311 has been reported. For a simple key to the identification of the genera Microcystis, Anabaena and Oscillatoria, refer to the end of this section.
Microcystis aeruginosa forma aeruginosa (Anacystis cyanae) (= M. toxica)
Toxic specimens of Microcystis were identified by Stephens263 as M. toxica sp. nova. The pinhead-sized colonies of this cyanobacterium are composed of numerous minute (3,5–7 μm) cells embedded in a mucilage (Figure 80). The cells contain vacuoles which enable them to float. On calm, hot, fine days the algae rise to the surface to form a lettuce-green scum that is blown by the wind against the leeward banks of dams, pans, etc. (Figure 81). Here the accumulated mass of algae may die to release a beautifully hued blue to purple chromoprotein, phycocyanin. The stench arising from the decomposing algae can be appalling.148, 263, 272–274
Microcystis aeruginosa is a cosmopolitan cyanobacterium18, 95, 103, 150 widely distributed in South Africa247 where it causes stock losses, principally in Mpumalanga, Gauteng and north-eastern Free State.273, 274 Many of the periodic incidents of poisoning occur around the Vaal272 and Hartebeespoort dams.
According to Steyn (1945),271–272 the cyanobacterium produces two poisons; one a photosensitizing agent phycocyanin, and the other a hepatotoxin. Alternatively, he suggested that if phycocyanin was not responsible for the photosensitivity, then it was caused by phylloerythrin.273 In the light of Clare’s48 doubts as to the photodynamic properties of phycocyanin and the demonstration of phylloerythrin in the blood of a sheep poisoned with M. aeruginosa (T.S. Kellerman and J.A.W. Coetzer, VRI, Onderstepoort, unpublished data, 1983), Steyn’s second supposition is correct.
Louw148 isolated an alkaloid from M. toxica (M. aeruginosa), now regarded as not being the primary toxin. Subsequent work revealed that the hepatotoxin(s) of M. aeruginosa18, 272, 273 are, in fact, peptides.78, 95, 296
The toxins of cyanobacteria – which include alkaloids, polypeptides, pteridines and lipopolysaccharides (endotoxins)27 – have recently been reviewed by Carmichael (1992).43 According to sources quoted by him, the hepatotoxins consist of a large group of related heptapeptides, the microcystins (MCYST), and a pentapeptide, nodularin (vide supra). Toerien and co-workers296 isolated a toxic heptapeptide MCYST from South African blooms of M. aeruginosa in 1976 and Botes et al., (1982, 1985)23, 24, 25, 26 and Santikarn et al. (1983)243 determined the structure of a MCYST from a local strain of the organism. They concluded that the toxin was a monocyclic heptapeptide containing both D and L amino acids, two of the former being novel. The definitive structure of MCYST-LR was elucidated by Rinehart et al. (1988).236
A large number of toxic and non-toxic cyclic heptapeptide microcystins, differing in their L-amino acid combinations, are known to occur. MCYST-LR is the commonest of these.43
The toxin is released into the water when the cyanobacteria die or disintegrate. This can occur after copper sulphate treatment of the water or in the rumen or stomach after ingestion by an animal. Despite being relatively heat stable,271 the toxin breaks down fairly rapidly in the water.263 Conventional water purification processes may not effect complete detoxification.107
Not all strains of M. aeruginosa are toxic.115 In addition to the relative toxigenicity of a particular algal strain, toxicity is dependent on the concentration of algae in the water. For this reason most poisoning occurs in the leeward verges of dams where algal concentrations are highest. Low temperatures (that cause the cyanobacteria to sink), and water turbulence (that disperses them) may also conceivably play a role. Calm, shallow, eutrophic water and fine, hot, sunny weather promote cyanobacterial growth.272, 273
Horses, cattle, sheep, dogs, turkeys, ducks and fish purportedly have been poisoned by algae in South Africa, but ruminants are the species most commonly affected.274
In a dosing trial, the alga was still toxic after storage for c.10 years at 4 °C. The material was obtained by drying in the sun cyanobacterial suspensions collected during an outbreak at Hartebeespoort Dam. An oral dose of 2 g/kg killed a sheep in less than 24 hours, while one out of two sheep receiving 1 g/kg died within 48 hours. At these levels death occurred before photosensitivity could set in. Photosensitivity was, however, induced within four days by dosing as little as 0,5 g/kg to a lamb on three successive days (T.S. Kellerman and J.A.W. Coetzer, VRI, Onderstepoort, unpublished data, 1983).
Practically all toxic microcystins have an LD50 i.p. for a mouse of c.60–70 μg/kg.43
Steyn272–274 lists the principal signs of acute poisoning as paralysis and convulsions, but nervous signs were not seen in the most recent investigations. Less acutely affected animals display constipation (faeces hard and covered with blood), weakness, a drop in milk yield and photosensitivity. Apathy, icterus, inappetence and ruminal stasis complete the clinical picture.150, 151, 272–274
In the animals that show early photosensitivity, the liver (Figure 82) and kidneys are usually slightly to moderately swollen and greyish-yellow in colour. Apart from icterus and lesions compatible with photosensitivity, the caecum and colon are usually impacted with dryish faecal balls.
Massive hepatic necrosis (Figure 83) was evident in the sheep peracutely intoxicated as described above. Narrow rims of intact but degenerated hepatocytes were only noted around the portal triads. Similar lesions were described in sheep that died without signs of photosensitivity.139, 150 In subacutely affected sheep that became photosensitive, the lesions consisted of moderate to severe fatty degeneration of hepatocytes, necrosis of individual or small foci of hepatocytes (Figure 84), formation of intracytoplasmic eosinophilic globules in some hepatocytes and accumulation of a lipofuscinous pigment in Kupffer cells, especially in the centrilobular areas (Figure 85). In addition, mild centrilobular fibrosis, as well as mild bile ductular proliferation and portal fibrosis, were observed in the more chronically affected sheep (T.S. Kellerman and J.A.W. Coetzer, VRI, Onderstepoort, unpublished data, 1983).
The probable mechanism of action of these hepatotoxins, which lead to haemorrhagic shock, has been reviewed by Carmichael (1992).43 After absorption from the ileum via bile acid carriers, the toxin is preferentially transported into the hepatocytes. Here they bring about changes in the actin microfilaments, causing dense aggregation of the microfilaments of the cytoskeleton near the centre of the cell. As a result of the loss of cellular support, the parenchymal and sinusoidal endothelial cells are destroyed, leading to intrahepatic haemorrhage and/or hepatic insufficiency.
Apart from liver pathology in mice experimentally poisoned with M. aeruginosa,18, 78, 83 mutagenesis has been demonstrated in rats as a long-term after-effect of sublethal doses of toxic M. aeruginosa.137 Microcystins and nodularin, can, therefore, potentially promote liver tumours.43
Different syndromes of cyanobacterial (blue-green algal) poisoning have been reported in humans from various parts of the world.27, 82 Evidence has even been submitted of liver damage in humans as a result of intoxication with M. aeruginosa.82
Water intended for microcystin analysis should be kept frozen. The analysis is carried out by HPLC.43
Although not ideal, the mouse bioassay is still used in South Africa to screen contaminated water or cyanobacterial bloom material for toxicity.
Copper sulphate, at 1–2 ppm, is most commonly used to control the bloom on farms in South Africa.273, 274
Other cyanobacteria
In 1997 an outbreak of cyanobacterial poisoning occurred near Humansdorp in the Eastern Cape. A herd of 500 Holstein cows had access to a kikuyu pasture which had been rested for six weeks. The watering point, a trough of c.1 500 litre situated next to a road, did not appear to have an obvious cyanobacterial (algal) bloom, although probably eutrophied by fertilizer. Twenty-four hours after drinking this water the cows started dying and eventually a total of 290 were lost. Cyanobacterial hepatotoxicosis was diagnosed and confirmed histopathologically. Chronic liver damage necessitated the destruction of a further 70 cows.
The ruminal contents of two dead cows yielded the cyanobacterial genera Anabaena, Oscillatoria (possibly O.limnecta) and Merismopedia. Freeze-dried bile of these two cows contained 19.1 μg/g and 3.42 μg/g of a microcystin eluting in the hydrophobic area where microcystin-LF and -LW occur. The rumens contained the same compound. Water taken the day after exposure from this trough (which had been emptied by the cows and had filled up again), however, was devoid of significant cyanobacteria or microcystins and negative in the standard mouse bioassay. A week after the trough had been cleaned out and replenished a dark-green band was still evident just below the water level. Samples from this band revealed an ingrained population of Anabaena and Oscillatoria spp. It is suspected that this outbreak was due to benthic (bottom-dwelling) cyanobacteria similar to the outbreaks described by Mez et al. (1997)175 in Switzerland (W.R. Harding, City Council, Cape Town & A. van Halderen, Veterinary Investigation Centre, Stellenbosch, personal communication, 1998).
Similarly, mortalities in 10 out of 18 goats ascribed to histopathologically confirmed cyanobacterial hepatotoxicosis in the Limpopo Province, were traced to water from a single cement drinking trough. The water contained 71–91 μg/litre of hydrophobic microcystins and the only cyanobacterium of consequence isolated from it was an Oscillatoria sp. (T.A. Gous, Veterinary Laboratory, Louis Trichard & W.R. Harding, Cape Town, personal communication 1997).
Identification of some cyanobacteria
According to Truter (1987)301 colonies of both Anabaena and Oscillatoria spp. (Figure 86), in contrast to those of Microcystis, are filamentous.
Anabaena spp. occur in the form of entangled strings of bead-like or barrel-shaped cells, 8–14 μm broad, contained within a gelatinous sheath. These trichomes may either be coiled, merely curved or even straight and appear as soft and formless colonies floating freely in the water.301
In the case of Oscillatoria spp., on the other hand, the filaments consist of strings of more or less rectangular cells. Their diameters may vary from 1 to more than 30 μm and they are not contained in gelatinous sheaths. The unbranched trichomes may be straight or twisted and entangled and are sometimes apically attenuated. They move by oscillating or gliding action; but may be benthic, thus confining them to shallow water where photosynthesis can take place.301 This bottom-dwelling characteristic results in more or less clear water which may be highly toxic.
The correct identification of the specific cyanobacterial species involved is very important. According to Truter (1987)301 water specimens with the cyanobacteria under suspicion should be preserved with 1 ml/litre of Lugol’s stock solution (40 g of iodine crystals and 60 g of potassium iodide/l water) for taxonomic examination.
Phomopsis leptostromiformis (Kühn) Bubak (Fungi: Coelomycetes)
The teleomorph of this fungus has been classified as Diaporthe toxica sp. nov.324
Phomopsis leptostromiformis is a phytopathogen of certain Lupinus spp. (Figure 87) that can grow saprophytically on its dead host. In the living plant it forms yellowish to brown, sunken lesions that contain black stromatic pycnidia, mostly on the lower stems. Dark-brown, water-soaked spots, often with the pycnidia concentrically arranged, appear on the pods. A coarse white mycelium, which may be visible on the pods, eventually turns them a dark-brown colour (Figure 88). The infected seeds are brown and shrivelled.161, 162
The fungus causes lupinosis,316 a hepatotoxicosis primarily of sheep, but also of cattle, and more rarely of horses and swine.91, 162, 313 It has been reported in several countries including Germany,141 New Zealand,29 South Africa316 and Australia.91 In South Africa, the disease occurs in the Winter Rainfall Area of the Western Cape Province where lupines are cultivated primarily as a green crop and the stubble is grazed by stock.98, 316 Lupinosis is of relatively little importance in South Africa.
During October 1969, 530 ewes out of 850 died of lupinosis on a field of white lupines (L. albus) in the Hermon district. Examination of the field revealed that the sheep had grazed principally on pods, many of which had typical signs of P. leptostromiformis infection. Rainfall and temperature in the area had been above normal for the month.316
Phomopsis leptostromiformis, isolated from the plant material collected in the toxic field and cultured on sterile lupine seeds, caused typical signs of the disease in sheep.316 This was the first experimental induction of lupinosis by dosing pure cultures of a fungus to animals.
Van Warmelo et al.316 reported that an oral dose of 2,5 g/kg of culture administered daily for five days caused the death of a sheep in ten days. A higher dose of 7,5 g/kg per day was fatal in five days. The LD50 of another culture was estimated to be approximately 4 g/kg (T.S. Kellerman and W.F.O. Marasas, VRI, Onderstepoort, unpublished data, 1971).
Crystalline phomopsin A, the principal mycotoxin responsible for lupinosis,62 has been characterized as a linear hexapeptide with an ether-bridged macrocyclic ring61, 149 (Figure 89). The approximate ovine subcutaneous LD50 of phomopsin (97% pure, containing c.90% phomopsin A and 10% phomopsin B) was 10 μg/kg and the intraruminal dose, giving a similar response, was 1 000 μg/kg.219 A practical sensitive enzyme immunoassay for the detection of phomopsins in animal tissue, lupin seed and stubble has been developed by Than et al. (1992).284
Sheep usually become affected within two to three days of receiving a lethal dose, and die about four to eight days later. The clinical signs include anorexia, apathy, weakness, ruminal stasis, constipation and icterus, occasionally accompanied by photosensitivity.91, 316 In more chronic intoxication the course of the disease is prolonged and, in addition to the usual signs, there is a reduction in body mass.91 Apart from loss of production, phomopsins may have a severe detrimental effect on the reproductive performance of ewes. Ovulation rate was depressed and fewer ewes became pregnant after subcutaneous injection of phomopsin in trials conducted around the time of mating.19
The most conspicuous gross lesions in sheep that die acutely of lupinosis are swelling and greyish-yellow discolouration of the liver (Figure 90), icterus, gastrointestinal stasis and subcutaneous and serosal haemorrhages. In subacute to chronic cases, the liver may be markedly atrophic (particularly on the left side) and fibrotic, with compensatory nodular hyperplasia giving rise to the so-called boxing glove liver (Figure 91).91, 316 The latter is usually associated with signs of liver failure, including effusion of body cavities and oedema, especially of the gall bladder and abomasum.
The histopathological lesions in the liver of acute cases included hepatocellular fatty degeneration (Figure 92), the formation of eosinophilic globules in their cytoplasm, anisonucleosis, megalocytosis, multinucleation and nuclear vesiculation. Pseudoinclusions can be seen in some of the enlarged nuclei. Some hepatocytes and Kupffer cells may contain lipofuscinous pigment. In chronic ovine intoxication prominent centrilobular fibrosis is evident (Figure 93).91, 316
Phomopsins interfere with the formation of microtubules by binding to tubulin (the protein building blocks of these important tube-like organelles), primarily in the liver. Among others, microtubules make up the mitotic spindle and are involved in the movement of lipids and bile components. Interference with microtubule formation, therefore, could explain the nuclear and fatty changes.113, 297
The disease may occur in sheep grazing both sweet and bitter varieties of L. angustifolius, L. albus and L. luteus, the three species commonly cultivated in South Africa.98, 162, 316 Control of the disease would be achieved ideally by breeding varieties of lupines resistant to the fungus. Lupinus angustifolius is more resistant to infection by the fungus than L. albus or L. luteus, but this resistance breaks down when the plants become senescent, with the result that the saprophytic growth on the dead plants may be similar for all species.162, 312 Lupinus mutabilis is reported to have the highest resistance to both infection and subsequent saprophytic colonization by P. leptostromiformis, a property that might be useful in future lupine breeding programmes.162, 312
Until resistant varieties become available, control should aim at preventing the ingestion of toxic plants, but this would be difficult to apply in practice, as the factors required by the fungus for growth and toxin production are not yet well enough understood for the toxicity of pastures to be forecast. Grazing of old lupine stubble (i.e. long after harvest) should be avoided, especially if accompanied by prolonged heavy rain and above normal ambient temperatures.91, 162
In Australia, field trials with an experimental vaccine against lupinosis have given promising results.8, 217, 285
Stellenbosch photosensitivity
This is an ovine hepatogenous photosensitivity syndrome of unknown aetiology encountered in the Winter Rainfall Area, usually during spring and early summer. On some farms the disease is an almost annual occurrence with a morbidity of about one to 50% and a mortality of up to c.25%. Usually, however, the mortality is low. Sheep, especially lambs, may become photosensitive within 48 hours of being introduced into a toxic pasture. The pastures on which outbreaks occur vary widely in kind. No unifying or common factor has been observed between outbreaks that might point to a possible causal agent.
Although, among others, sporidesmin, producing strains of Pithomyces chartarum, have been isolated from these pastures during outbreaks, it is not thought that sporidesmin plays a role in the aetiology of the disease. Militating against its involvement is the short latent period and unusual hepatic lesions. The histopathological lesions vary from individual cell or haphazardly scattered foci of hepatocellular necrosis to diffuse necrosis or fatty degeneration of the parenchyma. The latter is often accompanied by a mild to severe bile ductular proliferation. At present the most likely causal agent is thought to be an unidentified toxic fungus (T.S. Kellerman, W.F.O. Marasas, D.J. Schneider and J.A.W. Coetzer, VRI, Onderstepoort, unpublished data, 1975).
Photosensitivity resulting from damage primarily to the biliary system
Not many photosensitivity diseases belong to this group, but they are all of major economic importance.
Pithomyces chartarum (Berk & Curt.) M.B. Ellis (Fungi: Hyphomycetes)
Facial eczema is one of the most important photosensitizations of stock in the world, causing severe losses in production especially in New Zealand. It is induced by the ingestion of herbage (usually Lolium perenne) contaminated by sporidesmin-containing conidia of P. chartarum. Unlike in New Zealand, in South Africa, where the condition occurs only sporadically, facial eczema is of relatively minor importance.
The fungus Pithomyces chartarum produces rough, barrel-shaped, dark-brown conidia (Figure 94), borne singly on short simple conidiophores. They can be distinguished from like spores by normally having three transverse septae and one to two longitudinal septae dividing the middle cells.68, 69, 165
Pithomyces chartarum is a cosmopolitan fungus165 known to cause hepatogenous photosensitivity of livestock (facial eczema or pithomycotoxicosis) in various countries, including New Zealand,48, 192, 293 Australia112 and South Africa.166 In South Africa, the fungus has been found in a wide range of conditions of temperature, moisture and substrate (Figure 95), e.g. in the cool, relatively moist coastal belt, in the hot, semi-arid Karoo and in the warm, temperate grasslands of the Highveld.129, 165, 241, 307 Facial eczema has been reported in sheep on rye grass/clover pastures (Figure 96) near Humansdorp166 and on green wheat near Brandfort,65 as well as in cattle grazing rye grass/clover on a sewage farm near Johannesburg. In the latter instance, subacute facial eczema (Figure 97), complicated by purulent nephritis and cystitis, was induced by dosing cultures of P. chartarum from the toxic pasture to a young bull (T.S. Kellerman, OVI, unpublished data, 1975). The disease has also been diagnosed in the winter rainfall area of the Western Cape Province.
Pithomyces chartarum lives saprophytically on dead plant material littering pastures. During favourable weather conditions, numerous conidia are produced31, 294 that contain a potent hepatotoxic epipolythiadioxopiperazine, sporidesmin (Figure 98).282, 321 The toxic conidia are transported by wind and water from the litter onto the surfaces of the surrounding ryegrass/clover leaves, where they adhere. Should sufficient conidia-polluted leaves be ingested by stock, facial eczema will result.59, 69, 261 Even during fairly severe outbreaks of facial eczema both in New Zealand69 and South Africa (G.C.A. van der Westhuizen and Cecilia Roux, Plant Protection Research Institute, Pretoria, unpublished data, 1977), P. chartarum may not be a major component of the pasture mycoflora. Contrary to the findings in New Zealand, however, both toxigenic and non-toxigenic strains in South Africa are frequently isolated from the same material, and non-toxigenic strains predominate.129, 164, 241
The toxicity of sporidesmin is thought to be vested in the disulphide bridge (Figure 98). Cyclic oxidation and reduction of this disulphide bridge, catalized by copper, leads to the formation of harmful superoxide radicals. The pathological changes in the liver have been ascribed to these radicals.195, 196, 197
Mortimer and Taylor192 found that 1,0 mg/kg sporidesmin administered orally to sheep induced over 80% photosensitivity and c.70% mortality. At 0,5 mg/kg two thirds of the animals became photosensitive, and 8% died. Mild liver lesions were apparent at 0,3 mg/kg, but photosensitivity did not ensue. High oral doses of 3,0 mg/kg cause death within four days, often without photosensitivity.
Potentiation of the toxicity of sporidesmin has been reported in sheep. Animals that received low levels of toxin on consecutive days showed more severe hepatic lesions and higher activities of γ-glutamyltransferase (GGT) in their blood than those that were given the total amount of sporidesmin in one dose.
The pathological changes have been thoroughly investigated.52, 129, 164, 189, 190, 192 As a result of varying sized, yellowish-brown, slightly sunken areas scattered throughout the parenchyma, the liver often has a mottled appearance. In the more chronic cases the consistency of the liver is increased, the lobulation is more distinct and the morphology distorted by fibrosis, areas of nodular hyperplasia (Figure 99(a)) and atrophy of the left lobe (Figure 99(b)). The walls of the larger intra- and extrahepatic bile ducts and ductus cysticus are often conspicuously thickened and oedematous (Figure 100).
Apart from these lesions, oedema, haemorrhages and ulcerations have been reported in the gall bladder (Figure 101(a)) and urinary bladder (Figure 101(b)). The kidneys are often swollen and yellowish-brown in colour, while the surface of the cortex often has a slightly uneven appearance as a result of tubular dilatation. In some cases there may be a pyelonephritis.
Moderate to severe portal fibroplasia and bile ductular proliferation are almost constantly present, the fibrosis being mostly concentrically arranged around the bile ducts in the portal triads and the larger ducts traversing the parenchyma (Figure 102). The degree of fibrosis and bile ductular proliferation in the portal triads often varies in different areas of the same liver, and are more severe in the yellowish-brown sunken foci. Generally speaking, the mucosae of the major intra- and extrahepatic bile ducts and ductus cysticus are more constantly affected by degeneration and/or necrosis (Figure 103) than the smaller ducts or ductules in the portal triads. The ductal necrosis is often associated with marked periductal granulation tissue proliferation and fibrosis (Figure 103). In some instances the lumina are entirely replaced by scar tissue (Figure 104). These changes, together with the accumulation of necrotic debris and inspissated bile, culminate in the partial or complete occlusion of the affected ducts. Vascular lesions, which include fibrinoid degeneration and necrosis (Figure 105) or subintimal thickening by fibrosis of the blood vessel wall in juxtaposition to the affected duct, sometimes accompany the changes in the biliary system. The parenchyma is minimally affected and small periportal foci of hepatocellular necrosis (bile infarcts), infiltrated with neutrophils and some macrophages, are seen in some lobules.
The GGT activity in the sera of healthy sheep in South Africa varies between 13,6 and 32,4 m lU/ml ,155 and in New Zealand between 30 and 55 m IU/ml. The rise in GGT activity usually correlates with the severity of the lesions in the liver and there is as a rule a delay of some days from the first exposure to sporidesmin before an elevation will be detected. The maximum activity will be reached about two to three weeks after exposure, and may persist for many weeks. In animals that receive a moderate toxic challenge, the GGT activity may be slightly to extremely elevated. The GGT rise may reach 500 m IU/ml or higher in animals with marked liver damage300 (N.R. Towers, Ruakura, Hamilton, New Zealand, personal communication, 1983).
One of the characteristic features of facial eczema is that it has a latent period (period of apparent clinical normality) between ingestion of sporidesmin and manifestation of photosensitivity. This interval corresponds to the time taken for the obliterative cholangitis and subsequent retention of phylloerythrin to take place. In experiments in South Africa, the latent period was about 10 to 14 days with an approximate range of 9 to 24 days.129
The control of facial eczema in New Zealand has been succinctly reviewed by Smith et al. (1998).262 According to the authors quoted by them, the control of facial eczema is based on recognition and avoidance of dangerous pastures, fungicidal spraying of pastures, prophylaxis against facial eczema and breeding of resistant animals.
In New Zealand, outbreaks are forecast by monitoring conditions favouring sporulation. High humidity and rainfall greater than just a few millilitres, followed by two or more successive nights of grass minimum temperatures of 12 °C or over, constitutes a danger period.185 The occurrence and frequency of such periods are used for predicting outbreaks. However, spore counts are now regarded as a better gauge of the toxicity of pastures; 50 000 spores/gram fresh grass over a few weeks and 200 000–300 000 spores/gram over a few days being rated as dangerous.66, 262 Encouraging results have been obtained in the biocontrol of facial eczema by inoculating pastures with non-sporidesmin-producing strains of Pithomyces chartarum. In field trials non-toxigenic strains successfully competed with the resident sporidesmin-producing strains to reduce the toxicity of pastures.57, 262 The build-up of P. chartarum populations can be controlled for 4–6 weeks by the application of substituted benzimidazole fungicides at the rate of 140–280 g/hectare. Although effective, spraying with these fungicides is expensive.191, 207, 262 Zinc salts (orally, in drinking water, or, preferably, in slow-release intraruminal capsules), are widely administered for very effective routine prophylaxis of facial eczema.191, 199, 258, 262, 299 These salts prevent liver damage by inhibiting the generation of free radicals by sporidesmin. Apparently zinc binds to the dithiol group of reduced sporidesmin to form a stable mercaptide, incapable of autoxidation.195, 196, 197 Zinc also inhibits intestinal absorption of copper (a catalist for autoxidation of the dithiol) thereby further constraining free radical production.195, 197 Since workers in New Zealand have shown that tolerance to sporidesmin is highly heritable in sheep39, 40, 188 and cattle,187 a performance test for the selection of rams having facial eczema-tolerant progeny has been developed.298 Tolerant progeny had a lower than average incidence of clinical cases, a lower than average elevation in GGT and less liver damage.39, 40, 188, 298
Little is known about the control of facial eczema in South Africa.
Tribulus terrestris L. (Zygophyllaceae)
Devil’s thorn, dubbeltjie
Tribulus terrestris is responsible for geeldikkop, a hepatogenous photosensitization of sheep and goats in the karoid areas of southern Africa. Together with Panicum photosensitization (dikoor) it annually accounts for the death of c.74 000 small stock in South Africa alone. Geeldikkop is generally regarded as the most important plant poisoning of small stock on the subcontinent.133 The disease has also been reported in Australia,92, 93, 121 where it is of only minor consequence.
Geeldikkop and dikoor (vide infra) belong to a worldwide group of plant-induced hepatogenous photosensitizations characterized by deposition of birefringent crystalloid material in the liver. The plants involved in this type of photosensitization include T. terrestris,129 various Panicum species, Brachiaria decumbens,97 Narthecium ossifragum,2, 179 Agave lechuguilla38, 168 and Nolina texana.169 For a better understanding of crystal-associated photosensitization we recommend that this section be read in conjunction with that on Panicum species.
Tribulus terrestris is a prostrate creeping plant with a semi-perennial underground stem and root system. Each year a mat of aerial branches emerges bearing compound leaves with five to eight pairs of hairy leaflets. The small flowers are yellow (Figure 106). Devil’s thorn, one of the popular English names for the plant, refers to the sharp, spiky excrescences on the woody fruits.303
The plant has a country-wide distribution but is extensively grazed only in the semi-arid Karoo areas (Figures 107 and 108), where it is particularly common on overgrazed or run-down veld.
Outbreaks of geeldikkop typically occur when young T. terrestris is wilted (Figure 109) during hot dry spells following summer rains.224, 274 However, on rare occasions other growth stages too might be toxic:224 e.g. Theiler (1918) induced geeldikkop with green succulent dubbeltjies in the late flowering stage before the seeds matured.288 Despite being sporadically toxic,226 dubbeltjies provide valuable, highly nutritious grazing for sheep, especially in early summer. Lambs are reputed to be more susceptible to geeldikkop than mature sheep.
The clinical signs of geeldikkop are typical of hepatogenous photosensitizations. Geeldikkop, like facial eczema, has a latent period, but in the case of geeldikkop this can be as short as two to five days315 (G.F. Bath and T.S. Kellerman, Regional Veterinary Laboratory, Allerton, Pietermaritzburg, unpublished data, 1982). The short latent periods sometimes seen in geeldikkop are now believed to arise from the deposition of biliary-occluding microliths early on (vide infra) in the intoxication.52, 129
The liver is usually khaki to yellowish-brown in colour and normal in size or only slightly enlarged. The lobulation is often accentuated and the organ may have a mottled appearance, as in facial eczema. Apart from a mild oedema about the hilus of the liver, the larger bile ducts (extra- and intrahepatic bile ducts, ductus cysticus) are as a rule normal or only slightly thickened and still partially translucent. A chalky-white sediment composed of needle-point to pinhead-sized particles is present at numerous locations in these ducts (Figure 110). On cut sections this sediment oozes with the bile from the large bile ducts. The fine, chalky-white particles are sometimes suspended in the bile or deposited on the mucosal surface of the gall bladder.
Two to three weeks after the acute signs of photosensitivity, small pits or clefts may be visible on the liver surface, while the kidneys are swollen, greenish-yellow in colour, with pin-point darker green spots scattered throughout the cortex (Figure 111). It is important to note that the morphology of the liver is never distorted as it is in the case of facial eczema.
The most conspicuous histopathological lesions of geeldikkop in the livers of the experimental animals were the accumulation of crystalloid material in the portal, as well as in the larger intra- and extrahepatic bile ducts, and in the ductus cysticus (Figures 112 to 115). The lumina of some of these ducts, especially those of the larger bile ducts and ductus cysticus, were often partially or almost entirely occluded with crystalloid material. A mild to moderate periductal lamellar fibrosis was associated with these occlusions, and the ducts appeared to be somewhat dilated. At sites where crystalloid material had accumulated, the lining epithelium revealed degenerative and necrotic changes or was atrophic. The morphology of the bile ducts and ductules in the portal triads was often distorted by the presence of the material and by uneven proliferation of epithelium.52 Although crystalloid material was generally more abundant in the lumen of the bile ducts, it could also be found in bile duct epithelium, around bile ducts in the portal triads, in and between hepatocytes and Kupffer cells, as well as in bile canaliculi, spaces of Disse and sinusoids. Crystalloid material has also been demonstrated in the mucosa of the gall bladder, as well as in the lumen and epithelium of renal tubules. In addition to the changes in the biliary system there were often diffuse hepatocellular swelling (cloudy swelling and hydropic degeneration), necrosis of individual or small groups of hepatocytes, Kupffer cell proliferation (the abundant cytoplasm of many have a foamy appearance and contain lipofuscin pigments) and bile stasis. Apart from the occasional presence of crystalloid material in the kidneys, there was usually evidence of tubular dilatation, regeneration and bile pigmentation of the epithelium and, in chronic cases, small foci of interstitial fibrosis.
Studies by scanning electron microscope revealed that the amount of crystalloid material in the extrahepatic bile ducts and ductus cysticus varied at different locations along their lengths and also between animals. While the lumina in some segments could be obliterated almost completely by crystalloid material (Figure 116), at other points along the same ducts they might be sparsely distributed or even absent. The morphology of the microliths varied considerably, but they were mostly composed of plate-like structures (Figure 117).52
The absence of ulcerative lesions in the gall bladder and urinary bladder, the presence of a nephrosis, and the hepatosis in geeldikkop have been described in detail elsewhere.129, 288, 315
Owing to its economic importance, geeldikkop is one of the most persistently researched plant poisonings of South Africa. The ability of T. terrestris to become sporadically toxic under certain weather conditions led to speculation that the wilted plant could sometimes produce a hepatotoxin.21, 224, 288, 315 Another of the theories put forward was that during outbreaks, T. terrestris was contaminated by hepatotoxic fungal spores.32, 129, 315 The presence of such spores on T. terrestris, it was argued, would at once explain the sporadic nature of the outbreaks, the difficulty encountered in reproducing geeldikkop with T. terrestris, and the occurrence of an identical disease (dikoor) on Panicum grass pastures (vide infra) where T. terrestris was absent.
However, a wide-ranging mycotoxicological survey of pastures during outbreaks of geeldikkop/dikoor to identify this hypothetical toxic fungus, did not provide evidence that the condition was a mycotoxicosis.33, 96, 129 The only fungus capable of causing hepatogenous photosensitivity to be isolated, Pithomyces chartarum129, was clearly not the primary cause of geeldikkop.
Since no evidence for geeldikkop being a mycotoxicosis could be found, the hepatotoxicity of T. terrestris itself was again addressed.
Geeldikkop has been experimentally induced by feeding T. terrestris224, 225, 288, 315 and by dosing crude steroidal saponins from the plant to sheep.130 Earlier experiments had provided some evidence that sporidesmin was a predisposing factor for the disease129 (vide infra). Nevertheless, since sporidesmin would not have survived the extraction procedure for the saponins, these trials130 clearly showed that T. terrestris alone can cause geeldikkop.
The potential importance of the saponins42 of T. terrestris was first recognized by Henrici (1952),106 who suggested that they, acting in combination with other factors, might be involved in the aetiology of geeldikkop. Enslin and Wells (1956)79 isolated crude saponins in yields of 0,5–2,0% of dry mass of the plant. Later, De Kock & Enslin (1958)64 demonstrated diosgenin, ruscogenin, gitogenin and 25R-spirosta-3:5-diene in extracts of the plant – they also isolated a saponin which years later was characterized by Wilkins et al. (1996).326 However, when 20 g of crude T. terrestris saponins failed to induce geeldikkop in a sheep, interest in these compounds waned. The latest investigation into the role of T. terrestris saponins in geeldikkop130 was prompted by a report from Scandinavia that the crystal-associated ovine hepatogenous photosensitization ‘alveld’, caused by Narthecium ossifragum, could be reproduced by dosing crude saponins from the plant to sheep.2
In geeldikkop, phylloerythrin is believed by some workers to be retained as a result of occlusion of bile ducts by birefringent crystalloid material.52, 129 This hypothesis is based on histopathological evidence that bile ducts are often seen to be occluded by the crystalloid material and that the lesions in the portal tracts are consistent with those of biliary occlusive disease. For instance, lamellar periductal fibrosis is a feature both of geeldikkop and the livers of sheep subjected to ligation of the common bile duct.52, 132 Some doubts have none the less been expressed about the biliary-occlusive role of crystalloid material in the pathogenesis of crystal-associated ovine photosensitizations, among others because microliths are not invariably evident130, 132 (see also Panicum spp.). The biliary ‘crystals’ of a sheep with geeldikkop induced by oral administration of crude saponins from T. terrestris, were composed of a 6:1 mixture of the calcium salts of the ß-D-glucuronides of the steroidal sapogenins epismilagenin and episarsasapogenin.180, 326 Miles et al. (1994)181 suggested the general metabolic pathway by which diosgenin and yamogenin glycosides are converted into the glucuronides of epismilagenin and episarsasapogenin as hydrolysis of the sugars from the plant saponin; reduction of the double bond at C-5; epimerization of the hydroxyl group at C-3 (3ß-OH to 3α-OH); and conjugation with glucuronic acid181 (Figure 118). All these changes occur in the rumen except for conjugation of the spirostanols, which presumably takes place in the liver. The resulting 5ß-spirostan-3α-ol ß-D-glucuronides may precipitate as their insoluble calcium salts anywhere in the biliary tree.181
According to our current understanding, only saponins derived from 5ß-spirostanols (diosgenin, epidiosgenin, yamogenin, epiyamogenin, smilagenin, epismilagenin, sarsasapogenin, episarsasapogenin) – all of which can be metabolized by sheep to give epismilagenin or episarsasapogenin ß-D-glucuronides – have lithogenic properties. Furthermore, 25R-spirostanols (e.g. smilagenin) are believed to be considerably more lithogenic than their 25S-isomers (e.g. sarsasapogenin).181
5α-spirostanols (e.g. tigogenin and neotigogenin) and 5α-dihydroxyspirostanes (e.g. gitogenin and neogitogenin), on the other hand, are regarded as being nonlithogenic.181
In an attempt to clarify the role of steroidal saponins in the pathogenesis of geeldikkop, a significant amount of a pure diosgenin-derived saponin from T. terrestris was dosed per stomach tube to a sheep. A lamb of 18,7 kg live mass was given 11 g/kg of the diosgenin saponin in four days, administered at the rate of 2 g/kgx2 (Days 0–1), 3g/kgx1 (Day 2) and 4 g/kgx1 (Day 3). The lamb in question neither became photosensitive, nor was crystalloid material deposited in its liver. Had photosensitivity set in without microliths being formed or, alternatively, had microliths formed in the absence of photosensitivity, this would have indicated that occlusion of bile ducts by crystalloid material was not responsible for the retention of phylloerythrin. Although this dosing trial failed to throw light on the pathogenesis of geeldikkop, it did underscore our lack of knowledge on this aspect of the disease. The lack of microliths in the liver was, nevertheless, unexpected as the crystalloid material (5ß-spirostan-3α-ol ß-D-glucuronides) is derived from steroidal saponins in the plant.
Questions such as the sporadic toxicity of T. terrestris remain unanswered. We also do not understand why extraordinarily high doses of crude saponins are required to induce geeldikkop130 and why Narthecium ossifragum poisoning (alveld) is difficult to reproduce with crude saponins from the plant.86 Some experimental evidence has been submitted that sporidesmin may be a predisposing factor for geeldikkop or act as a triggering agent for the disease. When small, supposedly subtoxic amounts of Pithomyces chartarum cultures were dosed to sheep in the Karoo, more sheep grazing on wilted T. terrestris plus sporidesmin became photosensitive than those grazing on T. terrestris alone.129 Although not directly involved in the pathogenesis of crystal-associated photosensitizations,28, 30, 67, 129, 130 some indications have been found that sporidesmin exacerbates ovine Panicum dichotomiflorum photosensitization in New Zealand176 (P.H. Mortimer, Parker RD 1, Huntly, NZ., unpublished observations, 1987). Mycotoxins have been also suspected of being involved in the induction of alveld in Scandinavia1, 67 but experimental evidence for this could not be found.87, 88
Panicum spp. (Poaceae)
P. coloratum
Small buffalo grass, kleinbuffelsgras
P. maximum Jacq.
Common buffalo grass, gewone buffelsgras
Outbreaks of photosensitivity sporadically occur in sheep grazing Panicum species (notably on P. coloratum) in summer 129, 164, 234, 265 in South Africa. The grasses grow profusely on the Highveld of the Free State, Gauteng, Mpumalanga and KwaZulu-Natal, usually where the soil has been disturbed by cultivation (Figures 119 and 120). The clinical signs and lesions of dikoor are indistinguishable from those of geeldikkop (Figures 121 and 122)133 and, as is the case in T. terrestris, Panicum grass periodically becomes toxic under certain specific conditions, e.g. when wilted during hot dry spells following summer rains.265 Although the remarkable similarity between geeldikkop and dikoor is well documented,224, 226, 228, 265 dikoor is generally regarded as being a milder disease.224, 315 More recent investigations, in which neither the liver lesions nor the photosensitivity was milder than that of geeldikkop, however, have not substantiated this observation. If mortality in dikoor is lower, it is probably because the environment of the Highveld is more clement than that of the Karoo and/or that affected sheep are more easily noticed on small intensively farmed units. To our knowledge, authenticated outbreaks of Panicum photosensitization have not been reported in cattle (T.S. Kellerman, OVI, personal observation, 1998).
Crystal-associated photosensitization has been reported in sheep grazing on various Panicum species abroad; these include P. dichotomiflorum,108 P. miliaceum,48 (New Zealand); P. schinzii28 (Australia); and P. coloratum30 (USA). Examination of the bile of sheep photosensitized by P. dichotomiflorum108, 176, 177 and P. schinzii143, 177, 178 revealed that the crystalloid material, as in geeldikkop,180 consisted of insoluble calcium salts of epismilagenin and episarsasapogenin ß-D-glucuronides. Steroidal saponins derived from diosgenin and yamogenin have also been isolated from P. coloratum214 and P. dichotomiflorum.176, 198
Miles et al. (1991) described how the intrabiliary crystalloid material could be formed by the metabolism in the rumen and liver of dichotomin,176 a diosgenin-derived saponin from P. dichotomiflorum.198 They suggested that the ‘crystals’ resulted from hydrolysis of the sugar, reduction of the 5–6 double bond and epimerisation of the 3ß-OH to 3α-OH in the rumen, followed by conjugation with glucuronic acid in the liver. In the presence of calcium the glucuronide precipitates as its insoluble salt, forming the characteristic crystalloid deposits (Figure 122). The same process would convert yamogenin-derived saponins into episarsasapogenin ß-D-glucuronide.176
Brachiaria decumbens is another pasture grass to have been incriminated in this type of photosensitization. Graydon and his co-workers97 reported two outbreaks of typical crystal-associated hepatogenous photosensitization of sheep grazing this grass in West Java. Diosgenin and yamogenin have been demonstrated in B. decumbens327 and sapogenins derived from steroidal saponins have been identified in the rumen of sheep photosensitized by the plant.3
Indications have been found that sporidesmin exacerbates Panicum dichotomiflorum photosensitization in New Zealand176 (P.H. Mortimer, Parker RD 1, Huntly, NZ., unpublished observations, 1987). In South Africa, the mycoflora of Panicum pastures has been studied during and between outbreaks of dikoor.129 The only fungus so far isolated that is capable of causing ovine hepatogenous photosensitivity is P. chartarum. This fungus was identified in the aerospora above an Eragrostis curvula pasture adjacent to a P. coloratum field where an outbreak of dikoor had occurred,307 and was repeatedly isolated from Panicum grass during outbreaks of the disease129 (G.C.A. van der Westhuizen, Cecilia Roux and T.S. Kellerman, Plant Protection Research Institute, Pretoria, unpublished data, 1983). The possible role of P. chartarum in the aetiology of crystal-associated photosensitizations remains to be clarified (see also Geeldikkop).129, 180, 259
Discussion
A sound knowledge of the lobular architecture, blood vasculature and lymph drainage systems, metabolism and especially the pathophysiology of the liver, is essential for a good understanding of the symptomatology, chemical pathological alterations, as well as the hepatic and extrahepatic changes often associated with acute and chronic liver poisonings in livestock. Although this discussion does not allow for an in-depth review of many of these aspects, it is important that some of them should be touched upon.
Clinical signs and pathological changes indicative of either acute or chronic liver disease include icterus, signs of photosensitivity, widespread subcutaneous, serosal and visceral haemorrhages, alteration in the size, colour, consistency and morphology of the liver, and oedema and haemorrhages in the gall bladder wall. Diarrhoea (which may be tarry, bloody or coffee-brown in colour), tenesmus and prolapse of the rectum, ascites and oedema of the mesentery and gastrointestinal wall, and signs of central nervous system involvement are associated with insufficiency of the liver as a result of hepatic fibrosis or cirrhosis. The type of the phyto- or mycotoxin, the level and duration of exposure to the toxin, the target of the toxin within the liver (e.g. whether directed at the hepatocytes, biliary system, vasculature or stroma), the induction or inhibition of the mixed function oxidases in the liver96 and the stage at which the development or recovery of the lesions of the liver is examined, will determine the nature of the hepatic lesions. It is imperative, however, to realize that the liver, like many other organs or tissues, can only respond to injury in a limited number of ways, making a specific diagnosis based on hepatic lesions alone often impossible. Further evidence, such as the presence of the toxic plant or fungus and proof that it had been eaten, is then needed to clinch a diagnosis.
Hepatotoxins can induce either acute or chronic disease in livestock. While acute disease generally follows a large single exposure to the toxin, chronic disease in most instances is present after multiple smaller doses of the noxious agent. Poisonings that run a short course are mostly accompanied by acute changes in the liver, such as degeneration and/or necrosis of liver cells. The necrosis can be focal and haphazardly scattered throughout lobules or may have a zonal pattern, as is the case with poisonings caused by Athanasia minuta, A. trifurcata, Cestrum spp., Lasiospermum bipinnatum, Pteronia pallens and Senecio spp.
Haemorrhage and infiltration of neutrophils are frequently found in the necrotic areas. In general, the portal triads are minimally affected in livers with acute parenchymal injury. Apart from oedema, there may also be a moderate proliferation of bile ductules or cholangioles, especially at the periphery of the triads. The gall bladder wall is often oedematous, an indication of an increased lymph production or oedema of the liver. Icterus is not always notable in animals that die shortly after exposure to a hepatotoxin, or where there are still enough viable hepatocytes to take up, conjugate and excrete bilirubin. Acute hepatocellular damage in livestock is in many instances associated with widespread haemorrhages, enterorrhagia and oedema of the abomasal folds.
Most lipid soluble toxins are metabolised to more polar compounds via phase 1 and 2 enzymatic reactions. The majority of oxidation reactions are catalysed by the cytochrome P-450 mono-oxygenase (mixed function oxidase) system, located in the smooth endoplasmic reticulum of the hepatocytes. Higher cytochrome P-450 enzyme activity occurs in the centrilobular region and this zone also receives blood which is relatively deficient in oxygen and nutrients. This may explain why the centrilobular zone is particularly sensitive to damage by toxic compounds.295
Poisonings that induce photosensitivity by primarily affecting the hepatocytes can be roughly divided into three groups according to their histopathological lesions. The degenerative changes provoked by Lantana camara, for instance, are quite different from either the zonally distributed necrosis of Athanasia minuta, A. trifurcata and Lasiospermum bipinnatum poisoning or the diffuse fatty changes induced by Phomopsis leptostromiformis and sometimes by Microcystis aeruginosa. The spectra of lesions produced by the various poisonings can overlap, however, sometimes making these distinctions less obvious. Nevertheless, it is interesting to note that all the plants that produce zonally distributed hepatic lesions belong to the Asteraceae and that the fungus and cyanobacteria responsible for fatty changes both contain toxic peptides. Although much has been published on the possible pathogenesis, diagnostic significance and sequelae of these lesions, many questions regarding them remain unanswered.332 It would seem, however, that hepatotoxins that produce zonal necrosis seldom cause the massive type, and vice versa.138
In the recent study of ovine Athanasia trifurcata poisoning, periportal or peripheral zonal necrosis could be shifted through the midzonal area to the centrilobular zone by varying the dosing regimen.128 In A. minuta poisoning, the liver lesions were found to range from distinct zonal necrosis to diffuse degeneration and hepatocellular unrest (anisocytosis, anisonucleosis, increased mitosis, binucleation of hepatocytes), often accompanied by bile ductular proliferation and cholestasis.51, 128 Similarly, although a range of changes has been seen in the livers of sheep poisoned with L. bipinnatum, periportal coagulative necrosis and haemorrhage seem to be the most characteristic for the acute stage of the disease. In the light of these findings it would appear that, in addition to the particular effects of specific hepatotoxins on certain areas within a lobule, the level and intervals between exposures to a toxin may also be important in determining the final nature, distribution and extent of the lesions in the liver. Extreme care should be taken not to overestimate the diagnostic significance of certain patterns of necrosis in the liver of animals.51
Apart from the occluding mechanisms operating in facial eczema and geeldikkop (the two most important photosensitizations resulting from biliary obstruction), sheep can be made photosensitive by surgical ligation of the common bile duct.52, 90, 229 The most conspicuous changes arising from ligation were mild to marked lamellar fibrosis and oedema around many bile ducts in the portal triads (Figure 123) and larger bile ducts traversing the liver. From this it is clear that obstruction of bile ducts by whatever mechanism, whether by necrosis and scarring as in facial eczema, by microliths as in geeldikkop/dikoor or by ligation of the common bile duct, leads to very similar hepatic lesions. The most important of these is concentric, lamellar fibrosis around the bile ducts, which is indicative of obstructive cholangitis. Other changes include bile ductular proliferation, oedema and fibroplasia in the portal triads, foci of periportal hepatocellular necrosis (bile infarcts) and diffuse parenchymal degeneration. In general, the severity of the biliary lesions probably depends on the degree of occlusion and whether major or minor bile ducts are affected.52
The degree of portal reaction does not always vary significantly among sheep affected with facial eczema and geeldikkop/dikoor. Despite such similarities, the two diseases are distinct entities that can be distinguished on histopathological grounds. The mechanical damage to larger bile ducts (such as pressure atrophy and/or spotty degeneration and necrosis of the epithelium) caused by microliths in geeldikkop, never progresses to the advanced stage seen in facial eczema. The severe thickening of the bile ducts so characteristic of facial eczema (where the entire walls of the major ducts may also be necrotic and be surrounded by granulation tissue) is absent. Absent, too, are the thickening of blood vessel walls in juxtaposition to affected bile ducts and the urinary and gall bladder lesions sometimes seen in facial eczema. Many of these changes in facial eczema are, of course, macroscopically visible.
Although the mechanisms responsible for the retention of phylloerythrin in biliary occlusive diseases are at least partially understood, less is known about the pathogenesis of photosensitization resulting from parenchymal injury. It is not clear why, in certain primarily hepatocytic toxicoses (such as Hertia pallens, Pteronia pallens, Senecio and Cestrum poisoning), icterus is manifested without photosensitivity, while in others icterus is accompanied by retention of phylloerythrin. In these intoxications, unlike the biliary occlusive diseases, the nature of the pathological lesions does not shed much light on the manner of phylloerythrin retention. Perhaps a comparative study of the pathophysiological changes in photosensitizing and non-photosensitizing hepatic parenchymal intoxications will provide answers to some of these questions.
Apart from plants and fungi, infections such as leptospirosis260 and Rift Valley fever,50 as well as white liver disease,231 which is a cobalt deficiency, and chronic copper poisoning have been associated occasionally with photosensitivity or skin lesions very similar to those seen in chronic photodermatitis.
It is not possible to distinguish between the different hepatotoxicoses responsible for photosensitivity on the clinical signs alone. To come to a proper diagnosis it is essential to have a sound knowledge of the distribution and taxonomy of the plant or fungus, as well as the seasonal occurrence and pathology of the disease.
In the past, the acute stage of photosensitivity, i.e. swollen face, has been confused with bluetongue, Clostridium oedematiens infection, acute besnoitiosis and hypoproteinaemia as a result of internal parasites. The more chronic photodermatitis should be differentiated from the skin lesions in hairy vetch poisoning (Vicia villosa),37, 205 sweating sickness (Hyalomma truncatum toxicosis), chronic besnoitiosis125 and Sencobo disease (Dermatophilus congolensis infection).125
In contrast to acute hepatocellular injury, chronic hepatic intoxications give rise to fibrosis and cirrhosis. The transition between pre-cirrhotic lesions (such as hepatic fibrosis) and cirrhosis is not always distinct and can lead to varying interpretation in animals and humans. The term cirrhosis is often used indiscriminately in veterinary medicine and has incorrectly been coined for a number of intoxications in livestock. While in humans, many aetiological agents have been associated with cirrhosis,13 in livestock only the pyrrolizidine alkaloids and the aflatoxins are good examples of them.
Cirrhosis has been better studied and described in humans than in animals, and many of the definitions, nomenclature, and classifications used in human medicine have been applied to veterinary medicine. In human medicine, one of the most recent definitions of cirrhosis is that it ‘is a diffuse process characterized by fibrosis and the conversion of the normal liver architecture into structurally abnormal nodules’.13 Some authorities regard altered vascular relationship an equal, or even more important, feature of cirrhosis.13 In humans, more so than in farm animals, the diagnosis of cirrhosis is important because it has serious clinical and prognostic implications. It is generally accepted that cirrhosis is an irreversible state and that the liver cannot revert to its normal architecture.13
There is an intimate relationship between the lobular architecture and the haemodynamics of the liver. Conditions that affect the circulation of the organ often lead to hepatocellular damage. It is also true that injury primarily to hepatocytes can alter the architecture and consequently the circulation of the liver. This is of particular importance in hepatic fibrosis and cirrhosis, which are often associated with severe ascites. The veno-occlusive lesions in chronic pyrrolizidine alkaloid poisoning and aflatoxicosis further exaggerate the formation of ascitic fluid. The formation and drainage of ascitic fluid have been well reviewed.14 As a result of the high permeability of the normal sinusoidal wall, the protein concentration and, consequently, the colloidal osmotic pressure in the sinusoids and spaces of Disse are almost equal. However, a small increase in the intrasinusoidal hydrostatic pressure, as is often the case in hepatic fibrosis and cirrhosis, results in a marked drainage of a protein-rich fluid into the spaces of Disse. This increased production of fluid is exacerbated by a lowered plasma colloidal or osmotic pressure as a result of a reduced production of albumin in cases with chronic hepatocellular insufficiency. The perisinusoidal spaces of Disse which join the spaces of Mall and lymphatics in the portal triads are collectively known as the deep lymph drainage system of the liver. The deep system is connected to lymphatics in the Glisson’s capsule and gall bladder wall, which represents the superficial lymph drainage system. Therefore, with an increased formation of fluid in the deep lymph drainage system, there will be a spill-over into the superficial system and, if the transport capacity of the lymphatics in the Glisson’s capsule is exceeded, fluid will ooze into the abdominal cavity. In animals with marked hepatic fibrosis or cirrhosis, ascitic fluid is also supplemented from the mesentery and gastrointestinal wall. The gastrointestinal wall is often oedematous as a result of increased capillary hydrostatic pressure and reduced colloidal pressure in the abdominal capillaries.
Nervous signs and spongy changes in the brain, referred to as hepatic encephalopathy, are associated with the later stages of liver diseases. This syndrome has been closely studied in humans331 and has also been reported in dogs84, 279, 280 and large animals.45, 77, 85, 109–111, 120, 125, 290 The pathogenesis of the central nervous system lesions and clinical signs are not clear, but seem to involve the accumulation of toxic substances (ammonia, short-chain fatty acids, mercaptans) in the blood, brain and spinal f luid, as well as alterations in the concentrations of the central nervous system neurotransmitters (decrease in norepinephrine and an increase in serotonin) as a result of changes in the plasma amino acid ratios.218, 279, 331 Of all these substances, ammonia is considered to be the most important in hepatic encephalopathy. Normally, ammonia is formed mainly from the break-down of protein in the gastrointestinal tract. It is absorbed and carried to the liver via the portal vein where it is converted to urea, and is then excreted via the kidneys. With hepatic insufficiency the ammonia concentration in the circulation increases rapidly.
Nervous signs in stock suffering from hepatic encephalopathy may be severe but are often subtle, nonspecific or absent. Of all the livestock species chronically affected by the pyrrolizidine alkaloids, the horse seems to show the most regular and severe nervous signs.105, 269, 286, 287 Cattle may sometimes exhibit signs, while sheep, notwithstanding marked spongy changes in the brain, almost never manifest overt nervous signs (C.P. Harte and J.A.W. Coetzer, Private Practitioner, Queenstown, unpublished observations, 1985). Clinical signs that have been associated with hepatic encephalopathy in stock include behavioural changes, stupor, ataxia, dysmetria, tremors and coma.85, 218, 286, 287 Yawning in horses and bellowing and tenesmus in cattle are also thought to be part of the syndrome.45, 77, 218 The spongy changes (status spongiosus) of the white matter in the brain and spinal cord of animals that suffer from hepatic encephalopathy are characterized by a meshwork of big, empty spaces which are particularly pronounced in the midbrain, brain stem, cerebellar peduncles and at the junction of the white and grey matter (Figure 124). Ultrastructural studies reveal vacuolation and separation of the myelin spiral at the intraperiod lamellae.45
Coagulopathies, characterized by widespread subcutaneous, serosal and visceral haemorrhages and enterorrhagia are often associated with acute and chronic toxic liver disease in livestock. While the pathogenesis of these bleeding problems in stock has not been properly investigated, similar haemostatic abnormalities in humans with liver damage have been attributed to sequestration of platelets in the spleen and splanchnic vascular bed, decreased synthesis of clotting factors and prothrombin, decreased clearance of plasminogen activators from the blood, primary fibrinolysis, disseminated intravascular coagulation and circulating anticoagulants.156 Sometimes these bleeding tendencies have been confused with similar haemorrhagic diatheses seen with Pasteurella and Salmonella septicaemias, as well as with Rift Valley fever viral infection in ruminants.
The liver has many functions and failure of one or more of them can lead to elevated liver enzyme activities in the serum and alterations in liver function tests. While certain enzymes, such as serum alanine aminotransferase and serum aspartate aminotransferase, are indicative of hepatocytic damage, an increase in serum alkaline phosphatase and γ-glutamyltransferase activity indicate impaired bile flow. Certain tests, such as the bromosulphophthalein excretion, ammonia tolerance test, albumin concentration, prothrombin time and total serum bilirubin concentration, are of value to determine the degree of liver insufficiencys.174
References
- AAS, O. & ULVUND, M.J. 1984. Do microfungi help to induce the phototoxic disease alveld in Norway? Veterinary Record, 124, 563.
- ABDELKADER, S.V., CEH, L., DISHINGTON, I.W. & HAUGE, J.G. 1984. Alveld-producing saponins. II. Toxicological studies. Acta Veterinaria Scandinavica, 25, 76–85.
- ABDULLAH, A.S., LAJIS, N.H., BREMNER, J.B., DAVIES, N.W., MUSTAPHA, W. & RIJION, M.A. 1992. Hepatotoxic constituents in the rumen of Brachiaria decumbens intoxication in sheep. Veterinary and Human Toxicology, 34, 154–155.
- ACOCKS, J.P.H. 1953. Veld types of South Africa. Botanical Survey Memoir, No. 28.
- ACOCKS, J.P.H. 1975. Veld types of South Africa. 2nd edn. Memoirs of the Botanical Survey of South Africa, No. 40.
- ADAM, S.E.I. 1974. Hepatotoxic activity of plant poisons and mycotoxins in domestic animals. Veterinary Bulletin, 44, 767–776.
- ADELAAR, T.F., TERBLANCHE, M., SMIT, J.D., NAUDÉ, T.W. & CODD, L.E. 1964. A hitherto unknown poisonous plant: Lasiospermum bipinnatum (Thunb.) Druce. Preliminary communication. Journal of the South African Veterinary Medical Association, 35, 11–16.
- ALLEN, J.G., THAN, K.A., EDGAR, J.A., DONCON, G.H., DRAGICEVIC, G. & KOSMAC, V.H. 1994. Field evaluations of vaccines against lupinosis. In: COLEGATE, S.M. & DORLING, P.R. (eds-in-chief) ALLEN, J.G., HUXTABLE, C.R., MEAD, R.J. & PANTER, K.E. (assoc. eds.) Plant-associated toxins: Agricultural, phytochemical and ecological aspects, 427–432. CAB International.
- ALLCROFT, RUTH & CARNAGHAN, R.B.A. 1963. Groundnut toxicity: An examination for toxin in human food products from animals fed toxic groundnut meal. Veterinary Record, 75, 259–263.
- ANDERSON, L.A.P., DE KOCK, W.T. & ENSLIN, P.R. 1961. The constitution of two physiologically active triterpenoids from Lippia rehmannii. Journal of the South African Chemical Institute, 14, 58–63.
- ANDERSON, W.H., NEHRING, E.W. & WICKSER, W.R. 1975. Aflatoxin contamination of corn in the field. Journal of Agriculture and Food Chemistry, 23, 775–782.
- ANONYMOUS. 1997. Control of Lantana camara. Pamphlet, Plant Protection Research Institute, Agricultural Research Council, Private Bag X9059, Pietermaritzburg, 3200, South Africa.
- ANTHONY, P.P., ISHAK. K.G., NAYAK, N.C., POULSEN, H.E., SCHEINER, P.J. & SOBIN, L.H. 1977. The morphology of cirrhosis: Definition, nomenclature, and classification. Bulletin of the World Health Organization, 55, 521–540.
- ARBEITER, G. & MEYER-BURG, J. 1974. Pathogenese des Ascites beider Leberzirrhose. Leber, Magen, Darm, 4, 299–307.
- ARMBRECHT, B.H. 1978. Aflatoxicosis in sheep. In: WYLLIE, T.D. & MOREHOUSE, L.G. (eds.) Mycotoxic fungi, mycotoxins, mycotoxicoses. An encyclopedic handbook. Vol. 2. New York: Marcel Dekker, Inc.
- ARMBRECHT, B.H. 1978. Aflatoxicosis in swine. In: WYLLIE, T.D. & MOREHOUSE, L.G. (eds.) Mycotoxic fungi, mycotoxins, mycotoxicoses. An encyclopedic handbook. Vol. 2. New York: Marcel Dekker, Inc.
- ARMBRECHT, B.H., SHALKOP, W.T., ROLLINS, L.D., POHLAND, A.E. & STOLOFF, L. 1970. Acute toxicity of aflatoxin B1 in wethers. Nature, 225, 1062–1063.
- ASHWORTH, C.T. & MASON, M.F. 1946. Observations on the pathological changes produced by a toxic substance present in blue-green algae (Microcystis aeruginosa). American Journal of Pathology, 22, 369–383.
- BARNES, A.L., CROCKER, J.G., ALLEN, J.G. & COSTA, N.D. 1996. Lupinosis of ewes round the time of mating reduces the reproductive performance of ewes. Australian Journal of Agricultural Research, 47, 1305–1324.
- BARTON, D.H.R. & DE MAYO. P. 1954. Part XV. The constitution of icterogenin, a physiologically active triterpenoid. Journal of the Chemical Society for 1954, Part 1, 887–900.
- BATH, G.F., VAN TONDER, E.M. & BASSON, P.A. 1978. Geeldikkop: Preservation of toxic material. Journal of the South African Veterinary Association, 49, 23–25.
- BLYTHE, LINDA, R., CRAIG, M. & HALL, M. 1994. Role of the liver in detoxification of poisonous plants. Veterinary and Human Toxicology, 36, 564–565.
- BOTES, D.P., KRUGER, H. & VILJOEN, C.C. 1982. Isolation and characterisation of four toxins from the blue-green alga, Microcystis aeruginosa. Toxicon, 20, 945–954.
- BOTES, D.P., VILJOEN, C.C., KRUGER, H., WESSELS, P.L. & WILLIAMS, D.H. 1982. Configuration and assignment of the amino acid residues and the presence of N-methyldehydroalanine in toxins from the blue green alga, Microcystis aeruginosa. Toxicon 20, 1037–1042.
- BOTES, D.P., VILJOEN, C.C., KRUGER, H., WESSELS, P.L. & WILLIAMS, D.H. 1982. Structure of toxins of the blue-green alga, Microcystis aeruginosa. South African Journal of Science, 78, 378–379.
- BOTES, D.P., WESSELS, P.L., KRUGER, H., RUNNEGEAR, M.T.C., SANTIKARN, S., SMITH, R.J., BARNA, J.C.J. & WILLIAMS, D.H. 1985. Structural studies on cyanoginosins -LR, -YR, -YA and -YM, peptide toxins from Microcystis aeruginosa. Journal Chemical Society Perkin Transactions, 1, 2747–2748..
- BOURKE, A.T.C. & HAWES, R.B. 1983. Freshwater cyanobacteria (blue-green algae) and human health. The Medical Journal of Australia, 1, 491–492.
- BUTTON, C., PAINTER, D.I., SHIEL, M.J., COLSON, A.R., PATERSON, P.J. & LYFORD, R.L. 1987. Crystal-associated cholangiohepatopathy and photosensitisation in lambs. Australian Veterinary Journal, 64, 176–180.
- BRASH, A.G. 1943. Lupin poisoning of sheep. New Zealand Journal of Agriculture, 67, 83–84.
- BRIDGES, C.H., CAMP, B.J., LIVINGSTON, C.W. & BAILEY, E.M. 1987. Kleingrass (Panicum coloratum L.) poisoning in sheep. Veterinary Pathology, 24, 525–531.
- BROOK, P.J. 1963. Ecology of the fungus Pithomyces chartarum (Berk. & Curt.) M.B. Ellis in pasture in relation to facial eczema disease in sheep. New Zealand Journal of Agricultural Research, 6, 147–228.
- BROWN, J.M.M. 1959. Advances in geeldikkop (Tribulosis ovis) research. I. The history of geeldikkop research. Journal of the South African Veterinary Medical Association, 30, 97–111.
- BROWN, J.M.M. 1964. Advances in geeldikkop (Tribulosis ovis) research. 6. Studies on selected aspects of the biochemistry of geeldikkop and enzootic icterus. Journal of the South African Veterinary Medical Association, 35, 507–532.
- BROWN, J.M.M. & RIMINGTON, C. 1964. Studies on biliary excretion in the rabbit. 2. The relationship between the chemical structure of certain natural or synthetic pentacyclic triterpenes and their icterogenic activity. Part 2: The substituents on carbon atoms 17, 19, 20 and 22. Proceedings of the Royal Society, Series B, 160, 246–257.
- BROWN, J.M.M., RIMINGTON, C. & SAWYER, B.C. 1963. Studies on biliary excretion in the rabbit. 2. The relationship between the chemical structure of certain natural or synthetic pentacyclic triterpenes and their icterogenic activity. Part I: The substituents on carbon atoms 3, 17, 22 and 24. Proceedings of the Royal Society, Series B, 157, 473–491.
- BULL, L.B., CULVENOR, C.C.J. & DICK, A.T. 1968. In: The pyrrolizidine alkaloids. Amsterdam: North Holland Publishing Company.
- BURROUGHS, G.W., NESER, J.A., KELLERMAN, T.S. & VAN NIEKERK, F.A. 1983. Suspected hybrid vetch (Vicia villosa crossed with Vicia dasycarpa) poisoning of cattle in the Republic of South Africa. Journal of the South African Veterinary Association, 54, 75–79.
- CAMP, B.J., BRIDGES, C.H., HILL, D.W., PATAMALAI, B. & WILSON, SHARON. 1988. Isolation of steroidal sapogenin from the bile of a sheep fed Agave lecheguilla. Veterinary and Human Toxicology, 30, 533–535.
- CAMPBELL, A.G., MEYER, H.H., HENDERSON, H.V. & WESSELINK, C. 1981. Breeding for facial eczema resistance – a progress report. Proceedings of the New Zealand Society of Animal Production, 41, 273–278.
- CAMPBELL, A.G., MORTIMER, P.H., SMITH, B.L., CLARKE, J.N. & RONALDSON, J.W. 1975. Breeding for facial eczema resistance. Proceedings of the Ruakura farmers’ conference, 27, 62–64.
- CANHAM, P.A.S. & WARREN, F.L. 1950. ‘The saponins’. Part I. Journal of the South African Chemical Institute, III, 1, 9.
- CANHAM, P.A.S. & WARREN, F.L. 1950. ‘The saponins’. Part II. Journal of the South African Chemical Institute, III, 2, 63.
- CARMICHAEL, W.W. 1992. A Review. Cyanobacteria secondary metabolites – the cyanotoxins. Journal of Applied Biology, 72, 445–459.
- CHASE, W.H. 1904. The Molteno cattle disease. Poisoning by Senecio burchellii. Agricultural Journal of the Cape of Good Hope, 25, 675–678.
- CHO, D.Y. & LEIPOLD, H.W. 1977. Experimental spongy degeneration in calves. Acta Neuropathologica (Berlin), 39, 115–127.
- CIEGLER, A. 1975. Mycotoxins: Occurrence, chemistry, biological activity. Lloydia, 38, 21–35.
- CLARE, N.T. 1952. Photosensitization in diseases of domestic animals. Review Series No. 3 of the Commonwealth Bureau of Animal Health. Farnham Royal, Bucks., England: Commonwealth Agricultural Bureau.
- CLARE, N.T. 1955. Photosensitization in animals. Advances in Veterinary Science, 2, 182–211.
- CLARK, J.D., HATCH, R.C., MILLER, DORIS M. & JAIN, A.V. 1984. Caprine aflatoxicosis: Experimental disease and clinical pathologic changes. American Journal of Veterinary Research, 45, 1132–1135.
- COETZER, J.A.W. 1982. The pathology of Rift Valley fever. II. Lesions occurring in field cases in adult cattle, calves and aborted foetuses. Onderstepoort Journal of Veterinary Research, 49, 11–17.
- COETZER, J.A.W. & BERGH, T. 1983. Photosensitivity in South Africa. IV. Pathological changes in the liver in ovine photosensitivity caused by the plant Asaemia axillaris (Thunb.) Harv. Ex Jackson. Onderstepoort Journal of Veterinary Research, 50, 53–55.
- COETZER, J.A.W., KELLERMAN, T.S., SADLER, W. & BATH, G.F. 1983. Photosensitivity in South Africa. V. A comparative study of the pathology of the ovine hepatogenous photosensitivity diseases, facial eczema and geeldikkop (Tribulosis ovis), with special reference to their pathogenesis. Onderstepoort Journal of Veterinary Research, 50, 59–71.
- CHEEKE, P.R. 1994. A review of functional and evolutionary roles of the liver in the detoxification of poisonous plants with special reference to pyrrolizidine alkaloids. Veterinary and Human Toxicology, 36, 240–347.
- CHEEKE, P.R. & HUAN, J. 1998. Species differences in the bioactivation and detoxification of pyrrolizidene alkaloids. In: GARLAND, TAM & BARR, CATHERINE A. (eds-in-chief) BETZ, J.M., REAGOR, J.C. & BAILEY, E.M. (assoc. eds.) Plants and Other Natural Toxicants, 559–563. New York: CAB International.
- CHEEKE, P.R. 1998. Natural toxicants and feeds, forages and poisonous plants. 2nd edn. Danville, Illinois: Interstate Publishers, Inc.
- COLE, R.D., STUART, B.P., LANSDEN, J.A. & COX, R.H. 1980. Isolation and redefinition of the toxic agent from Cocklebur (Xanthium strumarium). Journal of Agriculture and Food Chemistry, 28, 1330–1332.
- COLLIN, R.G. & TOWERS, N.R. 1995. Competition of a sporidesmin-producing Pithomyces chartarum strain with a non-toxigenic Pithomyces strain that does not produce sporidesmin. New Zealand Veterinary Journal, 43, 149–152.
- COLVIN, B.M., HARRISON, L.R., HARVEY, S.G. & HALL, R.F. 1984. Aflatoxicosis in feeder cattle. Journal of the American Veterinary Medical Association, 184, 956–958.
- CRAWLEY, W.E., MORTIMER, P.H. & SMITH, J. DREW. 1961. Characteristic lesions of facial eczema produced in sheep by dosing material containing Pithomyces chartarum collected from pasture. New Zealand Journal of Agricultural Research, 4, 552–559.
- CULVENOR, C.C.J. 1978. Prevention of pyrrolizidine alkaloid poisoning – animal adaptation or plant control? In: KEELER, R.F., VAN KAMPEN, K.R. & JAMES, L.F.(eds.) The effects of poisonous plants on livestock. New York, San Francisco, London: Academic Press.
- CULVENOR, C.C.J., COCKRUM, P.A., EDGAR, J.A., FRAHN, J.L., GORST-ALLMAN, C.P., JONES, A.J., MARASAS, W.F.O., MURRAY, K.E., SMITH, L.W., STEYN, P.S., VLEGGAAR, R. & WESSELS, P.L. 1983. Structure elucidation of Phomopsin A, a novel cyclic hexapeptide mycotoxin produced by Phomopsis leptostromiformis. Journal of the Chemical Society, Chemical Communications, 1983, 1259–1262.
- CULVENOR, C.C.J., BECK, A.B., CLARK, M., COCKRUM, P.A., EDGAR, J.A., FRAHN, J.L., JAGO, M.V., LANIGAN, G.W., PAYNE, A.L., PETERSON, J.E., PETTERSON, D.S., SMITH, L.W. & WHITE, R.R. 1977. Isolation of toxic metabolites of Phomopsis leptostromiformis responsible for lupinosis. Australian Journal of Biological Science, 30, 269–277.
- DE KOCK, G., DU TOIT, P.J. & STEYN, D.G. 1931. Studies on the aetiology of Dunsiekte or enzootic liver disease of equines in South Africa. 17th Report of the Director of Veterinary Services and Animal Industry, Union of South Africa, 617–644.
- DE KOCK, W.T. & ENSLIN, P.R. 1958. Chemical investigations into the photosensitivity diseases of domestic animals. Part.I. Isolation and characterisation of steroidal sapogenins from Tribulus terrestris. Journal of the South African Chemical Institute, 11, 33–36.
- DE WET, J.A.L. & ERASMUS, J.A. 1984. Suspected facial eczema in sheep in the central Orange Free State. Case Report. Journal of the South African Veterinary Association, 55, 199–200.
- DI MENNA, MARGARET E. & BAILEY, J.R. 1973. Pithomyces chartarum spore counts in pasture. New Zealand Journal of Agricultural Research, 16, 343–351.
- DI MENNA, MARGARET E., FLÅØYEN, A., & ULVUND, M.J. 1992. Fungi on Narthecium ossifragum leaves and their possible involvement in alveld disease of Norwegian lambs. Veterinary Research Communications, 16, 117–124.
- DI MENNA, MARGARET E., MORTIMER, P.H. & WHITE, E.P. 1977. The genus Pithomyces. In: WYLLIE, T.D. & MOREHOUSE, G.L. (eds.) Mycotoxic fungi, mycotoxins, mycotoxicoses. An encyclopedic handbook. Vol 1. New York: Marcel Dekker, Inc.
- DI MENNA, MARGARET E. & PARL, J.N. 1970. Moulds on perennial ryegrass and white clover. New Zealand Journal of Agricultural Research, 13, 51–68.
- DICKINSON, J.O. 1980. Pyrrolizidine alkaloids. In: Conference on mycotoxins in animal feeds and grains related to animal health. US Department of Commerce. National Technical Information Service, Food and Drug Administration, Rockville. Maryland.
- DICKINSON, J.O. & KING, R.R. 1978. The transfer of pyrrolizidine alkaloids from Senecio jacobaea into the milk of lactating cows and goats. In: KEELER, R.F., VAN KAMPEN, K.R. & JAMES, L.F. (eds.) The effects of poisonous plants on livestock. New York, San Francisco, London: Academic Press.
- DIENZER, M., THOMSON, P.A., BURGETT, D.M. & ISAACSON, D.L. 1977. Pyrrolizidine alkaloids: Their occurrence in honey from tansy ragwort (Senecio jacobaea L.). Science, 195, 497.
- DÖBEREINER, J., TOKARNIA, C.H. & CANELLA, C.F.C. 1969. Intoxicacao por Cestrum laevigatum Schlecht; a causa de mortandades em bovinos no exstado do Rio de Janeiro. Pesquisa Agropecuaria Brasileira, 4, 165–193.
- DUNNE, H.W. & LEMON, A.D. 1975. Diseases of swine. 4th edn. Ames, Iowa, USA: The Iowa State University Press.
- EATON, D.L. & GROOPMAN J.D. (eds.) 1994. The Toxicology of Aflatoxins. San Diego: Academic Press.
- EDDS, G.T. 1979. Aflatoxins. In: Conference on mycotoxins in animal feeds and grains related to animal health. US Department of Commerce, National Technical Information Service. PB-300 300. Food and Drug Administration, Rockville, Maryland, USA.
- EDWARDS, A.J., OEHME, F.W., MUELLER, R.E. & LEIPOLD, H.W. 1982. Hepatic encephalopathy in feedlot calves. Veterinary and Human Toxicology, 24, 94–97.
- ELLEMAN, T.C., FALCONER, I.R., JACKSON, A.R.B. & RUNNEGAR, M.T. 1978. Isolation, characterisation and pathology of the toxin from a Microcystis aeruginosa (= Anacystis cyanea) bloom. Australian Journal of Biological Science, 31, 209–218.
- ENSLIN, P.R. & WELLS, R.J. 1956, Chemical investigations into the photosensitivity diseases of domestic animals. South African Industrial Chemist, 10, 96–97.
- ERASMUS, D.J. 1990. The lantana complex in Natal. Bulletin of the Plant Protection Research Institute, pp. 4, P.Bag X134, Pretoria.
- FAIR, A.E., TUSTIN, R.C. & ADELAAR, T.F. 1970. Case report. Poisoning of cattle by ganskweek (Lasiospermum bipinnatum) (Thunb.) Druce. Journal of the South African Veterinary Medical Association, 41, 231–232.
- FALCONER, I.R., BEREFORD, A.M. & RUNNEGAR, M.T. 1983. Evidence of liver damage by toxin from a bloom of the blue-green alga, Microcystis aeruginosa. The Medical Journal of Australia, 1, 511–514.
- FALCONER, I.R., JACKSON, A.R.B., LANGLEY, J. & RUNNEGAR, M.T. 1981. Liver pathology in mice in poisoning by the blue-green alga, Microcystis aeruginosa. Australian Journal of Biology and Science, 34, 179–187.
- FELDMAN, E.C. 1978. Hepatic encephalopathy in a dog. Modern Veterinary Practice, April, 257–261.
- FINN, J.P. & TENNANT, B. 1974. Hepatic encephalopathy in cattle. Cornell Veterinarian, 64, 136–153.
- FLÅØYEN, A., HJORTH TØNNSEN, H., GRØNSTØL, H. & KARLSEN, J. 1991. Failure to induce toxicity in lambs by administering saponins from Narthecium ossifragum. Veterinary Research Communications, 15, 483–487.
- FLÅØYEN, A., DI MENNA, M.E., COLLIN, R.G. & SMITH, B.L. 1993. Cladosporium magnusianum (JAAP) M.B. Ellis is probably not involved in alveld. Veterinary Research Communications, 17, 241–245.
- FLÅØYEN, A., SMITH, B.L. & MILES, C.O. 1993 Attempt to reproduce crystal-associated cholangitis in lambs by the experimental dosing of sarsasapogenin or diosgenin alone and in combination with sporidesmin. New Zealand Veterinary Journal, 41, 171–174.
- FOURIE, N., VAN DER LUGT, J.J., NEWSHOLME, S.J. and NEL, P.W. 1987. Acute Lantana camara toxicity in cattle. Journal of the South African Veterinary Association, 58, 173–178.
- FORD, E.J.H. & GOPINATH, C. 1976. The excretion of phylloerythrin and bilirubin by calves and sheep. Research in Veterinary Science, 21, 12–18.
- GARDINER, M.R. 1967. Lupinosis. Advances in Veterinary Science, 11, 85–138.
- GLASTONBURY, J.R.W., DOUGHTY, F.R., WHITAKER, S.J. & SERGEANT, E. 1984. A syndrome of hepatogenous photosensitisation, resembling geeldikkop, in sheep grazing Tribulus terrestris. Australian Veterinary Journal, 61, 314–316.
- GLASTONBURY, J.R.W. & BOAL, G.K. 1985. Geeldikkop in goats. Australian Veterinary Journal, 62, 62–63.
- GOPINATH, C. & FORD, E.J.H. 1969. The effect of Lantana camara on the liver of sheep. Journal of Pathology, 99, 75–85.
- GORHAM, P.R. 1964. Toxic algae. In: JACKSON, D.F. (ed.) Algae and Man. New York: Plenum Press.
- GOUWS, L. 1965. Toxigenic Dematiaceae. In: Symposium on mycotoxins in foodstuffs. Publications S 15 of the CSIR, Pretoria.
- GRAYDON, R.J., HAMID, H. & GARDINER, C. 1991. Photosensitisation and crystal-associated cholangiohepatopathy in sheep grazing Brachiaria decumbens. Australian Veterinary Journal, 68, 234–236.
- GROENEWALD, J.W., SMIT, J.D. & ADELAAR, T.F. 1954. Methionine deficiency, a possible cause of liver injury in sheep. Journal of the South African Veterinary Medical Association, 25, 29–33.
- GULICH, B.A., LIU, I.K.M., QUALLS, S.W., GRIBBLE, D.H. & ROGERS, Q.R. 1980. Effect of pyrrolizidine alkaloid-induced hepatic disease in plasma amino acid patterns in the horse. American Journal of Veterinary Research, 41, 1894–1898.
- HARDING, W.R., ROWE, N., WESSELS, J.C., BEATTIE, K.A. & CODD, G.A. 1995. Death of a dog attributed to the cyanobacterial (blue-green algal) hepatotoxin nodularin in South Africa. Journal of the South African Veterinary Association, 66, 256–259.
- HARRIS, P. 1970. Development of hepatic tumors in rats following ingestion of Senecio longilobus. Cancer Research, 30, 2881.
- HARWIG, J. & MUNRO, I.C. 1975. Mycotoxins of possible importance in diseases of Canadian farm animals. Canadian Veterinary Journal, 16, 125–138.
- HEANY, S.I. 1971. The toxicity of Microcystis aeruginosa Kutz from English reservoirs. Water Treatment and Examination, 20, 235–244.
- HENDERSON, MAYDA, & ANDERSON, J.G. 1966. Algemene onkruide in Suid-Afrika/Common weeds in South Africa. Memoirs of the Botanical Survey of South Africa. 37, Department of Agricultural Technical Services. South Africa.
- HENNING, M.W. 1932. Animal diseases in South Africa. Vol. II. Virus and deficiency diseases, plant poisons. South Africa: Central News Agency Limited.
- HENRICI, M. 1952. Comparative study of the content of starch and sugars of Tribulus terrestris, lucerne, some Graminae and Pentzia incanum under different meteorological, edaphic and physiological conditions. 2. Carbohydrate nutrition. Onderstepoort Journal of Veterinary Research, 25, 45–92.
- HOFFMAN, J.R.H. 1976. Removal of Microcystis toxin in water purification processes. Water SA, 2, 58–61.
- HOLLAND, P.T., MILES, C.O. MORTIMER, P.H., WILKINS, A.L., HAWKES, A.D. & SMITH, B.L. 1991. Isolation of the steroidal sapogenin epismilagenin from the bile of sheep affected by Panicum dichotomiflorum toxicosis. Journal of Agricultural Food Chemistry, 1963–1965.
- HOOPER, P.T. 1975. Spongy degeneration in the central nervous system of domestic animals. Part I. Morphology. Acta Neuropathologica (Berlin), 31, 325–334.
- HOOPER, P.T. 1975. Spongy degeneration in the central nervous system of domestic animals. Part II. Chemical analysis and vascular permeability studies. Acta Neuropathologica (Berlin), 31, 335–341.
- HOOPER, P.T. 1978. Pyrrolizidine alkaloid poisoning-pathology with particular reference to differences in animal and plant species. In: KEELER, R.F., VAN KAMPEN, K.R. & JAMES, L.F. (eds.) The effects of poisonous plants on livestock. New York, San Francisco, London: Academic Press.
- HORE, D.E. 1960. Facial eczema. Australian Veterinary Journal, 36, 172–176.
- HORWOOD, D. 1988. Lupinosis: research evens the score. Rural Research, Summer 1987/88, CSIRO, Australia, 16–21.
- HRDLICKA, J.S.L. & SEAWRIGHT, A.A. 1979. The effect of size and timing of a pretreat dose of phenobarbitone on the liver lesion caused by ngaione in the mouse. Journal of Pathology, 127, 121–127.
- HUGHES, E.O., GORHAM, P.R. & ZEHNDER, A. 1958. Toxicity of a unialgal culture of Microcystis aeruginosa. Canadian Journal of Microbiology, 4, 225–236.
- HUGHES, M.R., McCAIN, T.A., CHANG, S.Y. & HAUSSLER, M.R. 1977. Presence of 1,25–dihydroxyvitamin D3–glycoside in the calcinogenic plant Cestrum diurnum. Nature, 268, 347–349.
- HURWITZ, W. 1980. Official methods of analysis of the Association of Official Analytical Chemists. 13th Edn. of the Association of Official Analytical Chemists, Washington, D.C.
- HUXTABLE, R., STILLMAN, A. & CIARAMITARA, D. 1977. Characterization of alkaloids involved in human Senecio (pyrrolizidine) poisoning. Proceedings of the Western Pharmacological Society, 20, 455.
- IDE, A. & TUTT, L.A. 1998. Acute Lantana camara poisoning in a Boer goat kid. Journal of the South African Veterinary Association, 69, 30–32.
- ISHMAEL, J., GOPINATH, C. & HOWELL, J. McC. 1971. Experimental chronic copper toxicity in sheep. Histological and histochemical changes during the development of the lesions in the liver. Research in Veterinary Science, 12, 358–366.
- JACOB, R.H. & PEET, R.L. 1987. Poisoning of sheep and goats with Tribulus terrestris (caltrop). Australian Veterinary Journal, 64, 288–289.
- JOHNSON, A.E. 1982. Failure of mineral-vitamin supplements to prevent tansy ragwort (Senecio jacobaea) toxicosis in cattle. American Journal of Veterinary Research, 43, 718–723.
- JOHNSON, A.E. & MOLYNEUX, R.L. 1985. Variation in toxic pyrrolizidine alkaloid content of plants, associated with site, stage of growth and environmental conditions. In: SEAWRIGHT, A.A., HEGARTY, M.P., JAMES, L.F. & KEELER, R.F. (eds.) Plant toxicology. Proceedings of the Australia-USA Poisonous Plant Symposium, Brisbane, Australia. Queensland Department of Primary Industries, Animal Research Institute, Yeerongpilly, Australia.
- JONES, T.C. & HUNT, R.D. 1983. Veterinary Pathology. 5th edn. Philadelphia: Lea & Febiger.
- JUBB, K.V.F. & KENNEDY. P.C. 1970. Pathology of domestic animals. 2nd edn. Vol 2. New York and London: Academic Press.
- KELLERMAN, T.S. 1985. Mycotoxicoses of livestock in South Africa. Seminar given at 6th International Symposium on Mycotoxins and Phycotoxins, CSIR. Pretoria, Republic of South Africa.
- KELLERMAN, T.S., BASSON, P.A., NAUDÉ, T.W., VAN RENSBURG, I.B.R. & WELMAN, WILHEMINA G. 1973. Photosensitivity in South Africa. I. A comparative study of Asaemia axillaris (Thunb.) Harv. ex Jackson and Lasiospermum bipinnatum (Thunb.) Druce poisoning in sheep. Onderstepoort Journal of Veterinary Research, 40, 115–126.
- KELLERMAN, T.S., COETZER, J.A.W., SCHNEIDER, D.J. & WELMAN, WILHELMINA G. 1983. Photosensitivity in South Africa. III. Ovine hepatogenous photosensitivity caused by the plant Athanasia trifurcata L. (Asteraceae). Onderstepoort Journal of Veterinary Research, 50, 47–52.
- KELLERMAN, T.S., VAN DER WESTHUIZEN, G.C.A., COETZER, J.A.W., ROUX, CECILIA, MARASAS, W.F.O., MINNE, J.A., BATH, G.F. & BASSON, P.A. 1980. Photosensitivity in South Africa. II. The experimental production of the ovine hepatogenous photosensitivity disease geeldikkop (Tribulosis ovis) by the simultaneous ingestion of Tribulus terrestris plants and cultures of Pithomyces chartarum containing the mycotoxin sporidesmin. Onderstepoort Journal of Veterinary Research, 47, 231–261.
- KELLERMAN, T.S., ERASMUS, G.L., COETZER, J.A.W., BROWN, J.M.M. & MAARTENS, B.P. 1991. Photosensitivity in South Africa. VI. Experimental induction of geeldikkop in sheep with crude steroidal saponins from Tribulus terrestris Onderstepoort Journal of Veterinary Research, 58, 47–53.
- KELLERMAN, T.S., COETZER, J.A.W. & NAUDÉ, T.W. 1992. Plant poisonings and mycotoxicoses of livestock in southern Africa. In: JAMES, L.F., KEELER, R.F., BAILEY, E.M., CHEEKE, P.R. & MEGARTY, M.P. 1992. Poisonous Plants. Proceedings of the Third International Symposium, 43–54. Ames, Iowa: Iowa State University Press.
- KELLERMAN, T.S., MILES, C.O., ERASMUS, G.L., WILKINS, A.L. & COETZER, J.A.W. 1994. The possible role of steroidal saponins in the pathogenesis of geeldikkop, a major hepatogenous photosensitization of small stock in South Africa. In: COLEGATE, S.M. & DORLING, P.R. (eds-in-chief) ALLEN, J.G., HUXTABLE, C.R., MEAD, R.J. & PANTER, K.E. (assoc. eds.) Plant-associated Toxins: Agricultural, Phytochemical and Ecological Aspects, 287–296: CAB International.
- KELLERMAN, T.S., NAUDÉ, T.W. & FOURIE, N. 1996. The distribution, diagnosis and estimated economic impact of plant poisonings and mycotoxicoses in South Africa. Onderstepoort Journal of Veterinary Research, 63, 65–90
- KETTERER, P.J., BLANEY, B.J., MOORE, C.J., McINNES, I.S. & COOK, P.W. 1982. Field cases of aflatoxicosis in pigs. Journal of the Australian Veterinary Association, 59, 113–117.
- KEYL, A.C. 1978. Aflatoxicosis in cattle. In: WYLLIE, T.D. & MOREHOUSE, L.G. (eds.) Mycotoxic fungi, mycotoxins, mycotoxicoses. An encyclopedic handbook. Vol. 2. New York: Marcel Dekker Inc.
- KINGSBURY, J.M. 1964. Poisonous plants of the United States and Canada. Englewood Cliffs, New Jersey: Prentice-Hall Inc.
- KIRPENKO, Y.A., SIRENKO, L.A. & KIRPENKO, N.I. 1981. Some aspects concerning remote after effects of blue-green algae toxin impact on warm-blooded animals. In: CARMICHAEL, W.W. (ed.) The water environment: algal toxins and health. New York: Plenum Press.
- KLATSKIN, G. 1975. Toxic and drug-induced hepatitis. In: SCHIFF, L. (ed.) Diseases of the liver. 4th edn. Philadelphia: Lippincott.
- KONST, H., McKERCHER, P.D., GORHAM, P.R., ROBERTSON, A. & HOWELL, J. 1965. Symptoms and pathology produced by toxic Microcystis aeruginosa NRC-1 in laboratory and domestic animals. Canadian Journal of Comparative Medicine and Veterinary Science, 29, 221–228.
- KRISHNAMACHARI, K.A.V.R., BHAT, R.V., NAGARAJAN, V. & TILAK, T.B.G. 1975. Hepatitis due to aflatoxicosis. An outbreak in Western India. Lancet, 1, 1061–1063.
- KÜHN, J. 1880. Die Schmarotzerpilze der Lupinenpflanze und die Bekämpfung der Lupinenkrankheit der Schafe. Berichte aus den Land Wirtschaftlichen Institut der Universität Halle, 2, 115–128.
- LANCASTER, M.C., JENKINS, F.P. & PHILIP, J. McL. 1961. Toxicity associated with certain samples of groundnuts. Nature, 192, 1095–1096.
- LANCASTER, M.J., VIT, I. & LYLFORD, R.L. 1991. Analysis of bile crystals from sheep grazing Panicum schinzii (sweet grass). Australian Veterinary Journal, 68, 281.
- LAVERS, D.W. 1953. Green cestrum – a plant poisonous to stock. Queensland Agricultural Journal, March, 160–161.
- LOUW, P.G.J. 1943. Lantanin, the active principle of Lantana camara L. I. Isolation and preliminary results on the determination of its constitution. Onderstepoort Journal of Veterinary Science and Animal Industry, 18, 197–202.
- LOUW, P.G.J. 1948. Lantadene A, the active principle of Lantana camara L. II. Isolation of lantadene B and oxygen functions of lantadene A and lantadene B. Onderstepoort Journal of Veterinary Science and Animal lndustry, 23, 233–238.
- LOUW, P.G.J. 1949. Lantadene A. The active principle of Lantana camara L. III. Pyrolytic distillation of lantadene A. Onderstepoort Journal of Veterinary Science and Animal Industry, 22, 321–327. See also IV. Dehydrogenation of lantadene A and lantadene B. Onderstepoort Journal of Animal Science and Animal Industry, 22, 329–334.
- LOUW, P.G.J. 1950. The active constituent of the poisonous alga, Microcystis toxica Stephens. South African Industrial Chemist, 4, 62–66.
- MACKAY, MAUREEN F, VAN DONKELAAR, A & CULVENOR, C.C.J. 1986. The X-ray structure of phomopsin A, a hexapeptide mycotoxin. Journal of the Chemical Society, Chemical Communications, 1219–1221.
- McBARRON, E.J. & VALERIE, MAY. 1966. Poisoning of sheep in New South Wales by the blue-green alga, Anacystis cyanea (Keutz.) DR and Dail. Australian Veterinary Journal, 42, 449–453.
- MACDONALD, D.W. 1980. Algal poisoning in beef cattle. Canadian Veterinary Journal, 1, 108–110.
- McKENZIE, R.A., BLANEY, B.J. & CONNOLE, M.D. 1981. Acute aflatoxicosis in calves fed peanut hay. Australian Veterinary Journal, 57, 284–286.
- McLEAN, ELIZABETH K. 1970. The toxic actions of pyrrolizidine (Senecio) alkaloids. Pharmacological Reviews, 22, 429–483.
- McSWEENEY, C.S. & PASS, M.A. 1983. The mechanism of ruminal stasis in lantana-poisoned sheep. Quarterly Journal of Experimental Physiology, 68, 301–313.
- MALHERBE, W.D., KELLERMAN, T.S., KRIEK, N.P.J. & HAUPT, W.H. 1977. Gamma-glytamyltranspeptidase activity in sheep serum: Normal values and an evaluation of its potential for detecting liver involvement in experimental lupinosis. Onderstepoort Journal of Veterinary Research, 44, 29–38.
- MANDER, V.J. 1983. Consumptive thrombohemorrhagic disorders. In: WILLIAMS, W.J., BEUTLER, E., ERSLEV, A.J. & LICHTMAN, M.A. (eds.) Hematology. 3rd edn. New York, San Fransisco. London: McGraw-Hill Book Company.
- MANN, G.E., CODIFER, L.P. (Jr.) & DOLLEAR F.G. 1967. Effect of heat on aflatoxins in oil seed meals. Journal of Agriculture and Food Chemistry, 15, 1090–1092.
- MANN, G.E., GARDNER, H.K., BOOTH, A.N. & GUMFMANN, M.R. 1971. Aflatoxin inactivation. Chemical and biological properties of ammonia and methylamine treated cotton seed meal. Journal of Agriculture and Food Chemistry, 19, 1155–1158.
- MANSKE, R.H.F. 1931. The alkaloids of Senecio species. I. The necines and necic acids from S. retrorsus and S. jacobaea. Canadian Journal of Research, 5, 651–659.
- MARAIS, J.S.C. 1944. Dicrotaline: The toxic alkaloid from Crotalaria dura (Wood and Evans) and Crotalaria globifera (E. Mey.). Onderstepoort Journal of Veterinary Science and Animal Industry, 20, 61–65.
- MARASAS, W.F.O. 1977. The genus Phomopsis. In: WYLLIE, T.D. & MOREHOUSE, L.G. (eds.) Mycotoxic fungi, mycotoxins, mycotoxicoses. An encyclopedic handbook. Vol. I. New York: Marcel Decker, Inc.
- MARASAS, W.F.O. 1978. Lupinosis in sheep. In: WYLLIE, T.D. & MOREHOUSE, L.G. (eds.) Mycotoxic fungi, mycotoxins, mycotoxicoses. An encyclopedic handbook. Vol. II. New York: Marcel Decker, Inc.
- MARASAS, W.F.O. 1986. Mycotoxicology. Introduction of the mycology, plant pathology, chemistry, toxicology, and pathology of naturally occurring mycotoxicoses in animals and man. University Park. Pennsylvania. P.A: Pennsylvania University Press.
- MARASAS, W.F.O. & KELLERMAN, T.S. 1978. Photosensitivity in cattle. In: WYLLIE, T.D. & MOREHOUSE, L.G. (ed.) Mycotoxic fungi, mycotoxins, mycotoxicoses. An encyclopedic handbook. Vol. II. New York: Marcel Decker, Inc.
- MARASAS, W.F.O. & SCHUMANN, INGRID H. 1972. The genus Pithomyces in South Africa. Bothalia, 10, 509–516.
- MARASAS, W.F.O., ADELAAR, T.F., KELLERMAN, T.S., MINNE, J.A., VAN RENSBURG, I.B.J. & BURROUGHS, G.W. 1972. First report of facial eczema in sheep in South Africa. Onderstepoort Journal of Veterinary Research, 39, 107–112.
- MASSEY, T.E., STEWART, R.K. DANIELS, J.M. & LIU, L. 1995. Biochemical and molecular aspects of mammalian susceptibility to aflatoxin B1 carcinogenicity. Proceedings of the Society for Experimental Biology and Medicine, 208, 213–227.
- MATHEWS, F.P. 1938. Lechuguilla (Agave lechuguilla) poisoning in sheep and goats. Journal of the American Veterinary Medical Association, 93, 168–175.
- MATHEWS, F.P. 1940. Poisoning in sheep and goats by sacahuiste (Nolina texana) buds and blooms. Texas Agricultural Experimental Station, College Station, Brazos County, Texas, Bulletin No. 585.
- MATTOCKS, A.R. 1968. Toxicity of pyrrolizidine alkaloids. Nature, 217, 723–728.
- MATTOCKS, A.R. 1978. Recent studies on mechanisms of cytotoxic action of pyrrolizidine alkaloids. In: KEELER, R.F., VAN KAMPEN, K.R. & JAMES, L.F. (eds.) The effects of poisonous plants on livestock. New York. San Francisco, London: Academic Press.
- MATTOCKS, A.R. 1985. Molecular basis of pyrrolizidine alkaloid toxicity – recent studies. In: SEAWRIGHT, A.A., HEGARTY, M.P., JAMES, L.F. & KEELER, R.F. (eds.) Plant toxicology. Proceedings of the Australia-USA poisonous plant symposium, Brisbane. Australia. Queensland Department of Primary Industries. Animal Research Institute, Yeerongpilly, Australia.
- MENDEZ, MARIA DEL CARMEN, ROSELAINE, M.S., DOS SANTOS, C. & RIET-CORREA, F. 1998. Intoxication by Xanthium cavanillesii in cattle and sheep in Brazil. Veterinary and Human Toxicology, 40, 144–147.
- MEYER, D.J. 1982. The liver. Part I. Biochemical tests for the evaluation of the hepatobiliary system. Continuing Education Article No. 4, 663–673.
- MEZ, K., BEATTIE, K.A., CODD, G.A., HANSELMANN, K., HAUZER, B., NAEGELI, H. & PREISIG, H.R. 1997. Identification of a microcystin in benthic cyanobacteria linked to cattle deaths on Alpine pastures in Switzerland. European Journal of Phycology, 32, 111–117.
- MILES, C.O., MUNDAY, S.C., HOLLAND, P.T., SMITH, B.L., EMBLING, P.P. & WILKINS, A.L. 1991. Identification of a sapogenin glucuronide in the bile of sheep affected by Panicum dichotomiflorum toxicosis. New Zealand Veterinary Journal, 39, 150–152.
- MILES, C.O., WILKINS, A.L., MUNDAY, S.C., HOLLAND, P.T., SMITH, B.L., LANCASTER, M.J. & EMBLING, P.P. 1992. Identification of the calcium salt of epismilagenin-D-glucuronide in the bile crystals of sheep affected by Panicum dichotomiflorum and Panicum schinzii toxicoses. Journal of Agricultural and Food Chemistry, 40, 1606–1609.
- MILES, C.O., MUNDAY, S.C., HOLLAND, P.T., LANCASTER, M.J. & WILKINS, A.L. 1992. Further analysis of bile crystals from sheep grazing Panicum schinzii (sweet grass). Australian Veterinary Journal, 69, 34.
- MILES, C.O., WILKINS, A.L., MUNDAY, S.C., FLÅØYEN, A., HOLLAND, P.T. & SMITH, B.L. 1993. Identification of insoluble salts of the ß-D-glucuronides of episarsasapogenin and epismilagenin in the bile of lambs with alveld, and examination of Narthecium ossifragum, Tribulus terrestris and Panicum miliaceum for sapogenins. Journal of Food Chemistry, 41, 914–917.
- MILES, C.O., WILKINS, A.L., ERASMUS, G.L., KELLERMAN, T.S. & COETZER, J.A.W. 1994. Photosensitization in South Africa. VII. Chemical composition of biliary crystals from sheep with experimentally-induced geeldikkop. Onderstepoort Journal of Veterinary Research, 61, 215–222.
- MILES, C.O., WILKINS, A.L. ERSAMUS, G.L. & KELLERMAN, T.S. 1994. Photosensitivity in South Africa. VIII. Ovine metabolism of Tribulus terrestris during experimentally induced geeldikkop. Onderstepoort Journal of Veterinary Research, 61, 351–359.
- MILLER, DORIS M., CROWELL, W.A. & STUART, B.P. 1982. Acute aflatoxicosis in swine: Clinical pathology, histopathology and electron microscopy. American Journal of Veterinary Research, 43, 273–277.
- MILLER, DORIS M., CLARK, J.D., HATCH, R.C. & JAIN, A.V. 1984. Caprine aflatoxicosis: Serum electrophoresis and pathologic changes. American Journal of Veterinary Research, 45, 1136–1141.
- MINNE, J.A., ADELAAR, T.F., TERBLANCHE, M. & SMIT, J.D. 1964. Groundnut poisoning due to aflatoxin in stock in South Africa. Journal of the South African Veterinary Medical Association, 35, 7–8.
- MITCHELL, K.J., WALSHE, T.O. & ROBERTSON, N.G. 1959. Weather conditions associated with outbreaks of facial eczema. New Zealand Journal of Agricultural Research, 2, 584–604.
- MOHABBAT, O. YOUNOS, M.S., MERRAO, A.A., SRIVASTAVE, R.N., GHAOS, S.G. & ARAM, C.N. 1976. An outbreak of hepatic veno-occlusive disease in North-western Afghanistan. Lancet, 2, 269–271.
- MORRIS, C.A., TOWERS, N.R., SMITH, B.L. & SOUTHEY, B.R. 1991. Progeny testing bulls for susceptibility to facial eczema. New Zealand Journal of Agricultural Research, 34, 413–417.
- MORRIS, C.A., TOWERS, N.R., WHEELER, M. & WESSELINK, C. 1995. Selection for or against facial eczema susceptibility in Romney sheep, as monitored by serum concentrations of a liver enzyme. New Zealand Journal of Agricultural Research, 38, 211–219.
- MORTIMER, P.H. 1963. The experimental intoxication of sheep with sporidesmin, a metabolic product of Pithomyces chartarum. IV. Histological examinations of orally-dosed sheep. Research in Veterinary Science, 4, 166–185.
- MORTIMER, P.H., WHITE, E.P. & DI MENNA, MARGARET E. 1978. Pithomycotoxicosis. ‘Facial eczema’ in sheep. In: WYLLIE, T.D. & MOREHOUSE, L.G. (eds.) Mycotoxic fungi, mycotoxins, mycotoxicoses. An encyclopedic handbook. Vol. II. New York: Marcel Decker, Inc.
- MORTIMER, P.H., DI MENNA, MARGARET E. & WHITE, E.P. 1978. Pithomycotoxicosis. ‘Facial eczema’ in cattle. In: WYLLIE, T.D. & MOREHOUSE, L.G. (eds.) Mycotoxic fungi, mycotoxins, mycotoxicoses. An encyclopedic handbook. Vol. II. New York: Marcel Decker, Inc.
- MORTIMER, P.H. & TAYLOR, A. 1962. The experimental intoxication of sheep with sporidesmin, a metabolic product of Pithomyces chartarum. I. Clinical observations and findings at post-mortem examination. Research in Veterinary Science, 3, 147–160.
- MUGERA, G.M. & NDERITO, P. 1968. Cestrum poisoning in Kenya livestock. Bulletin of Epizootic Diseases of Africa, 16, 501–506.
- MUIR, J. 1928. Botanical aspects of Senecio disease. Journal of the Medical Association of South Africa, No. 19, 519–522.
- MUNDAY, R. 1982. Studies on the mechanism of toxicity of the mycotoxin sporidesmin. 1. Generation of superoxide radical by sporidesmin. Chemical-Biological Interactions, 361–374.
- MUNDAY, R. 1989. Toxicity of thiols and disulphides: Involvement of free-radical species. Free Radical Biology and Medicine, 7, 659–673.
- MUNDAY, R.V. & MANNS, E. 1989. Protection by iron salts against sporidesmin intoxication in sheep. New Zealand Veterinary Journal, 37, 65–68.
- MUNDAY, S.C., WILKINS, A.L., MILES, C.O. & HOLLAND, P.T. 1993. Isolation and structure elucidation of dichotomin, a furastanol saponin implicated in hepatogenous photosensitization of sheep grazing Panicum dichotomiflorum. Journal of Agricultural and Food Chemistry, 41, 267–271.
- MUNDAY, R., THOMPSON, A.M., FOWKE, E.A., WESSELINK, C., SMITH, B.L., TOWERS, N.R., O’DONNEL, K.O., McDONALD, R.M. STERNIMANN, M. & FORD, A.J. 1997. A zinc-containing device for facial eczema control in lambs. New Zealand Veterinary Journal, 45, 93–98.
- NELSON, D.B., KIMBROUGH, R., LANDRIGAN, P.S., HAYES, A.W., YANG, G.C. & BENANIDES, J. 1980. Aflatoxin and Reye’s syndrome: A case control study. Pediatrics, 66, 865–869.
- NEWBERNE, P.M., WOGAN, G.N. & HALL, A. 1966. III. Effects of dietary modifications on response of the duckling to aflatoxin. Journal of Nutrition, 90, 123–130.
- OELRICHS, P.B., PEARCE, C.M., KUDO, K. & KELLY, W.R. 1994. The isolation, structure elucidation and toxicity of the kaurene glycosides parquin and carboxyparquin in Cestrum parqui. In: COLEGATE, S.M. & DORLING, P.R. (eds-in chief) ALLEN, J.G., HUXTABLE, C.R., MEAD, R.J. & PANTER, K.E. (assoc. eds.) Plant-associated Toxins: Agricultural, Phytochemical and Ecological Aspects, 251–256: CAB International.
- OSUNA, O., EDDS, G.T. & BLANKESPOOR, H.D. 1977. Toxic effects of aflatoxin B1 in male Holstein calves with prior infection by flukes (Fasciola hepatica). American Journal of Veterinary Research, 38, 341–349.
- OSWEILER, G.D. & TRAMPEL, D.W. 1985. Aflatoxicosis in feedlot cattle. Journal of the American Veterinary Medical Association, 187, 636–637.
- OSWEILER, G.D. 1996. The National Veterinary Medical Series for Independent Study. Toxicology. 416–420. Philadelphia, Baltimore, London: Williams & Wilkins.
- PANCIERA, R.J., JOHNSON, L. & OSBURN, B.I. 1966. A disease of cattle grazing hairy vetch (Vicia villosa Roth) pasture. Journal of the American Veterinary Medical Association, 148, 804–808.
- PARLE, J.N. & DI MENNA, MARGARET E. 1972. Fungicides and control of Pithomyces chartarum. II. Field trials. New Zealand Journal of Agricultural Research, 15, 54–63.
- PASS, M.A. & HEATH, T. 1977. Gall bladder paralysis in sheep during Lantana poisoning. Journal of Comparative Pathology, 87, 301–306.
- PASS, M.A., McSWEENEY, C.S. & REYNOLDSON, J.A. 1981. Absorption of toxins of Lantana camara L. from the digestive tract of sheep. Journal of Applied Toxicology, 1, 38–41.
- PASS, A.M., POLLIT, SANDRA, GOOSEM, MIRIAM W. & McSWEENEY, C.S. 1985. The pathogenesis of lantana poisoning. In: SEAWRIGHT, A.A., HEGARTY, M.P., JAMES, L.F. & KEELER, F.F. 1985. Proceedings of the Australia-USA Poisonous Plants Symposium, Brisbane, Australia, May 14–18, 1984. Yeerongpilly: Queensland Department of Primary Industries, Animal Research Institute.
- PASS, M.A. & STEWART, CAROLIE. 1984. Administration of activated charcoal for the treatment of lantana poisoning of sheep and cattle. Journal of Applied Toxicology, 4, 267–269.
- PASS, M.A. 1986. Current ideas on the pathophysiology and treatment of lantana poisoning of ruminants. Australian Veterinary Journal, 93, 169–171.
- PASS, M.A. 1991. Poisoning of livestock by Lantana plants. In: KEELER, R.F. & TU, A.T. (eds.) Toxicology of plant and fungal compounds. Vol 6. pp. 297–311. New York: Marcel Dekker, Inc.
- PATAMALAI, B., HEJTMANCIC, ESTELLE, BRIDGES, C.H., HILL, D.W. & CAMP, B.J. 1990. The isolation and identification of steroidal sapogenins in Kleingrass. Veterinary and Human Toxicology, 32, 314–318.
- PATTERSON, D.S.P. & ANDERSON, P.H. 1982. Recent aflatoxin feeding experiments in cattle. Veterinary Record, 110, 60.
- PATTERSON, D.S.P. & ROBERTS, B.A. 1980. Aflatoxin B1 in dairy concentrates and other animal feedstuffs. Veterinary Record, 107, 249–252.
- PAYNE, A.L., THAN, K.A., STEWART, P.L. & EDGAR, J.A. 1992. Vaccination against lupinosis. In: JAMES, L.F., KEELER, R.F., BAILEY, E.M., CHEEKE, P.R. & MEGARTY, M.P. 1992. Poisonous Plants, Proceedings of the Third International Symposium, 574–578. Ames, Iowa: Iowa State University Press.
- PEARSON, E.G. & CRAIG, A.M. 1980. The diagnosis of liver disease in equine and food animals. Modern Veterinary Practice, March, 233–237.
- PETERSON, J.E., JAGO, A.L., PAYNE, A.L. & STWART. P.L. 1987. The toxicity of phomopsin for sheep. Australian Veterinary Journal, 64, 293–298.
- PENRITH, MARY-LOUISE & VAN VOLLENHOVEN, ELIZE. 1994. Pulmonary and hepatic lesions associated with suspected ganskweek (Lasiospermum bipinnatum) poisoning of cattle. Journal of the South African Veterinary Association, 65, 122–124.
- PIER, A.C., RICHARD, J.L. & CYSEWSKI, S.J. 1980. Implications of mycotoxins in animal disease. Journal of the American Veterinary Medical Association, 176, 719–723.
- PROZESKY, L., KELLERMAN, T.S. & WELMAN, WILHELMINA G. 1986. An ovine hepatotoxicosis caused by the plant Pteronia pallens (DC.) Kuntze (Asteraceae) L.F. Onderstepoort Journal of Veterinary Research, 53, 9–12.
- PROZESKY, L., KELLERMAN, T.S., JORDAAN, P. & WELMAN, WILHELMINA G. 1986. An ovine hepatotoxicosis caused by the plant Hertia pallens (DC.) Kuntze (Asteraceae). Onderstepoort Journal of Veterinary Research, 52, 233–238.
- QUIN, J.I. 1928. Recent investigations into geeldikkop affecting sheep and goats in the Cape Province. Journal of the South African Veterinary Medical Association, 1, 43–45.
- QUIN, J.I. 1929. Further investigations into geeldikkop (Tribulosis ovis). Report on Veterinary Research, Union of South Africa, 15, 765–767.
- QUIN, J.I. 1930. Further investigations into the problem of geeldikkop (Tribulosis) in small stock. Report on Veterinary Research, Union of South Africa, 16, 413–416.
- QUIN, J.I. 1933. Studies on the photosensitization of animals in South Africa. I. The action of various fluorescent dyestuffs. Onderstepoort Journal of Veterinary Science and Animal Industry, 1, 459–468.
- QUIN, J.I. 1933. Studies on the photosensitization of animals in South Africa. V. The toxicity of Lippia rehmannii Pears. and Lippia pretoriensis Pears. Onderstepoort Journal of Veterinary Science and Animal Industry, 1, 501–504.
- QUIN, J.I. 1933. Studies on the photosensitization of animals in South Africa. VI. The effect of surgical obstruction of the normal bile flow. Onderstepoort Journal of Veterinary Science and Animal Industry, 1, 505–526.
- QUIN, J.I., RIMINGTON, C. & ROETS, G.C.S. 1935. Studies in the photosensitization of animals in South Africa. VIII. The biological formation of phylloerythrin in the digestive tracts of various domestic animals. Onderstepoort Journal of Veterinary Science and Animal Industry, 4, 461–471.
- RICHARDS, R.B. & HARRISON, M.R. 1981. White liver disease in lambs. Australian Veterinary Journal, 57, 565–568.
- RIMINGTON, C. & QUIN, J.I. 1934. Studies on the photosensitization of animals in South Africa. VII. The nature of the photosensitizing agent in geeldikkop. Onderstepoort Journal of Veterinary Science and Animal Industry, 3, 137–157.
- RIMINGTON, C. & QUIN, J.I. 1935. The isolation of an icterogenic principle from Lippia rehmannii (Pears). South African Journal of Science, 32, 142–151.
- RIMINGTON, C. & QUIN, J.I. 1937. Dikoor or geeldikkop on grassveld pastures. Journal of the South African Veterinary Medical Association, 8, 141–148.
- RIMINGTON, C., QUIN, J.I. & ROETS, G.C.S. 1937. Studies on the photosensitization of animals in South Africa. X. The icterogenic factor in geeldikkop. Isolation of active principles from Lippia rehmannii (Pears). Onderstepoort Journal of Veterinary Science and Animal Industry, 9, 225–255.
- RINEHART, K.L., HARADA, K-I., NAMIKOSHI, M., CHEN, C., HARVIS, C., MUNRO, M.H.G., BLUNT, J.W., MULLIGAN, P.E., BEASLEY, V.R., DAHLEM, A.M. & CARMICHAEL, W.W. 1988. Nodularin, microcystin and the configuration of ADDA. Journal of the American Chemical Society, 110, 8557–8558.
- ROBERTSON, W. 1906. Cirrhosis of the liver in stock in Cape Colony produced by two species of Senecio (Senecio burchellii and Senecio latifolius). Journal of Comparative Pathology and Therapeutics, 19, 97–110.
- RODRICKS, J.V. & STOLOFF, L. 1977. Aflatoxin residues from contaminated feed in edible tissues of food-producing animals. In: RODRICKS, J.V., HESSELTINE, C.W. & MEHLMAN, M.A.(eds.) Mycotoxins in human and animal health. Park Forest South, Illinois: Pathotox Publishers Inc.
- ROEBUCK, B.D., SIEGEL, W.G. & WOGAN, G.N. 1978. In vitro metabolism of aflatoxin B2 by animal and human liver. Cancer Research B., 38, 999–1002.
- ROETS, G.C.S. 1937. The distribution and possible translocation of icterogenin in Lippia rehmannii Pears. Onderstepoort Journal of Veterinary Science and Animal Industry, 9, 583–588.
- ROUX, CECILIA. 1977. ’n Studie van die voorkoms, verspreiding en morfologie van Pithomyces chartarum (Berk. & Curt.) M.B. Ellis in Suid-Afrika en sommige aspekte van sy fisiologie. M.Sc.- tesis, Randse Afrikaanse Universiteit.
- ROUX, C. & VAN WARMELO, K.T. 1997. A survey of the mycobiotica of a natural Karoo pasture. Bothalia, 27, 167–183.
- SANTIKARN, S., WILLIAMS, D.H., SMITH, R.J., HAMMOND, S.J., BOTES, D.P., TUINMAN, A., WESSELS, P.L., VILJOEN, C.C. & KRUGER, HELENE. 1983. A partial structure for the toxin BE-4 from the blue-green algae, Microcystis aeruginosa. Journal of the Chemical Society, Chemical Communications, 652–654.
- SCHNEIDER, D.J., GREEN, JENNIFER R. & COLLET, M.G. 1987. Ovine hepatogenous photosensitivity caused by the plant Nidorella foetida (Thumb.) DC. (Asteraceae). Onderstepoort Journal of Veterinary Research, 54, 53–57.
- SCHOENTAL, REGINA. 1967. Aflatoxins. Annual Review of Pharmacology, 7, 343–353.
- SCHOENTAL, REGINA. 1968. Toxicology and carcinogenic action of pyrrolizidine alkaloids. Cancer Research, 28, 2237–2246.
- SCOTT, W.E. 1974. The isolation of Microcystis. South African Journal of Science, 70, 179.
- SCOTT. W.E. 1991. Occurrence and significance of toxic cyanobacteria in South Africa. Water Science Technology, 23, 175–180.
- SEAMAN, J.T. & WALKER, K.H. 1985. Pyrrolizidine alkaloid poisoning of cattle and horses in New South Wales. In: SEAWRIGHT, A.A., HEGARTY, M.P., JAMES, L.F. & KEELER, R.F. (eds.) Plant toxicology. Proceedings of the Australia-USA poisonous plant symposium, Brisbane, Australia, May 14–18, 1984. Queensland Department of Primary Industries, Animal Research Insitute, Yeerongpilly, Australia.
- SEAWRIGHT, A.A. 1956. Electron microscopic observations of the hepatocytes of sheep in Lantana poisoning. Pathologia Veterinaria, 2, 175–196.
- SEAWRIGHT, A.A. 1963. Studies on experimental intoxication of sheep with Lantana camara. Australian Veterinary Journal, 39, 340–344.
- SEAWRIGHT, A.A. 1964. Studies on the pathology of experimental Lantana (Lantana camara L.) poisoning of sheep. Pathologia Veterinaria, 1, 504–529.
- SEAWRIGHT, A.A. & ALLEN, J.G. 1972. Pathology of the liver and kidney in Lantana poisoning of cattle. Australian Veterinary Journal, 48, 323–331.
- SEAWRIGHT, A.A. & HRDLICKA, JANE. 1977. The oral toxicity for sheep of triterpene acids isolated from Lantana camara. Australian Veterinary Journal, 53, 230–235.
- SEAWRIGHT, A.A. 1989. Animal health in Australia, Vol.2. 2nd ed., Chemical and plant poisons. Australian Government Publishing Service, Canberra.
- SHANK, R.C. 1978. Mycotoxicoses of man: Dietary and epidemiological considerations. In: WYLLIE, T.D. & MOREHOUSE, L.G.(eds.) Mycotoxic fungi, mycotoxins, mycotoxicoses. An encyclopedic handbook. Vol 3. New York: Marcel Dekker, Inc.
- SHONE, D.K. & DRUMMOND, R.B. 1965. Poisonous plants of Rhodesia. Cestrum aurantiacum Lindl. Rhodesian Agricultural Journal, 62, 44.
- SMITH, B.L., EMBLING, N.R., TOWERS, N.R., WRIGHT, D.E. & PAYNE, E. 1977. The protective effect of zinc sulphate in experimental sporidesmin poisoning of sheep. New Zealand Veterinary Journal, 25, 124–127.
- SMITH, B.L. & MILES, C.O. 1993. A role for Brachiaria decumbens in hepatogenous photosensitization of ruminants? Veterinary and Human Toxicology, 35, 256–257.
- SMITH, B.L. & O’HARA, P.J. 1978. Bovine photosensitization in New Zealand. New Zealand Veterinary Journal, 26, 2–5.
- SMITH, J. DREW, CRAWLEY, W.E. & LEES, F.T. 1962. The spore load of Pithomyces chartarum (Berk. & Curt.) M.B. Ellis on green leaves of herbage in facial eczema studies. New Zealand Journal of Agricultural Research, 5, 22–35.
- SMITH, B.L., TOWERS, N.R., MUNDAY, R., MORRIS, C.A. & COLLIN, R.G. 1998. Control of the mycotoxic hepatogenous photosensitization, facial eczema, in New Zealand. In: GARLAND, TAM & BARR, CATHERINE A. (eds-inchief) BETZ, J.M., REAGOR, J.C. & BAILEY, E.M. (assoc. eds.) Plants and Other Natural Toxicants, 469–473. New York: CAB International. Proceedings of the 5th International Symposium on Poisonous Plants, San Angelo, Texas, United States of America, May 19–23, 1997.
- STEPHENS, E.L. 1949. Microcystis toxica sp. nova: A poisonous alga from the Transvaal and Orange Free State. Transactions of the Royal Society of South Africa, 32, 105–112.
- STEWART, R.G., WATT, R.D. & ASHMORE, R.D. 1977. The effect of various antifungal agents in aflatoxin production and growth characteristics. Poultry Science, 56, 1630–1635.
- STEYN, D.G. 1928. Dikoor in sheep. Journal of the South African Veterinary Medical Association, I, 47–50.
- STEYN, D.G. 1929. Recent investigations into the toxicity of known and unknown poisonous plants in the Union of South Africa. 15th Annual Report of the Director of Veterinary Services, Union of South Africa, 777–803.
- STEYN, D.G. 1931. Recent investigations into the toxicity of known and unknown poisonous plants in the Union of South Africa. 17th Report of the Director of Veterinary Services and Animal Industry, Union of South Africa, 707–727.
- STEYN, D.G. 1933. Poisoning of human beings by weeds contained in cereals (bread poisoning). Onderstepoort Journal of Veterinary Science and Animal Industry, 1, 219–266.
- STEYN, D.G. 1934. The toxicology of plants in South Africa. Central News Agency, Limited, South Africa.
- STEYN, D.G. 1937. Recent investigations into the toxicity of known and unknown poisonous plants in the Union of South Africa. VII. Onderstepoort Journal of Veterinary Research, 9, ll-124.
- STEYN, D.G. 1944. Vergiftiging deur slyk (algae) op damme en panne. South African Medical Journal, 18, 378–379.
- STEYN, D.G. 1945. Poisoning of animals and human beings by algae. South African Journal of Science, 41, 243–244.
- STEYN, D.G. 1945. Poisoning of animals with algae (scum of waterbloom) in dams and pans. Bulletin of the Department of Agriculture and Forestry, Pretoria.
- STEYN, D.G. 1949. Vergiftiging van mens en dier. Pretoria: Van Schaik.
- STEYN, D.G. & DE KOCK, G. 1932. Crotalariosis in sheep. 18th Report of the Director of Veterinary Services and Animal Industry, Union of South Africa, 947–954.
- STEYN, D.G. & VAN DER WALT, S.J. 1941. Recent investigations into the toxicity of known and unknown poisonous plants in the Union of South Africa. XI. Onderstepoort Journal of Veterinary Science and Animal Industry, 16, 121–147.
- STEYN, D.G. & VAN DER WALT, S.J. 1945. Jaagsiekte by perde en Sunn-hennepvergiftiging by vee. Boerdery in Suid-Afrika, 20, 445–447.
- STOLOFF, L. 1980. Aflatoxin M in perspective. Journal of Food Protection, 43, 226–230.
- STROMBECK, D.R. & ROGERS, Q. 1978. Plasma amino acid concentrations in dogs with hepatic disease. Journal of the American Veterinary Medical Association, 173, 93–96.
- STROMBECK, D.R., KRUM, S. & ROGERS, Q. 1976. Coagulopathy and encephalopathy in a dog with acute hepatic necrosis. Journal of the American Veterinary Medical Association, 169, 813–816.
- SWICK, R.A. 1984. Hepatic metabolism and bioactivation of mycotoxins and plant toxins. Journal of Animal Science, 58, 1017–1028.
- SYNGE, R.L.M. & WHITE, E.P. 1959. Sporidesmin: A substance from Sporidesmium bakeri causing lesions characteristic of facial eczema. Chemistry and Industry. UK Department of Agriculture, New Zealand, Animal Research Division Publication No. 188, 1546–1547.
- TANDON, B.N., TANDON, H.D., TANDON, R.K., NARNDRANATHAN, M. & JOSHI, Y.K. 1976. An epidemic of veno-occlusive disease of liver in central India. Lancet, 2, 271–272.
- THAN, KHIN A., ALLEN, L., PAYNE, A.L. & EDGAR, A. 1992. Development of an enzyme immunoassay for phomopsin mycotoxins. In: JAMES, L.F., KEELER, R.F., BAILEY, E.M., CHEEKE, P.R. & MEGARTY, M.P. 1992. Poisonous Plants. Proceedings of the Third International Symposium, 259–263. Ames, Iowa: Iowa State University Press.
- THAN, K.A., ANDERTON, N., COCKRUM, P.A., PAYNE, A.L., STEWART, P.L. & EDGAR, J.A. 1994. Lupinosis vaccine: Positive relationship between anti-phomopsin IgG concentration and protection in Victoria field trials. In: COLEGATE, S.M. & DORLING, P.R. (eds-in-chief) ALLEN, J.G., HUXTABLE, C.R., MEAD, R.J. & PANTER, K.E. (assoc. eds.) Plant-associated Toxins: Agricultural, Phytochemical and Ecological Aspects, 433–438: CAB International.
- THEILER, A. 1918. Acute liver atrophy and parenchymatous hepatitis in horses. 5th and 6th Reports of the Director of Veterinary Research, Union of South Africa, 9–156.
- THEILER, A. 1918. Dunziekte in South African horses. 7th and 8th Reports of the Director of Veterinary Research, Union of South Africa, 107–177.
- THEILER, A. 1918. Geeldikkop in sheep (Tribulosis ovis). 7th and 8th Reports on Veterinary Research, Union of South Africa, 1–56.
- THEILER, A. 1918. Jagziekte in horses. 7th and 8th Reports of the South African Department of Agriculture and Veterinary Science, 5–108.
- THOMPSON, K.G., LAKE, D.E. & CORDES, D.O. 1979. Hepatic encephalopathy associated with chronic facial eczema. New Zealand Veterinary Journal, 27, 221–223.
- THORBURN, J.A. 1934. Chase Valley disease. Cestrum laevigatum Schlecht; its toxic effects on ruminants. Onderstepoort Journal of Veterinary Science and Animal Industry, 2, 667–677.
- THORNTON, D.J. 1977. Ganskweek (Lasiospermum bipinnatum): Poisoning in cattle. Journal of the South African Veterinary Association, 48, 210–211.
- THORNTON, R.H. & PERCIVAL, J.C. 1959. A hepatotoxin from Sporidesmium bakeri capable of producing facial eczema disease in sheep. Nature, London, 183, 63.
- THORNTON, R.H. & SINCLAIR, D.P. 1960. Some observations on the occurrence of Sporidesmium bakeri Syd. and facial eczema disease in the field. New Zealand Journal of Agricultural Research, 3, 300–313.
- TIMBRELL, J.A. 1992. Principles of Biochemical Toxicology. 2nd edn. London: Taylor & Francis.
- TOERIEN, D.F., SCOTT, W.E. & PITOUT, M.J. 1976. Mycrocystis toxins: Isolation, identification, implications. Water SA, 2, 160–162.
- TÖNSING, ELSE M., STEYN, P.S., OSBORNE, MARY & WEBER, K. 1984. Phomopsin A, the causative agent of lupinosis, interacts with microtubules in vivo and in vitro. European Journal of Cell Biology, 35, 156–164.
- TOWERS, N.R., MEYER, H.H., CAMPBELL, A.G. & SOUTHEY, C.A. 1983. Development of a performance test for the selection of rams having facial eczema tolerant progeny. Proceedings of the New Zealand Society of Animal Production, 43, 221–223.
- TOWERS, N.R. & SMITH, B.L. 1978. The protective effect of zinc sulphate in experimental sporidesmin intoxication of lactating dairy cows. New Zealand Veterinary Journal, 26, 199–202.
- TOWERS, N.R. & STRATTON, G.C. 1978. Serum gammaglutamyltransferase as a measure of sporidesmin induced liver damage in sheep. New Zealand Veterinary Journal, 26, 109–112.
- TRUTER, E. 1987. An Aid to the Identification of the Dominant and Commonly Occurring Genera of Algae Observed in some South African Impoundments. Hydrological Research Institute, Department of Water Affairs: Pretoria.
- URIAH, N., CASSIDY, T.R. & CHIPLEY, J.R. 1977. Partial characterization of the mode of action of benzoic acid on aflatoxin biosynthesis. Canadian Journal of Microbiology, 23, 1580–1584.
- VAHRMEIJER, J. 1981. Poisonous plants of southern Africa that cause stock losses. Cape Town: Tafelberg Publishers Limited.
- VAN DER LUGT, J.J., NEL, P.W. & KITCHING, J.P. 1991. The pathology of Cestrum laevigatum (Schlecht.) poisoning in cattle. Onderstepoort Journal of Veterinary Research, 58, 211–221.
- VAN DER LUGT, J.J., NEL, P.W. & KITCHING, J.P. 1992. Experimentally-induced Cestrum laevigatum (Schlecht.) poisoning in sheep. Onderstepoort Journal of Veterinary Research, 58, 211–221.
- VAN DER LUGT, J.J., SCHULTZ, ANITRA R., FOURIE, N., HON, L.J. JORDAAN, P. & LABUSCHAGNE, LEONIE. 1992. Galenia africana L. poisoning in sheep and goats: Hepatic and cardiac changes. Onderstepoort Journal of Veterinary Research, 59, 323–333.
- VAN DER MERWE, W.J.J., EICKER, A., MARASAS, W.F.O. & KELLERMAN, T.S. 1979. Aerospora of an Eragrostis curvula pasture in South Africa. Onderstepoort Journal of Veterinary Research, 46, 19–25.
- VAN DER WALT, S.J. & STEYN, D.G. 1939. Recent investigations into the toxicity of known and unknown poisonous plants in the Union of South Africa. IX. Onderstepoort Journal of Veterinary Science and Animal Industry, 12, 335–366.
- VAN DER WATT, J.J., PURCHASE, I.F.H. & TUSTIN, R.C. 1972. The chronic toxicity of retrorsine, a pyrrolizidine alkaloid, in vervet monkeys. Journal of Pathology, 107, 279–287.
- VAN HALDEREN, A., GREEN, JENNIFER R., MARASAS, W.F.O., THIEL, P.G. & STOCKENSTRÖM, SONJA. 1989. A field outbreak of chronic aflatoxicosis in dairy calves in the western Cape Province. Journal of the South African Veterinary Association, 60, 210–211.
- VAN HALDEREN, A., HARDING, W.R., WESSELS, J.C., SCHNEIDER, D.J., HEINE, E.W.P., VAN DER MERWE, J. & FOURIE, J.M. 1995. Cyanobacterial (blue-green algae) poisoning of livestock in the Western Cape of South Africa. Journal of the South African Veterinary Association, 66, 260–264.
- VAN JAARSVELD, A.B. & KNOX-DAVIES, P.S. 1974. Resistance of lupins to Phomopsis leptostromiformis. Phytophylactica, 6, 55–60.
- VAN RENSBURG, I.B.J. MARASAS, W.F.O. & KELLERMAN, T.S. 1975. Experimental Phomopsis leptostromiformis mycotoxicosis of pigs. Journal of the South African Veterinary Association, 46, 197–204.
- VAN RENSBURG, S.J. 1977. Role of epidemiology in the evaluation of mycotoxin health risks. In: RODRICKS, J.V., HESSELTINE, C.W. & MEHLMAN, M.A. (eds.) Mycotoxins in human and animal Health. Park Forest South, Ilinois: Pathotox Publishers.
- VAN TONDER, E.M., BASSON, P.A. & VAN RENSBURG, I.B.J. 1972. Geeldikkop: Experimental induction by feeding the plant Tribulus terrestris L. (Zygophyllaceae). Journal of the South African Veterinary Medical Association, 43, 363–375.
- VAN WARMELO, K.T., MARASAS, W.F.O., ADELAAR, T.F., KELLERMAN, T.S., VAN RENSBURG, I.B.J. & MINNE, J.A. 1970. Experimental evidence that lupinosis of sheep is a mycotoxicosis caused by the fungus, Phomopsis leptostromiformis (Khn) Bubak. Journal of the South African Veterinary Medical Association, 41, 235–247.
- VERNEY, F.A. 1911. Dunsickness. Journal of Comparative Pathology and Therapeutics, 24, 226–229.
- WATT, H.E. 1909. The alkaloids of Senecio latifolius. Proceedings of the Chemical Society, 25, 68.
- WATT, J.M. & BREYER-BRANDWIJK, M.G. 1962. The medicinal and poisonous plants of southern and eastern Africa. 2nd edn. Edinburgh and London: E & S. Livingstone Ltd.
- WELLS, M.J. & STIRTON, C.H. 1988. Lantana camara, ’n giftige verklaarde onkriud. Onkruid A.27/1988. Boerdery in Suid-Afrika. Division of Agricultural Information, Private Bag X144, Pretoria, South Africa.
- WHITE, E.P., MORTIMER, P.H. & DI MENNA, MARGARET E. 1978. Chemistry of sporidesmins. In: WYLLIE, T.D. & MOREHOUSE, G.L. (ed.) Mycotoxic fungi, mycotoxins, mycotoxicoses. An encyclopedic handbook. Vol. I. New York: Marcel Dekker, Inc.
- WILLIAMS, M.C. 1990. The pathology of experimental Lasiospermum bipinnatum (Thunb.) Druce (Asteraceae) poisoning in sheep. 1. Hepatic lesions. Onderstepoort Journal of Veterinary Research, 57, 249–261.
- WILLIAMS, M.C. 1990. The pathology of experimental Lasiospermum bipinnatum (Thunb.) Druce (Asteraceae) poisoning in sheep.II. Pulmonary and miscellaneous lesions. Onderstepoort Journal of Veterinary Research, 57, 263–268.
- WILLIAMSON, P.M., HIGHET, A.S., GAMS, W., SIVASITHAMPARAM, K. & COWLING, W.A. 1994. Diaporthe toxica sp. nov., the cause of lupinosis in sheep. Mycological Research, 98, 1364–1368.
- WILLMOT, F.C. & ROBERTSON, G.W. 1920. Senecio disease, or cirrhosis of the liver due to Senecio poisoning. South African Medical Record, 18, 346–348.
- WILKINS, A.L., MILES, C.O., DE KOCK, W.T., ERASMUS, G.L., BASSON, A.T. & KELLERMAN, T.S. 1996. Photosensitivity in South Africa. IX. Structure elucidation of a ß-glucosidase-treated saponin from Tribulus terrestris and the identification of saponin chemotypes of South African T. terrrestris. Onderstepoort Journal of Veterinary Research, 63, 327–334.
- WILKINS, A.L., MILES, C.O., SMITH, B.L., & MEAGHER, L.P. 1994. GC-MS analysis of sapogenins in plant and animal species associated with photosensitization of sheep. In: COLEGATE, S.M. & DORLING, P.R. (eds-in-chief) ALLEN, J.G., HUXTABLE, C.R., MEAD, R.J. & PANTER, K.E. (assoc. eds.) Plant-associated Toxins: Agricultural, Phytochemical and Ecological Aspects, 263–268: CAB International.
- WILSON, D.M., SANGSTER, L.T. & BEDELL, D.M. 1984. Recognizing the signs of porcine aflatoxicosis. Veterinary Medicine/Small Animal Clinician, 79, 974–977.
- WOGAN, G.N. 1966. 1. Chemical nature and biological effects of the aflatoxins. Bacteriological Reviews, 30, 460–470.
- WOLF, H. & JACKSON, E.W. 1963. Hepatoma in rainbow trout, descriptive and experimental epidemiology. Science, 142, 676–678.
- ZIEVE, LESLIE. 1979. Hepatic encephalopathy: Summary of present knowledge with an elaboration on recent developments. In: POPPER, H. & SCHAFFNER, F. (eds.) Progress in liver diseases. New York, San Fransisco, London: Grunne & Stratton.
- ZIMMERMAN, H.J. 1978. Hepatotoxicity. New York: Appleton Century Crofts.